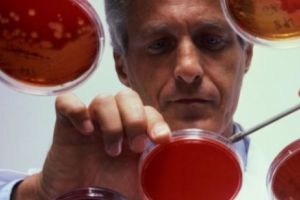
Alarmant! Top 10 viruşi care ar putea provoca următoarea epidemie

Robu despre metrou: Un primar trebuie sa fie si faptuitor si vizionar
www.tion.ro - Timiş
Primarul Nicolae Robu consideră că ideea unei linii de metrou care să lege Calea Șagului de Aeroportul Internaţional Timişoara nu e deloc hazardată, deoarece un primar trebuie să fie „făptuitor”, dar şi „vizionar”. Iar studiul de prefezabilitate în valoare de 30.000 de euro pe care Primăria Timişoara îl va comanda în acest an pentru acest proiect, ale cărui costuri ar putea ajunge la un miliard de euro, este prima condiţie pentru căutarea unei finanţări.

Grav accident de circulatie langa Buzias. O fetita de sase ani a murit, mai multe persoane ranite
www.tion.ro - Timiş
Trei persoane au fost rănite, vineri seara, în urma unui accident care a avut loc la ieşirea din Buziaş, spre Lugoj, după ce două autoturisme s-au ciocnit. O fetiţă de doar şase ani a fost preluată în stop cardio respirator şi transportată la spital, dar, din păcate, aceasta a decedat.

Cameramanii de nunti, ingrijorati: Filmatul in biserici, doar cu acordul Centrelor eparhiale
www.tion.ro - Timiş
Fotografi şi cameramani de nunţi şi botezuri din urbea de pe Bega sunt foarte îngrijoraţi de ultima hotărâre a Sfântului Sinod al Bisericii Ortodoxe Române. În şedinţa din 15 februarie s-a luat o hotărâre care interzice filmarea în biserici fără acordul Centrului eparhial.

GAL Sud-Vest Satu Mare: Anunţ prelungire apel de selecţie pe măsura M7/6B
portalsm.ro - Satu Mare
Asociaţia Grup de Acţiune Locală Sud-Vest Satu Mare (Gal Sud-Vest Satu Mare) anunţă prelungirea perioadei de depunere de proiecte pe perioada 18.12.2017 – 17.04.2018 pentru prima sesiune de depunere a cererilor de proiecte pe anul 2017 pentru măsura M7/6B – „Înfiinţarea de centre multifuncţionale sociale”. Beneficiarii eligibili pentru sprijinul acordat prin Măsura 7/6B sunt: Entităţi …

Robu ii coace ceva lui Goia: Aveti rabdare, ca orice trebuie sa se intample, se va intampla
www.tion.ro - Timiş
Războiul Robu vs. Goia va intra într-o nouă etapă până marţi, promite primarul Timişoarei, asta după ce directorul STPT l-a concediat pe Nicolae Bitea, liberalul promovat în funcţia de director adjunct al societăţii de transport pentru a-l ţine sub control pe director.

ACS Poli Timisoara a reusit sa gaseasca atacantul de careu cerut de Popa, dupa plecarea acestuia
www.tion.ro - Timiş
Antrenorul ACS Poli Timişoara Leo Grozavu a reuşit minunile la care predecesorul său Ionuţ Popa probabil nici nu visa: transferuri de jucători! Ultimii sportivi aduşi la echipă au fost prezentaţi oficiali. Este vorba despre argentinianul Maxi Oliva şi un atacant de careu, românul Mihai Roman.

Din nou emotii pentru mii de liceeni din Timis. A treia proba la BAC
www.tion.ro - Timiş
Bacalaureatul a ajuns la proba cu numărul trei. O nouă probă se desfăşoară începând de vineri, 16 februarie, timp de trei zile. Mii de liceeni din Timiş sunt înscrişi la proba de evaluare a competenţelor digitale.

Top 5 gadgeturi auto: cele mai populare cadouri pentru el
www.stiri-neamt.ro - Neamţ
Se apropie ziua de nastere ori cea de nume a partenerului tau de viata, a unui prieten, coleg sau membru al familiei? Nu stii ce cadouri pentru el sa mai a

Trei masini avariate in urma unui accident, la Sannicolau Mare
www.tion.ro - Timiş
Accident de circulaţie, vineri dimineaţă, în Sânnicolau Mare. Trei maşini au fost avariate şi o persoană a necesitat îngrijiri medicale, însă a refuzat transportul la spital.

Bărbat găsit carbonizat în propria locuinţă, la Cluj-Napoca. Și-a uitat ţigara aprinsă FOTO
www.stiridecluj.ro - Cluj
Un incendiu, soldat cu moartea unui bărbat de 70 de ani, a avut loc la o baracă improviz...

Meniul zilei vineri, 16 februarie 2018
feedproxy.google.com - Braşov
Pentru a veni în întâmpinarea celor care sunt la serviciu şi doresc să îşi comande de mâncare sau vor să iasă la masă în pauza de lucru, newsbv.ro vă prezintă mai multe oferte pentru meniul zilei. Astfel, sperăm să vă fim de ajutor şi să economisiţi timp în căutarea unui meniu care să vă satisfacă

Traviata“ si My Fair Lady“, in acest weekend, la Teatrul Oleg Danovski“
www.ziuaconstanta.ro - Constanţa
La final de saptamana, Teatrul National de Opera si Balet Oleg Danovski ii invita pe melomanii tomitani sa petreaca seri de neuitat in prezenta Violettei Valery si a Elizei Doolittle. ...

EXCLUSIV! FOTO: Eurovision-ul uneşte România în semifinala de la Sighişoara! Ce sfaturi oferă Cezar Ouatu participanţilor din acest an?
www.zi-de-zi.ro - Mureş
Nu mare mi-a fost mirarea să constat încă o dată, azi, că doar atunci când te dedici întru totul org

Ionuţ Lupescu are o mare NEMULȚUMIRE legată de Liga I. „Nu e normal asta”
evz.ro - Bucureşti
Ionuţ Lupescu, unul dintre candidaţii la şefia Federaţiei Române de Fotbal, nu este de acord cu actualul sistem de desfăşurare al Ligii I. ...

Cazul poliţistului pedofil: 18 poliţişti, din care 10 şefi, sunt cercetaţi. Eugen Stan era protejat de şeful său direct
www.ebihoreanul.ro - Bihor
Ministrul Carmen Dan a anunţat că 18 poliţişti, dintre care zece cu funcţii de conducere, sunt cercetaţi disciplinar în cazul lui Eugen Stan, agentul acuzat de agresiune sexuală a unui minor. Aceasta a confirmat şi că lui Stan colegii de la Brigada Rutieră îi spuneau 'violatorul' şi a mai spus că identificarea lui a pornit chiar din acest serviciu. Totodată, raportul corpului de control al MAI arată de ce Stan, care a mai agresat şi alţi minori, nu figura în baza de date a Poliţiei şi de ce şi-a continuat cariera de poliţist.

Firma unui MILIONAR ROMÂN, acuzată de complicatate la CRIMĂ
evz.ro - Bucureşti
A fost dat în judecată de 142 de cetăţeni pentru complicitate în încălcarea drepurilor omului....

Țara care poate schimba soarta României: Se ia DECIZIA SECOLULUI!
evz.ro - Bucureşti
Pot schimba economia României. Decizia lor poate aduce......

VESTE PROASTĂ despre contribuţia la PENSII
evz.ro - Bucureşti
Ministrul Finanţelor, nemulţumit că PFA-urile pot plăti CAS şi CASS doar la nivelul salariului minim...

„Aş dori ca Teatrul să aibă cât mai mulţi actori..”
www.desteptarea.ro - Bacău
Ivona Lucan: Povestiţi-ne puţin despre sosirea dvs. în acest Teatru. Ștefan Ionescu: Am ajuns în Bacău pe 16 august 1999, ora 05.30, cu o valiză de haine şi multe genţi de speranţe. La ora 10.00 aveam prima repetiţie! Nu ştiam la ce spectacol, dar speram la un personaj care să mă recomande pentru un debut …

Cum îl mută Lupescu pe Burleanu de la „Casa Fotbalului”?
evz.ro - Bucureşti
Fotbalul românesc are în faţă un rău mai mare şi un rău mai mic. Alegerile pentru şefia Federaţiei Române de Fotbal, programate la data de 18 aprilie, vor s...

Începutul Postului Mare
www.desteptarea.ro - Bacău
Ne aflăm cu toţii la momentul când ne pregătim să intrăm în Postul Paştelui. Deja din timpul săptămânii lăsatului sec de carne, care precede „Duminica Iertării”, două zile – miercurea şi vinerea – au fost rezervate spre o „postire” deplină: Sfânta Liturghie nu se oficiază iar întreaga rânduială şi tipicul slujbelor poartă caracteristicile liturgice ale Postului. …

Duminica I din Postul Mare
www.desteptarea.ro - Bacău
Aşa cum toate în lumea umană, animală şi vegetală au un ritm şi o logică a Creatorului, la fel putem spune că şi în sfera spirituală Biserica are grijă să ofere omului un timp de bucurie, un altul de speranţă, dar, mai ales, unul de convertire. Este cazul, prin excelenţă, timpului binecuvântat al Postului Mare. …

Se demolează Băile Baiţa din Gherla
www.stiridecluj.ro - Cluj
Se demolează Băile Baiţa din Gherla

”I-a spus şefului să se ducă dracului şi a doua zi şeful a murit. A făcut un păcat?” Horoscop
evz.ro - Bucureşti
Horoscop Respectând ritmurile vieţii poporului român, calendarul arhaic, ”Kalendarul”, nu arată vreo sărbătoare sau vreo însemnare oraculară....

Deputata Andreea Cosma, noi dezvăluiri ŞOC despre celebrul procuror, Mircea Negulescu: 'Mi-a spus să îmi iau cămaşă albastră, au vrut să-mi întindă o capcană'
ph-online.ro - Prahova
Scandalul dezvăluirilor din DNA Prahova ia amploare. Deputata PSD, Andreea Cosma, iese la rampă cu noi mărturii incendiare despre celebru fost pr...

Profil psihologic ŞOC al Laurei Codruţa Kovesi: Ce spune un celebru psiholog - 'MINTE cum respiră' / VIDEO
ph-online.ro - Prahova
Profil psihologic şoc al şefei Direcţiei Naţionale Anticorupţie (DNA) Laura Codruţa Kovesi. În direct la România TV, la emisiunea lui Victor Ciut...

BOMBĂ la Washington! Detalii PICATE ies la iveală de-abia acum. Ce NEBUNII făcea PERVERSUL TRUMP cu un MODEL PLAYBOY!
evz.ro - Bucureşti
După scandalul în urma căruia starul de filme pentru adulţi, Stormy Daniels, a declarat că a întreţinut relaţii sexuale cu actualul preşedinte al SUA...
...

Primele concluzii oficiale ale anchetei în cazul poliţistului pedofil
www.oradesibiu.ro - Sibiu
S-au făcut publice concluziile oficiale în cadrul anchetei poliţistului acuzat de pedofilie. Raportul are nu mai puţin de 22 de pagini. Ministerul de Interne a publicat concluziile anchetei…

Percheziţii în Sibiu la braconieri – Au ucis trei exemplare de urs brun
www.oradesibiu.ro - Sibiu
Trei persoane au fost reţinute în urma unor percheziţii ce au avut loc zilele trecute în judeţele Mureş şi Sibiu. Nu mai puţin de şapte percheziţii domiciliare au fost efectuate la persoane bănuite de…

Femeie salvata de vecini dupa ce fiul i-a dat foc
www.ziuaconstanta.ro - Constanţa
Un barbat din judetul Caras-Severin a fost retinut pentru 24 de ore, dupa ce, in urma unui conflict, a aruncat benzina pe mama sa si i-a dat foc. Vecinii au fost cei care au salvat-o pe femeie, ...

Ce facem în weekend?
www.desteptarea.ro - Bacău
Cu paşi repezi a mai sosit un sfârşit de săptămână. Și dacă nu aveţi în plan să mergeţi la o bulgăreală sau o săniuţă, ori să staţi acasă şi pur şi simplu să vegetaţi în faţa televizorului, avem, şi de această dată, cele mai bune oferte de petrecere a timpului liber în oraş. În primul …

Proiectarea şi execuţia noului sediu al Tribunalului Alba, scoase la licitaţie în Anul Centenarului
ziarulunirea.ro - Alba
Compania Naţională de Investiţii scoate la licitaţie în acest an proiectarea şi execuţia noului sediu al Tribunalului Alba. Execuţia noului sediul al Tribunalului Alba ar urma să fie scoasă la licitaţie de către Compania Naţională de Investiţii în cursul anului 2018. Din 2015, când s-au demarat primele demersuri de către reprezentanţii instituţiei, şi până în […]

Cadavru fără membre, „pescuit” din râul Mureş
www.zi-de-zi.ro - Mureş
Femeia din Luduş dată dispărută la începutul lunii ianuarie 2018 a fost găsită, miercuri, fără viaţă

Românii au talent 2018! Mihaela Rădulescu, ÎN LACRIMI. O sala întreagă A PLÂNS, după prestaţia acestui tânăr: „M-a durut să te aud”
evz.ro - Bucureşti
Momente emoţionante la emisiunea Românii au talent 2018, difuzată de ProTV! Un concurent a reuşit să facă o sală întreagă să plângă, după ce şi-a prezentat ...

Sfârşitul trist al unei fetiţe de nouă ani!
evz.ro - Bucureşti
Bianca Nedelcu, fetiţa de nouă ani din localitatea ieşeană Bohotin, comuna Răducăneni, care suferea de cancer renal şi ai cărei părinţi au refuzat să o mai...

Este BOMBA ANULUI în showbizul românesc! Liviu Vârciu a făcut ANUNȚUL. Mulţi fani VOR PLÂNGE
evz.ro - Bucureşti
Liviu Vârciu nu încetează să surprindă oamenii prin compotamentul său. După ce a anunţat, de mai multe ori că trăieşte o frumoasă poveste de dragoste......

Un român IMPLICAT în MEGA-SCANDALUL campaniei electorale M5S din Italia
evz.ro - Bucureşti
Bogdan Tibusche, 37 de ani, a fost denunţat la poliţie de deputata Giulia Sarti, Mişcarea 5 Stele (M5S), fosta sa logodnică, pentru că ar fi fraudat-o de 23...

Sinteza raportului in cazul politistului pedofil a fost publicata. Concluziile anchetei (document)
www.ziuaconstanta.ro - Constanţa
Ministerul de Interne a publicat in aceasta seara raportul anchetei referitoare la modul in care au intervenit politistii in cazul agentului acuzat de pedofilie. 18 comisari sefi si agenti sefi din ...

O nouă BOMBĂ în scandalul DNA! Andreea Cosma: „Negulescu şi Onea m-au pus să-l DENUNȚ pe Ghiţă”
evz.ro - Bucureşti
Deputata PSD, Andreea Cosma vine cu noi dezvăluiri incendiare în scandalul momentului de la DNA Prahova. Cosma susţine că cei doi procurori, Mircea Negulesc...

Varza rosie previne boala Alzheimer
www.ziuaconstanta.ro - Constanţa
Varza rosie se poate folosi pentru prevenirea si combaterea degenerarii celulelor din sistemul nervos central, care determina aparitia sindromului Alzheimer. Antocianii, adica pigmentii rosii din ...

Știati ca...? Celebrul baschetbalist Michael Jordan implineste astazi 55 de ani
www.ziuaconstanta.ro - Constanţa
Michael Jeffrey Jordan n. 17 februarie 1963, Brooklyn, New York, SUA a fost un jucator profesionist american de baschet, actualmente om de afaceri si proprietar majoritar la clubul de baschet Charlotte ...

Melodia Zilei: Feli Donose- Buna de iubit (Official video)
www.ziuaconstanta.ro - Constanţa
Feli Donose a lansat videoclipul piesei Buna de iubit , o declaratie de independenta a femeilor. Piesa participa la Eurovision Romania 2018. Videoclipul a strans intr-o zi de la lansare, sute de mii de ...

Poezia Zilei: Departe, dincolo de visul tau – Irina Lucia Mihalca
www.ziuaconstanta.ro - Constanţa
In miez de noapte, intunericul te-nvaluie. Prin aburii usori ce-ascund albeata lunii, soapte tandre se-aud, gandurile dorm si stelele sclipesc. In sunet pierdut de flaut, la inaltimi ...

Iata cum ar trebui sa arate noul teatru pentru copii si tineret! Propunerea consilierilor PNL Gima si Bola, neacceptata de Consiliul Judetean Constanta! (galerie foto)
www.ziuaconstanta.ro - Constanţa
Consilierii judetene PNL Stelian Gima si Bogdan Bola au propus Consiliului Judetean construirea unui teatru pentru copii, investitie estimata la 2 milioane de euro. Ei au identificat si un teren din ...

Un fost presedinte, trimis in judecata de catre DNA Constanta, merge la inchisoare
www.ziuaconstanta.ro - Constanţa
Trimis in judecata de procurorii din cadrul Directiei Nationale Anticoruptie - Serviciul Teritorial Constanta, Valeriu Gindac, la data presupuselor fapte presedinte al unei asociatii de crescatori de ...

Mai multe persoane, la un pas de libertate din pricina unei erori?
www.ziuaconstanta.ro - Constanţa
Tribunalul Constanta a luat, ieri, o prima decizie in dosarul in care procurorii din cadrul Parchetului de pe langa Curtea de Apel Constanta au dispus trimiterea in judecata a 17 persoane suspectate de ...

Licitatie la Unitatea Militara 02192 pentru reparatii in arborada navei-scoala Mircea“ (document)
www.ziuaconstanta.ro - Constanţa
Ministerul Apararii - Unitatea Militara 02192 - Academia Navala Mircea cel Batran Constanta va scoate din conturi circa 249.100 de lei pentru reparatii in arborada navei-scoala Mircea . ...

Investitorul Anahida Dogaru a primit raspuns de la APM Constanta: Vrea sa supraetajeze un hotel de opt etaje de pe bulevardul Mamaia
www.ziuaconstanta.ro - Constanţa
Investitorul Anahida Dogaru intentioneaza sa supraetajeze imobilul de opt etaje ridicat in statiunea Mamaia, zona hotel Metropol, lot 2 lot 3. Anahida Dogaru a depus la Agentia pentru Protectia ...

Spatiu de pe bulevardul Tomis, amenajat de Euxin SA
www.ziuaconstanta.ro - Constanţa
SC Euxin SA, controlata de Gabriela Dusu si Niculae Dusu, va demara lucrari de amenajare a unui spatiu situat pe bulevardul Tomis nr. 153. Pe data de 15 februarie, Euxin SA a obtinut de la Primaria ...

Editorial: Justitia, subiect de barfa“ in emisiuni TV. Cum sunt afectati cetatenii de acest spectacol mediatic
www.ziuaconstanta.ro - Constanţa
Oamenii simpli de la tara, al caror univers se invarte in special in jurul familiei si al gospodariei, folosesc adesea argumentul au spus si la televizor pentru a puncta un aspect important ce ar putea ...

Adam si Eva“, la Muzeul de Arta Populara Constanta
www.ziuaconstanta.ro - Constanţa
Doar doua zile ii mai despart pe crestinii ortodocsi de Postul Pastelui, pe parcursul caruia se vor pregati ca sa cinsteasca asa cum se cuvine cel mai mare praznic al crestinatatii, Invierea ...

Duelul fratilor: Baschetbalistii Cristi si Daniel Mainea se infrunta sambata in meciul CSO Voluntari - BC Athletic Constanta
www.ziuaconstanta.ro - Constanţa
Echipa masculina de baschet Athletic Constanta sustine sambata, 17 februarie, un nou meci din faza semifinala a Ligii 1, intalnind in deplasare CSO Voluntari. Partida este gazduita de sala Agronomia din ...

DJST Constanta desfasoara prima intalnire de consultare in proiectul national Dialog Structurat cu tinerii si organizatiile de tineret 2017 - 2018“
www.ziuaconstanta.ro - Constanţa
Directia Judeteana pentru Sport si Tineret Constanta reprezentant al Ministerului Tineretului si Sportului desfasoara alaturi de diferiti parteneri locali si cu sprijinul Colegiului National ...

Cristina Bujin si Cristi Boboc, de la CS Farul Constanta, concureaza la Campionatul Balcanic
www.ziuaconstanta.ro - Constanţa
Cristina Bujin CS Farul - CSA Steaua Bucuresti si Cristi Boboc CS Farul - CSU Galati sunt reprezentantii Constantei la editia a 23-a a Campionatului Balcanic de atletism in sala rezervat seniorilor, ...

Nurhan Ali, de la HC Dobrogea Sud Constanta, ales membru in Consiliul de Administratie al Federatiei Romane de Handbal
www.ziuaconstanta.ro - Constanţa
Cu ocazia Adunarii Generale de alegeri a Federatiei Romane de Handbal, Nurhan Ali, managerul general al HC Dobrogea Sud Constanta, a fost ales in functia de membru al Consiliului de Administratie al ...

Trei rugbysti de la Tomitanii Constanta vor juca in Olanda
www.ziuaconstanta.ro - Constanţa
Trei tineri rugbysti de la clubul Tomitanii Constanta, Cosmin Balan taloner , Andrei Georgian Cabason linia a II-a si Laurentiu Mihai Pocovnicu fundas , se numara printre cei 31 de sportivi ...

Imagini de la eveniment: La Constanta s-a deschis iNstantes - Festival International de Fotografie de Avintes (galerie foto)
www.ziuaconstanta.ro - Constanţa
Timp de o luna, Muzeul de Arta Constanta este gazda unei manifestari de anvergura, iNstantes - Festival International de Fotografie de Avintes, care se desfasoara concomitent in trei tari Romania ...

Proiectul de buget pe anul 2018, prezentat de Primaria Cumpana: Mariana Gaju - Vom oferi servicii publice locale de calitate, realizate echitabil, transparent si legal“ (galerie foto)
www.ziuaconstanta.ro - Constanţa
Peste 200 de locuitori ai comunei Cumpana au participat, joi seara, la dezbaterea publica privind bugetul comunei, eveniment organizat de autoritatea publica locala. Pe ordinea de zi au fost incluse trei ...

Marina Travel SRL, veste de la Tribunalul Constanta
www.ziuaconstanta.ro - Constanţa
Tribunalul Constanta a dispus mentinerea fata de inculpata SC Marina Travel SRL Eforie, reprezentata de lichidator judiciar DM Insolv Consult IPURL Bucuresti, prin Dumitriu Mircea Emil, a masurii ...

Dupa USR Constanta: Asociatiile Verde Urban“ si Constanta Altfel“ au atacat in instanta hotararile Consiliului Local care vizeaza parcul de miniaturi din Tabacarie
www.ziuaconstanta.ro - Constanţa
Dupa cei de la organizatia judeteana USR Constanta, si Asociatiile Verde Urban si Constanta Altfel au atacat in contencios administrativ hotararile CLM Constanta nr. 334 12.10.2017 si ...

Ce s-a intamplat: SSC Farul Constanta s-a intors din cantonamentul de la Curtea de Arges dupa numai trei zile!
www.ziuaconstanta.ro - Constanţa
Echipa de fotbal SSC Farul Constanta, clasata pe locul trei in seria secunda a Ligii a 3-a, s-a intors ieri din cantonamentul de la Curtea de Arges, desi perioada stagiului centralizat fusese stabilita ...

ARPIA - Filiala Constanta, 25 de ani de la infiintare (galerie foto)
www.ziuaconstanta.ro - Constanţa
Intr-un cadru festiv, pe 9 februarie 2018, aviatorii constanteni au sarbatorit 25 de ani de la infiintarea Asociatiei Romane pentru Propaganda si Istoria Aeronauticii ARPIA . Au participat fosti ...

#citesteDobrogea: Cate geamii si moschei se regaseau in Dobrogea anului 1928. Lucrari din Biblioteca Virtuala ZIUA de Constanta (galerie foto)
www.ziuaconstanta.ro - Constanţa
Dobrogea, spatiu multietnic si multicultural, este intesata si de lacasuri de cult crestine, dar si de geamii si moschei, ca un semn al bunelor relatii de convietuire care dau o nota distinctiva ...

Marturiile din Primul Razboi Mondial ale preotului Atanasie Popescu din Nufaru, judetul Tulcea: Biserica era devastata, iar icoanele erau impuscate“
www.ziuaconstanta.ro - Constanţa
Un alt preot care a indurat nedreptatile comise de soldatii bulgari dupa ocuparea Dobrogei in Primul Razboi Mondial a fost preotul Atanasie Popescu, din comuna Nufaru fosta Domnita Maria , judetul ...

O impozanta cladire din zona peninsulara a Constantei intra in reabilitare. Vega Turism SA, unda verde de la municipalitate (galerie foto)
www.ziuaconstanta.ro - Constanţa
Casa cu Lei, simbol al Constantei, va fi consolidata, restaurata si reamenajata. SC Vega Turism SA, controlata de omul de afaceri Gabriel Comanescu, a solicitat si a obtinut, pe data de 15 februarie, ...

Felix Stroe strange randurile in PSD Constanta. Intalniri cu organizatiile din judet si cu presedintii de organizatii. Cauta solutii pentru a trimite oameni in Guvernul Romaniei!
www.ziuaconstanta.ro - Constanţa
Presedintele PSD Constanta, Felix Stroe, s-a intalnit ieri, la Baneasa, cu activul de partid din sudul judetului. In urmatoarea perioada va avea loc o sedinta similara la Navodari si cu ...

Cine a fost audiat: Judecatorul Ionut Mihai Matei se pregateste sa inchida unul dintre dosarele lui Radu Mazare
www.ziuaconstanta.ro - Constanţa
Initial, dosarul a fost judecat de Mariana Ghena, fost magistrat stagiar in circumscriptia Curtii de Apel Constanta, fostul presedintele CSM Dosarul in care Radu Stefan Mazare, fostul primar al ...

Unirea Alba Iulia refuză să-l cedeze pe Lăsconi la CS Afumaţi, deşi jucătorul vrea să joace în retur la divizionara secundă
ziarulunirea.ro - Alba
Unirea Alba Iulia se opune plecării golgheterului Daniel Lăsconi la CS Afumaţi, divizionara secundă cu care atacantul a semnat un contract valabil din vară, în ciuda dorinţei atacantului intrat în ultima jumătate de an a înţelegerii cu formaţia din Cetatea Marii Uniri. Cum la finele sezonului Lăsconi ar pleca gratis de la divizionara terţă, fără […]

A omorât o femeie şi s-a predat la poliţie
www.ziarulargesul.ro - Argeş
În urmă cu doi ani, Vili Cohanoschi, de 63 de ani, din Piteşti, provocat un accident de circulaţie soldat cu moartea unei femei şi avarierea mai multor maşini. Evenimentul a avut loc în decembrie 2016, când Cohanoschi se urcase băut la volan şi circula dinspre cartierul Găvana către Trivale. A...

Recrutări la Armată
www.ziarulargesul.ro - Argeş
Elevii claselor a XII-a şi absolvenţii de liceu cu diplomă de bacalaureat, având vârsta de cel mult 26 de ani împliniţi în 2018 (24 de ani pentru opţiunea "piloţi"), care doresc să urmeze cariera militară, sunt aşteptaţi să se înscrie până la sfârşitul lunii martie la instituţii de învăţământ...

Spânzurat la streaşina casei
www.ziarulargesul.ro - Argeş
În această dimineaţă, un bărbat a fost găsit spânzurat în comuna Tigveni. Este vorba despre Constantin Trăşcan, în vârstă de 73 de ani, care a fost descoperit de un vecin cu care era prieten. Septuagenarul legase laţul de o grindă de la streaşina casei, iar vecinul a sunat imediat la 112 şi a...

FOTO – Accidentul de pe Semaforului. Șoferul se apără: Cei doi copii nu erau pe trecere
www.oradesibiu.ro - Sibiu
Șoferul care s-a aflat la volanul taxi-ului care a acroşat doi copii vineri după amiază pe strada Semaforului, susţine că aceştia nu au traversat regulamentar şi erau în fugă. Accidentul a avut loc pe…

Florin Iordache, despre raportul privind activitatea DNA - Ministrul Justitiei nu are cum sa arunce raportul DNA in curtea Parlamentului
www.ziuaconstanta.ro - Constanţa
Un raport privind activitatea DNA poate fi prezentat in Parlament, dar nu poate fi votat sau adoptat si Parlamentul nu poate interveni in procedura de revocare a procurorului-sef al DNA, a declarat vineri, la ...

ACȚIUNE revoltătoare a unui bărbat. A vrut să-şi incendieze CASA şi PROPRIA MAMĂ. Motivul este INCREDIBIL
evz.ro - Bucureşti
O mamă din Caraş-Severin a trecut prin momente cumplite după ce propriul său fiu a încercat să o incendieze în propria casă. Nebunia bărbatului a pornit......

CONCURENȚĂ. Ministrul Energiei îi bate OAIA lui Daea. Declaraţiile săptămânii!
evz.ro - Bucureşti
Până zilele trecute, ministrul Agriculturii, Petre Daea, era în centrul atenţiei pentru declaraţiile afectuoase faţă de ovine: ”oaia e o statuie vie”, “oaia...

Numărul persoanelor care au murit din cauza gripei a ajuns la 32. Ultima victimă, un tânăr de 28 de ani
ziarulunirea.ro - Alba
Numărul persoanelor care au murit din cauza gripei de la începutul anului şi până vineri, 16 februarie, a ajuns la 32, potrivit Centrului Naţional de Supraveghere şi Control al Bolilor Transmisibile din cadrul Institutului Naţional de Sănătate Publică. Ultima persoană care a murit din această cauză este un bărbat de 28 de ani din judeţul […]

INSP: Numărul persoanelor care au murit din cauza gripei a ajuns la 32. Ultima victimă, un tânăr de 28 de ani
ziarulunirea.ro - Alba
Numărul persoanelor care au murit din cauza gripei de la începutul anului şi până vineri, 16 februarie, a ajuns la 32, potrivit Centrului Naţional de Supraveghere şi Control al Bolilor Transmisibile din cadrul Institutului Naţional de Sănătate Publică. Ultima persoană care a murit din această cauză este un bărbat de 28 de ani din judeţul […]

Cum să te concentrezi la sală cu asemenea APARIȚII în preajmă?! Fete BINE LUCRATE cu outfit INDECENT. Au INNEBUNIT internetul - FOTO
evz.ro - Bucureşti
Se presupune că la sala de gimnastică te duci pentru exerciţii fizice, dar cum ai putea să te antrenezi când ai în preajmă fete cu astfel de forme?...

Situaţia salariilor, dezbătută la Comisia pentru Dialog Social
newsar.ro - Arad
Citeşte azi ce scriu ziarele de mâine!

Deieri-deazi.blogspot.ro:Povestile Balcicului
www.ziuaconstanta.ro - Constanţa
Va invit sa ne continuam calatoria - inceputa mai demult pe paginile blogului - prin locurile pline de farmec si intesate de povesti ale Coastei de Argint parte a Romaniei Mari de altadata. Vom ...

Laura Codruţa Kovesi, DEMASCATĂ de un psiholog: „MINTE fără să clipească!”
evz.ro - Bucureşti
În cadrul conferinţei de presă pe care a susţinut-o recent, Laura Codruţa Kovesi a avut mai multe gesturi nefireşti care au lăsat loc de interpretări.......

BOMBĂ! A fost DEZVĂLUIT raportul „poliţistului pedofil”. NEREGULILE care ies la iveală
evz.ro - Bucureşti
Raportul oficial al poliţistului Eugen Stan, acuzat că a agresat sexual doi copii, a fost dezvăluit, vineri, la Antena 3....

Staţie de încărcare pentru maşinile electrice în municipiul Satu Mare
portalsm.ro - Satu Mare
Staţie de încărcare pentru maşinile electrice în municipiul Satu Mare

Iasi. Fetita ai carei parinti au refuzat sa o trateze de cancer, a murit
www.ziuaconstanta.ro - Constanţa
Fetita de noua ani din localitatea Bohotin, comuna Raducaneni, care suferea de cancer renal si ai carei parinti au refuzat sa o mai trateze a murit. Fata suferea de cancer renal in faza avansata ...

ATAC armat în Washington. MULȚIMEA, în ALERTĂ! Mai mulţi copii sunt în PERICOL. BREAKING NEWS!
evz.ro - Bucureşti
Clipe de coşmar într-un colegiu din Washington. Acesta a fost înshis după ce au fost raportate mai multe focuri de armă în incinta ......

Cât costă FERICIREA? Specialiştii au calculat!
evz.ro - Bucureşti
Există un nivel optim al venitului care poate face o persoană fericită, iar suma respectivă variază la nivel mondial, conform concluziei unui studiu publica...

Cinci junioare II de la ACS Transilvania Braşov, convocate la loturile naţionale ale României
feedproxy.google.com - Braşov
În urma pregatirii si evolutiei excelente de până acum din Campionatele Naţionale, junioarele 2 de la ACS Transilvania Braşov, Ioana Bălăceanu, Ana Dulgheriu, Bianca Lupaşcu, Georgiana Olaru şi Rebeca Necula au fost selectate în loturile naţionale de junioare şi cadete ale României. Lotul national de cadete participa in aceste zile la Turneul International organizat de Federatia Romana de Handbal

Halep e în semifinale la Doha
www.stiridecluj.ro - Cluj
Halep e în semifinale la Doha

Mihai Fifor, la Conferinta de Securitate de la München. Securitatea Marii Negre, printre temele de discutie
www.ziuaconstanta.ro - Constanţa
Prezent la Conferinta de Securitate de la M nchen, ministrul Apararii Nationale, Mihai Fifor, a avut vineri, 16 februarie, o serie de intalniri bilaterale, in care a prezentat prioritatile Romaniei in ...

Criză de medici la cel mai mare spital din judeţul Sibiu. Nu vine nimeni la concursuri
www.oradesibiu.ro - Sibiu
Pare greu de crezut, dar Spitalul Judeţean Sibiu se confruntă de ani de zile cu o situaţie destul de critică. Aproape nimeni nu se prezintă la concursurile pentru ocuparea posturilor vacante de medici…

DE LA CITITORI: Seara de carte – un proiect de succes în cultura dâmboviţeană
www.gazetadambovitei.ro - Dâmboviţa
Articol realizat de Roxana Clopotaru, studentă în anul I la Facultatea de Știinte Politice, Litere şi Comunicare, specializarea jurnalism.

Capcană pusă seară de seară pe strada Cantonului, în zona colibelor de romi - FOTO
www.stiridecluj.ro - Cluj
Capcană pusă seară de seară pe strada Cantonului - FOTO

O firma din Italia va furniza piese de schimb companiei Nuclearelectrica SA. Valoarea contractului (document)
www.ziuaconstanta.ro - Constanţa
Societatea Nationala Nuclearelectrica SA a incheiat un contract de furnizare piese de schimb cu o firma din Italia. Valoarea contractului atribuit este de 6.011,01 lei. Potrivit licitatiapublica.ro, ...

Sindicatele din Educaţie iau în calcul declanşarea grevei generale şi boicotarea Bacalaureatului, dacă nu vor fi rezolvate problemele salariale
ziarulunirea.ro - Alba
Sindicatele din Educaţie iau în calcul declanşarea grevei generale şi boicotarea Bacalaureatului, dacă problemele salariale nu se rezolvă în cel mai scurt timp. O delegaţie a angajaţilor din învăţământ a mers în această dimineaţă la Ministerul Educaţiei şi a cerut o întâlnire cu ministrul Valentin Popa. Oamenii spun că au ajuns la capătul răbdării şi […]

HAOS în centrul Capitalei! Se întâmplă ÎN ACEST MOMENT. Circulaţia este BLOCATĂ
evz.ro - Bucureşti
Este haos, vineri seară, în centrul Capitalei. O avarie la reţeaua de apă a dat tot traficul peste cap....

Un fost internaţional român UIMEȘTE: „Eu şi Maradona eram şefii MAFIEI. El cu DROGURILE, eu cu HOȚII”
evz.ro - Bucureşti
Dănuţ Lupu, fost internaţional român, a rememorat experienţa trăită în Grecia, în perioada în care îmbrăca tricoul celor de la Panathinaikos....

Avere nejustificată pentru un vameş din Halmeu. Luat în vizor de către inspectorii ANI
portalsm.ro - Satu Mare
Avere nejustificată pentru un vameş din Halmeu. Luat în vizor de către inspectorii ANI

Treisprezece RUȘI şi trei COMPANII, PUȘI SUB ACUZARE în SUA. Dosarul INTERFERENȚELOR Kremlinului în ALEGERILE PREZIDENȚIALE din Statele Unite, în linie dreaptă
evz.ro - Bucureşti
Treisprezece cetăţeni ruşi au fost puşi sub acuzare de investigatorul special Robert Mueller, în dosarul ingerinţelor Rusiei în alegerile prezidenţiale din ...

Cine a fost internat în spital îşi poate RECUPERA banii dacă a fost NEVOIT să-şi CUMPERE medicamente
evz.ro - Bucureşti
După declaraţiile făcute de ministrului sănătăţii privind obligaţia spitalelor de a asigura medicaţia pacienţilor şi dreptul lor de a primi contravaloarea î...

Monitorul Oficial:IFN Garant Grup Credite SRL are un nou administrator
www.ziuaconstanta.ro - Constanţa
Virgil Dulea si Cristina Serbu, asociati in cadrul societatii IFN Garant Grup Credite SRL, prin Hotararea nr. 1 din data de 9.01.2018, au hotarat numirea in functie a noului administrator, Virgil Dulea. ...

PROIECT: Patronii care îşi ţin angajaţii peste program şi nu îi plătesc să fie amendaţi pentru fiecare persoană în parte identificată ca prestând muncă suplimentară
ziarulunirea.ro - Alba
Amenzile pentru neplata muncii suplimentare, în cazul patronilor care nu respectă prevederile Codului muncii, vor fi date pentru fiecare persoană în parte, identificată că a efectuat muncă suplimentară şi nu i s-au acordat plăţile corespunzătoare, prevede un proiect legislativ depus la Senat. Parlamentarii care au iniţiat acest act normativ aduc ca argumente, în expunerea de […]

CUTREMUR în lumea MANELIȘTILOR. Celebrul Marinică Nămol a FURAT mireasa de la nuntă, iar aceasta i-a făcut SEX ORAL în maşină. FOTO
evz.ro - Bucureşti
Marinică Nămol, unul dintre cei mai cunoscuţi şi iubiţi manelişti a zguduit lumea mondenă. Celebrul cântăreţ a furat mireasa unui prieten de la nuntă......

CAZ ȘOCANT. După ce s-a jucat toată seara la PĂCĂNELE, un bărbat A MURIT. Ce s-a întâmplat e HALUCINANT
evz.ro - Bucureşti
Un bărbat de 45 de ani a murit în timp ce se afla într-o sală de jocuri din Iaşi. Deşi au sosit imediat la faţa loicului, echipajele medicale nu au mai......

Accident provocat de un sofer care s-a urcat baut la volan, in fata Garii de Nord din Timisoara
www.tion.ro - Timiş
Accident de circulaţie, joi seară, în faţa Gării de Nord din Timişoara. Două maşini s-au ciocnit şi două persoane au fost rănite, după ce un şofer a trecut pe roşu. Mai mult, el era şi în stare de ebrietate.

Un primar arădean a CÂŞTIGAT procesul cu ANI
newsar.ro - Arad
Citeşte azi ce scriu ziarele de mâine!

Un primar arădean a CÂŞTIGAT procesul cu ANI
newsar.ro - Arad
Citeşte azi ce scriu ziarele de mâine!

Descinderi ale mascaţilor la Satu Mare şi Odoreu
portalsm.ro - Satu Mare
Descinderi ale mascaţilor la Satu Mare şi Odoreu

Alcoolemie de 2,2 la un şofer ce mergea pe Calea Dumbrăvii. A fost arestat
www.oradesibiu.ro - Sibiu
Poliţiştii de la Rutieră au depistat zilele trecute un şofer care mergea băut bine la volan. Bărbatul de 40 de ani a fost reţinut joi pentru 24 de ore. În data de 15 februarie a.c., poliţiştii…

Dragnea RUPE TĂCEREA! Ce a vorbit cu Iohannis. DEZVĂLUIRI EXPLOZIVE din spatele UȘILOR ÎNCHISE de la Cotroceni
evz.ro - Bucureşti
Preşedintele PSD, Liviu Dragnea a făcut dezvăluiri incendiare referitor la întâlnirea de la Cotroceni cu preşedintele Iohannis şi premierul Viorica Dăncilă....

Simona Halep s-a retras din turneul de la Doha!
www.ziuaconstanta.ro - Constanţa
Simona Halep s-a retras din turneul de la Doha! Romanca a acuzat o accidentare si nu va mai putea evolua in semifinala. Halep ar putea rata si urmatorul turneu, de la Indian Wells. Simona Halep a decis ...

Zona Teatrului de Vara Mamaia, igienizata (galerie foto)
www.ziuaconstanta.ro - Constanţa
Ruinele din zona Teatrului de Vara Mamaia au fost demolate iar locul a fost igienizat. Anuntul a fost facut de vicepresedintele Consiliului Judetean Constanta Claudiu-Iorga Palaz, pe pagina personala de ...

Renault afiseaza rezultate record, Carlos Ghosn reconfirmat in functia de CEO
ziarmm.ro - Maramureş
Constructorul auto francez Renault a raportat vineri vanzari si profituri record pentru 2017, ceea ce consolideaza pozitia directorului general Carlos Ghosn in fata solicitarilor Guvernului francez pe

HC Dobrogea Sud Constanta, victorie in meciul cu CSM Focsani 2007
www.ziuaconstanta.ro - Constanţa
Echipa masculina de handbal HC Dobrogea Sud Constanta a castigat meciul jucat in aceasta seara pe teren propriu cu CSM Focsani 2007, in etapa a 19-a a Ligii Nationale. Gazdele s-au impus cu 31-25 ...

Strategia de Dezvoltare Locală a Sebeşului finanţată cu aproape 7 milioane de euro de Ministerul Fondurilor Europene
ziarulunirea.ro - Alba
Locul al III-lea la nivel naţional în topul proiectelor eligibile Strategia de Dezvoltare Locală a Municipiului Sebeş a fost selectată de către Ministerul Fondurilor Europene pentru finanţare prin Programul Operaţional Regional şi Programul Operaţional Capital Uman. Finanţarea nerambursabilă a strategiei are valoarea de 6.995.000 de euro. Măsurile prevăzute în Strategia de Dezvoltare Locală a Municipiului […]

FOTO: Descindere a pompierilor la un peco din Focşani! Salvatorii s-au antrenat pentru ce e mai rău
www.jurnaldevrancea.ro - Vrancea
Detaşamentul de Pompieri Focşani a desfăşurat, vineri, un amplu exerciţiu de antrenament într-o staţie de carburanţi, la ieşirea din Focşani spre Mărăşeşti.

CAZ incredibil. Un câine a SUPRAVIEȚUIT în mod miraculos după ce PATRU TRENURI au trecut peste el
evz.ro - Bucureşti
Povestea incredibilă a unei căţeluse din rasa Labrador a făcut înconjurul lumii. Deşi a fost victima a patru trenuri ce au trecut, pur şi simplu, peste......

ÎNGROPATĂ DE VIE, din greşeală! 11 zile S-A ZBĂTUT să iasă din SICRIU. ESTE ȘOCANT cum au găsit-o rudele
evz.ro - Bucureşti
O femeie a fost îngropată de vie, din greşeală şi s-a zbătut pentru a scăpa din sicriu timp de 11 zile....

Șofer prins băut la volan pe Mihai Viteazu. S-a ales cu dosar penal
www.oradesibiu.ro - Sibiu
În data de 16 februarie în jurul orei 04,00, pe Bulevardul Mihai Viteazul din municipiul Sibiu, a fost identificat un alt conducător auto aflat sub influenţa alcoolului. Este vorba despre un sibian în…

Rezultate finale Politia Locala Constanta. Lista candidatilor admisi (documente)
www.ziuaconstanta.ro - Constanţa
Concursul pentru ocuparea functiilor publice locale de executie vacante din cadrul Primariei Municipiului Constanta - Directia Generala Politia Locala s-a incheiat. Candidatii pentru un post in ...

Cea mai mare pârtie de pe Semenic stă nefolosită! Primăria Văliug, prinsă la mijloc între interesele CJ Caraş-Severin şi CJ Timiş!
expressdebanat.ro - Caraş-Severin
Pârtia „Uriaşi” de pe Semenic, cea mai mare pârtie de schi de pe vârful muntelui, cu o lungime de 1200 de metri, stă nefolosită de ani buni din cauza autorităţilor ce o administrează.

Focşani, oraşul FĂRĂ logo! Nimeni nu a câştigat concursul organizat de Primărie
www.jurnaldevrancea.ro - Vrancea
Vineri a avut loc ultima etapă a concursului “Logo reprezentativ pentru Municipiul Focşani”, jurizarea lucrărilor. Pentru juriu, format din reputaţi oameni de artă şi cultură, dar şi din domeniul publicităţii, a fost o misiune dificilă.

AVERTISMENT FĂRĂ PRECEDENT! Coreea de Nord, AMENINȚARE TOT MAI MARE: „Se află în raza de acţiune a rachetelor”
evz.ro - Bucureşti
Coreea de Nord reprezintă o ameninţare pentru toate statele membre ale alianţei Nord Atlantice, este semnalul de alarmă tras de secretarul general al NATO, ...

EXISTĂ MINUNI! Elena Cernica a adunat banii necesari şi va fi operată în Germania la începutul lunii martie
www.jurnaldevrancea.ro - Vrancea
Vrâncenii şi nu numai s-au mobilizat exemplar şi au sărit în ajutorul poliţistei Elena Cernica, diagnosticată cu o tumoră pe creier într-o zonă foarte periculoasă. Cu ajutorul oamenilor de bine, care au donat bani pentru ea, poliţista a reuşit să ajungă în Germania, unde medicii s-au declarat

VIDEO: Un patron din Focşani, condamnat pentru moartea unui om într-un accident produs de el
www.jurnaldevrancea.ro - Vrancea
Iulian Lemnaru, patronul unei firme de transport din Focşani, a fost condamnat la doi ani de închisoare cu suspendare pentru ucidere din culpă. Decizia instanţei din Brăila nu este definitivă. Accidentul a a avut loc în ianuarie anul trecut, pe o stradă din Brăila.

APIA: Suma totală plătită fermierilor pentru Campania 2017 depăşeşte două miliarde de euro
ziarulunirea.ro - Alba
Suma totală plătită, reprezentând avans şi plata regulară aferentă Campaniei 2017, se ridică la 2,073 miliarde de euro, iar numărul fermierilor unici autorizaţi la plată a ajuns la 753.357 până la data de 15 februarie 2018, a informat, joi, Agenţia de Plăţi şi Intervenţie pentru Agricultură (APIA). „Începând cu data de 16 octombrie 2017, pentru […]

Poliţiştii au dat amenzi pe bandă rulantă şi au confiscat aproape 200 de metri cubi de material lemnos
www.jurnaldevrancea.ro - Vrancea
Poliţiştii din Vrancea au continuat activităţile pe linia prevenirii şi combaterii delictelor silvice din judeţ. Vizaţi de oamenii legii au fost toţi cei care au exploatat, au transportat şi au comercializat material lemnos fără a ţine cont de legislaţia în vigoare.

NOI informaţii în SCANDALUL DNA. Daniel Savu CONTRAATACĂ. Ce le pregăteşte procurorului „Portocală” şi lui Lucian Onea
evz.ro - Bucureşti
Scandalul din cadrul DNA ia amploare, iar finalul pare a fi departe de a se arăta curând. Fostul senator, Daniel Savu a declarat că a depus sesizare la......

Cât pierzi din salariu dacă eşti în CONCEDIU MEDICAL
evz.ro - Bucureşti
Ordonanţa 3/2018 nu ocoleşte dascălii aflaţi în concediu medical. Noua formulă de calcul a salariului acordat în timpul concediului medical va diminua sala...

Legile Justitiei. Un inalt oficial german cere initierea Articolului 7 din Tratatul UE, in cazul Romaniei
www.ziuaconstanta.ro - Constanţa
Presedintele Comisiei pentru Afaceri Europene din Bundestag, Gunther Krichbaum, ii cere presedintelui Comisiei Europene, Jean-Claude Juncker, printr-o scrisoare, sa nu suspende aplicarea Mecanismului de ...

Elton John, lovit in timpul concertului de un colier aruncat din public
www.tion.ro - Timiş
Elton John a fost lovit de un colier aruncat de un fan, în timp ce susţinea un concert în Las Vegas.

Oamenii de ştiinţă sunt ȘOCAȚI. Cum arată GHEȚARUL URIAȘ care s-a desprins din Antarctica. GALERIE foto uluitoare
evz.ro - Bucureşti
Gheţarul uriaş ce s-a desprins dintr-o calotă glaciară i-a uimit pe cercetători. Bucata impresionantă de gheaţă are 190 de metri, însă numai 30 dintre......

Alexandru Arşinel trece prin CLIPE CUMPLITE: „Am nevoie de ajutorul lui Dumnezeu”
evz.ro - Bucureşti
Alexandru Arşinel trece prin momente cumplite. Îndrăgitul actor a declarat că se roagă în fiecare zi la Dumnezeu....

Campionatul câinilor isteţi: Cupa Braveheart Oradinum, cel mai mare concurs de mondioring din ţară, în şanţul Cetăţii (FOTO/VIDEO)
www.ebihoreanul.ro - Bihor
Peste 40 de căţei, majoritatea din rasele Ciobănesc german şi Malinois, din şase ţări europene, sunt în 'sesiune' la Oradea. Clubul Nord de Dresaj Canin din Oradea organizează, în acest weekend, Cupa Braveheart Oradinum, cel mai mare concurs de mondioring, adică sport canin, din România. Orădenii curioşi sunt invitaţi să urmărească examenele desfăşurate în şanţul Cetăţii şi jurizate de specialişti din străinătate.

Bugetul de venituri şi cheltuieli al oraşului Panciu a fost aprobat
www.jurnaldevrancea.ro - Vrancea
Joi, 15 februarie 2018, Consiliul Local Panciu, convocat în şedinţă extraordinară, a aprobat, cu unanimitate de voturi, Bugetul de venituri şi cheltuieli al oraşului Panciu pe anul 2018. Cu acelaşi prilej, au fost aprobate şi bugetele instituţiilor publice aflate sub autoritatea Consiliului Local.

BOMBĂ! „Regele maneliştilor”, condamnat DEFINITIV la închisoare. Cât va sta după gratii
evz.ro - Bucureşti
Impresarul mai multor cântăreţi de manele, cunoscut în lumea interlopă drept „Regele Maneliştilor” a fost condamnat pentru constituirea unui grup infracţion...

Prognoză surprinzătoare anunţată de meteorologi: Cum va fi vremea în weekend, în România
ph-online.ro - Prahova
Vremea se încălzeşte şi rămâne peste valorile normale pentru această perioadă a anului. Vineri, în cea mai mare parte a ţării, regimul termic va fi ca...

17-18 februarie 2018: Festivalul Unirii bucătăriei tradiţionale româneşti, la Zlatna. Reţete tradiţionale gătite în stil antic, show-uri culinare şi spectacole de muzică
ziarulunirea.ro - Alba
Festivalul Unirii bucătăriei tradiţionale româneşti, la Zlatna! Timp de două zile localnicii din Apuseni şi nu numai se vor putea bucura de tradiţiile culinare româneşti într-un eveniment dedicat gurmanzilor. Bucătăriile tradiţionale se vor uni la fel cum au făcut-o românii în 1918. Frăţia Ceaunelor prezintă 4 reţete tradiţionale din 4 zone ale ţării, gătite în […]

Aquapark-ul din Oradea a încheiat primul an cu un milion de euro profit!
www.ebihoreanul.ro - Bihor
Aquapark-ul Nymphaea din Oradea a încheiat primul an de funcţionare cu încasări de circa trei milioane de euro şi profit de un milion de euro. Pentru a diminua cozile de la intrare, începând din luna mai conducerea Administraţiei Domeniului Public va deschide o casă destinată exclusiv clienţilor care şi-au cumpărat bilete online. În paralel, ADP va muta piaţa de vechituri peste drum de cartierul Europa, va înfiinţa la Zoo un ţarc în care copiii să poată interacţiona cu animalele şi va construi în cimitir un columbar pentru urnele cu cenuşa orădenilor incineraţi.

Un reşiţean a fost reţinut după ce şi-a stropit mama cu benzină şi a încercat să-i dea foc!
expressdebanat.ro - Caraş-Severin
Totul s-a petrecut ieri la locuinţa unei familii din Reşiţa. Potrivit procurorilor Parchetului de pe lângă Tribunalul Caraş-Severin, bărbatul „la un moment dat i-a solicitat mamei sale să-i caute un act, însă nu l-a găsit, fapt ce l-a enervat şi a început să ţipe şi să-i reproşeze diverse chestiuni, apoi a luat hotărârea să dea foc atât locuinţei cât şi mamei”.

USR, al treilea partid (ca număr de voturi) din România, are la Neamţ maxim 80 de membri
www.stiri-neamt.ro - Neamţ
USR, cel de-al treilea partid (ca număr de voturi la ultimile alegeri) din România, are la Neamţ în jur de 70-80 de membri. Declaraţia a fost făcută astăzi

USR, al treilea partid (ca număr de voturi) al României, are la Neamţ maxim 80 de membri
www.stiri-neamt.ro - Neamţ
USR, cel de-al treilea partid (ca număr de voturi la ultimile alegeri) din România, are la Neamţ în jur de 70-80 de membri. Declaraţia a fost făcută astăzi

Clădirea unei IMPORTANTE PUBLICAȚII, EVACUATĂ! ALERTĂ în inima Londrei. Autorităţile intervin în forţă
evz.ro - Bucureşti
Clădirea publicaţiei britanice The Financial Time a fost evacuată, vineri după amiaza, după apariţia unui pachet suspect....

Vanzare teren in Zalau – Extras publicatie imobiliara, din data de 16. 02. 2018
ziarmm.ro - Maramureş
Noi, Societatea Civila Profesionala de Executori Judecatoresti Morari si Asociatii cu sediul/domiciliul in loc. Baia Mare, str. George Cosbuc, nr. 25A, ap. 10, jud. Maramures, prin executor judecatore

CRITICI ACIDE la adresa lui Klaus Iohannis. Șeful statului, făcut K.O de Bruxelles după conferinţa de la Cotroceni
evz.ro - Bucureşti
Intervenţia publică a preşedintelui Klaus Iohannis a declanşat un val de atacuri de la Bruxelles. Printr-un mesaj postat pe Facebook, europarlamentarul......

Accident rutier grav in Mihail Kogalniceanu, judetul Constanta. O persoana decedata
www.ziuaconstanta.ro - Constanţa
In urma cu putin timp, un accident rutier grav s-a produs in localitatea Mihail Kogalniceanu din judetul Constanta. O persoana este ranita iar cea de-a doua a decedat, in urma evenimentului. Stire ...

Patriarhia precizează: Interdicţia filmărilor în Biserică nu se referă la botezuri şi cununii
portalsm.ro - Satu Mare
Patriarhia precizează: Interdicţia filmărilor în Biserică nu se referă la botezuri şi cununii

Doua evenimente din programul ”Celebram Romania 100”, organizate de Centrul de Cultura
www.tion.ro - Timiş
Centrul de Cultură şi Artă Timiş invită timişorenii la un dublu eveniment care face parte din programul ”Celebrăm România 100”, marţi, 20 februarie 2018, la ora 14. Este vorba despre vernisajul expoziţiei etnografice semnată Marius Matei - „Tezaur etnografic. Costumul naţional românesc din Banat” şi lansarea lucrării de grafică a prof. dr. Gabriel Kelemen care „surprinde dinamica viului la nivelul biosferei într-un limbaj estetic contemporan”.

Simona Halep, in semifinale la Doha! A invins-o pe Cici Bellis
www.ziuaconstanta.ro - Constanţa
Simona Halep 26 de ani, 2 WTA a castigat in sferturile de finala ale turneului WTA Premier 5 de la Doha impotriva jucatoarei americane de Catherine CiCi Bellis 18 ani, 48 WTA , 6-0, 6-4. Simona o va ...

Sindicate: Mii de salariaţi din Educaţie care au probleme de sănătate sau sunt în concediu de creştere a copilului pierd venituri semnificative
ziarulunirea.ro - Alba
Potrivit calculelor făcute de Federaţia Sindicatelor Libere din Învăţământ (FSLI), mii de angajaţi din educaţie sunt afectaţi de prevederile Codului Fiscal, prin care a fost stabilită noua formulă de calcul a salariului acordat în timpul concediului medical, pierzând aproximativ 20 la sută din venit. Sindicaliştii cer Guvernului să intervină de urgenţă pentru modificarea acestor prevederi […]

ICCJ, decizie definitiva cu privire la contestatia depusa de Tel Drum
www.ziuaconstanta.ro - Constanţa
Judecatorii de la Inalta Curte de Casatie si Justitie au respins definitiv, vineri, contestatia depusa de Tel Drum, prin care societatea cere ridicarea sechestrului pus de DNA pe bunuri si conturi, ...

NEWS ALERT. Simona Halep va evolua în SEMIFINALELE de la Doha. Românca A CÂȘTIGAT în două seturi meciul din „sferturi”
evz.ro - Bucureşti
Simona Halep s-a calificat, vineri, în semifinalele turneului de la Doha, după succesul obţinut în faţa americancei Catherine Bellis, scor 6-0, 6-4....

ADVERTORIAL: O saptamana pe “Coasta Soarelui”
ziarmm.ro - Maramureş
Costa del Sol - pentru orice buzunar Costa del Sol este considerat cel mai frumos litoral continental al Marii Mediterane. Situata in sudul Spaniei, pe o intindere de 160 km, Costa del Sol este o inl

Examen la Timisoara pentru cei care vor sa devina preoti
www.tion.ro - Timiş
La Timişoara se va organiza o nouă sesiune a examenului de capacitate preoţească. Se pot înscrie doar licenţiaţii în Teologie Pastorală, cei care doresc hirotonia întru preot. Cei care vor să devină preoţi se pot înscrie la examen începând de luni, 19 februarie.

Dezvăluiri EMOȚIONANTE! O cunoscută prezentatoare TV RUPE TĂCEREA: „Plâng pe rupte”
evz.ro - Bucureşti
O cunoscută prezentatoare TV s-a decis să-şi deschidă sufletul în faţa camerelor de luat vederi, făcând dezvăluiri neaşteptate despre viaţa sa personală....

Atenţie la APLICAŢIA ”Protect Free VPN+Data Manager”. Are scopul de a CENTRALIZA date personale ale utilizatorilor
evz.ro - Bucureşti
Facebook la prima vedere pare bine intenţionat şi totdeauna în folosul utilizatorilor dar, potrivit specialiştilor, nu-i chiar aşa. Vorbim de o nouă aplicaţ...

Campionatul câinilor isteţi: Cupa Braveheart Oradinum, cel mai mare concurs de mondioring din ţară, în şanţul Cetăţii
www.ebihoreanul.ro - Bihor
Peste 40 de căţei, majoritatea din rasele Ciobănesc german şi Malinois, din şase ţări europene, sunt în 'sesiune' la Oradea. Clubul Nord de Dresaj Canin din Oradea organizează, în acest weekend, Cupa Braveheart Oradinum, cel mai mare concurs de mondioring, adică sport canin, din România. Orădenii curioşi sunt invitaţi să urmărească examenele desfăşurate în şanţul Cetăţii şi jurizate de specialişti din străinătate.

Intalnire la Prefectura pe tema situatiei de la Weidmuller
ziarmm.ro - Maramureş
La Palatul Administrativ a avut loc vineri, 16 februarie, o sedinta de lucru cu privire la respectarea modului de aplicare a prevederilor Codului Fiscal, referitoare la transferul contributiilor socia

Manifestare cultural-artistica in Baia Mare dedicata Zilei Dezrobirii Romilor
ziarmm.ro - Maramureş
In holul Palatul Administrativ s-a desfasurat vineri, 16 februarie, o manifestare cultural-artistica dedicata Zilei Dezrobirii Romilor. Actiunea a fost organizata de catre Institutia Prefectului-Judet

Fostul senator, Daniel Savu, contraatacă: Sesizare la Inspecţia Judiciară după dosarul fabricat de Negulescu si Onea
ph-online.ro - Prahova
Fostul senator PSD, Daniel Savu, se află în centrul unui nou scandal. După ultimele înregistrări apărute din interiorul DNA Prahova a reieşit că...

CANCERUL la COPII, în CREȘTERE alarmantă. România NU are REGISTRU NAȚIONAL al CANCERULUI PEDIATRIC
evz.ro - Bucureşti
Peste 230 de copii bolnavi de cancer sunt luaţi în evidenţa compartimentului de Oncologie Pediatrică din cadrul Spitalului Judeţean Constanţa...

Niculae Bădălău, DECLARAȚIE-ȘOC după perioada avută în POLITICĂ: „Nu am devenit mai ÎNȚELEPT.” Ce spune despre o NOUĂ candidatură
evz.ro - Bucureşti
În cadrul unei conferiţe de presă ce a avut loc la sediul PSD Giurgiu, Niculae Bădălău, actualul preşedinte executiv al partidului giurgiuvean a luat......

Mineriada din Iunie 1990, prin ochii CIA! România FIERBEA, americanii se bazau pe scandalurile dintre Armartă-Securitate şi Brucan-Iliescu
evz.ro - Bucureşti
Mineriada din Iunie 1990. Pentru mulţi români de vârsta mea, evenimentele din Iunie 1990 rămân unele dintre cele mai traumatizante din......

Vlogger-ul armatei Romaniei, episodul doi din Povesti din Armata (video)
www.ziuaconstanta.ro - Constanţa
Radu Chirila, vlogger-ul oficial al armatei Romaniei a revenit cu episodul numarul 2 din seria Povesti din Armata . Simpaticul vlogger prezinta, in acest episod, primul sau contact cu mediul militar si cum ...

Sindicat: Veniturile angajatilor din Educatie aflati in concediu medical, mai mici cu 20 % din cauza noii formule de calcul
ziarmm.ro - Maramureş
Noua formula de calcul a salariului acordat in timpul concediului medical afecteaza mii de salariati din educatie, veniturile acestora diminuandu-se cu aproximativ 20%, se arata intr-un comunicat al F

ULTIMĂ ORĂ: Volkswagen înfipt în parapet pe pasarela de la Goleşti
www.jurnaldevrancea.ro - Vrancea
Accident de circulaţie, în urmă cu puţin timp, pe DN2 E85, pe podul de la intrarea în Goleşti dinspre Coteşti.Un autoturism Volkswagen înmatriculat în judeţul Galaţi, care venea dinspre Buzău, s-a oprit în separatorul de sensuri de pe pod.

"Ploiestiul Paralel" ep. 2/ Focar de infectie din cauza gunoaielor, in cartierul Cina
ph-online.ro - Prahova
O cititoare a ziarului nostru ne-a trimis la redactie fotografii care ilustreaza foarte bine tema campaniei "Ploiestiul paralel", lansata de Ph-online...

CRITICAT pentru fapte bune! Ambulanţierul care a CĂRAT în spate o pacientă prin nămeţi, TRAS LA RĂSPUNDERE
evz.ro - Bucureşti
Medicul-salvator din judeţul Alba care a cărat o pacientă până la ambulanţă pentru că nu se putea ajunge în cătunul unde locuia aceasta se confruntă cu......

Politistii locali continua raziile la schroturile auto si service-urile din Timisoara. Amenzi de 19.000 de lei
www.tion.ro - Timiş
Poliţiştii locali au continuat şi în această săptămână acţiunile la schroturile şi service-urile auto din Timişoara. S-a lăsat şi de data asta cu amenzi consistente, care ajung la circa 19.000 de lei.

Nava militara americana, escala in portul Constanta
www.ziuaconstanta.ro - Constanţa
Distrugatorul american USS Ross va face o escala in portul Constanta, in perioada 18-21 februarie, iar o delegatie condusa de comandantul navei, capitan-comandorul Bryan S. Gallo, va efectua vizite la ...

Vlad Cosma prezintă dovada care ÎNGROAPĂ discursul Laurei Codruţa Kovesi. Inca o MINCIUNA a sefei DNA
ph-online.ro - Prahova
Procurorul şef al DNA, Laura Codruţa Kovesi, declara faptul că Vlad Cosma a fost martor cu identitate protejată în dosarele DNA şi s-a dus benevol de...

„Soarta Parcului Naţional Semenic-Cheile Caraşului va fi pecetluită!“ Zonele protejate, diminuate drastic!
expressdebanat.ro - Caraş-Severin
„Veştile rele nu se mai termină, dar asta le întrece pe toate! De parcă nu era destul de masacrat, în loc să crească zonele interzise la tăiere, Romsilva intenţionează să scadă masiv suprafaţa strict protejată din Parcul Naţional Semenic - Cheile Caraşului“, a anunţat azi Agent Green. Vor urma amenzi de la UE de 100.000 euro pe zi?

FOTO, ȘTIREA TA. Plângere la Primăria Alba Iulia după ce utilajul de ridicat maşini a smuls un cablu şi a deteriorat peretele unui bloc
ziarulunirea.ro - Alba
Utilajul de ridicat maşini din Alba Iulia a agăţat un cablu prins pe un bloc, deteriorând peretele acestuia, o plângere în acest sens fiind înaintată spre soluţionare Primăriei Alba Iulia. Blocul se află pe strada Ștefan cel Mare din Alba Iulia. Locatarii acestuia se arată nemulţumiţi, după ce utilajul care a prins cablul (de la […]

„Copilul” lui Mayweather, românul Ronald Gavril, se bate pentru titlul mondial WBC. Pe urmele lui Aurel Toma, „Spaima campionilor”
evz.ro - Bucureşti
Duminică dimineaţă, tot românul amator de box va tremura în faţa televizorului pentru băcăuanul Ronald Gavril care, la 31 de ani, boxează pentru centura......

Un sătmărean, urmărit general, prins în Cluj. A prezentat poliţiştilor buletinul altei persoane
portalsm.ro - Satu Mare
Un sătmărean, urmărit general, prins în Cluj. A prezentat poliţiştilor buletinul altei persoane

Infractor dat în urmărire generală prins la Cluj. A încercat să îi păcălească pe poliţişti şi le-a dat buletinul altei persoane
www.stiridecluj.ro - Cluj
Poliţiştii clujeni au depistat, joi, pe Calea Turzii, un bărbat dat în urmăr...

Infractor dat în rumărire generală prins la Cluj. A încercat să îi păcălească pe poliţişti şi le-a dat buletinul altei persoane
www.stiridecluj.ro - Cluj
Poliţiştii clujeni au depistat, joi, pe Calea Turzii, un bărbat dat în urmăr...

Centrul Militar Judetean Tulcea, 50 de ani de la infiintare
www.ziuaconstanta.ro - Constanţa
In cadru festiv, vineri, 16 februarie, reprezentantii Garnizoanei Tulcea au marcat 50 de ani de la infiintarea Centrului Militar Judetean Tulcea, cu o zi in avans. Vicepresedintele Consiliului ...

CLUJ: Hoţ ”profesionist” arestat la Turda! Avea la activ 8 furturi în doar două luni
www.stiridecluj.ro - Cluj
Poliţiştii clujnei au depistat şi reţinut un bărbat bănuit de comiterea a 8 furturi....

4,8 milioane de lei pentru buncărul de radioterapie
www.zi-de-zi.ro - Mureş
Consilierii judeţeni au aprobat joi, 15 februarie, într-o şedinţă ordinară de lucru, documentaţia şi

Au inceput pregatirile pentru editia din acest an a Salonului Vinvest
www.tion.ro - Timiş
Cea mai nouă ediţie a celui mai important salon de vinuri organizat în România în afara Bucureştiului se apropie de un nou start. Din 30 martie şi până pe 1 aprilie, 300 de sortimente excepţionale de vin, unele în premieră naţională, vor fi expuse şi degustate la a XV-a ediţie a Vinvest 2018.

Creştere cu 75% a profitului Oltchim, la 45,64 milioane de lei
ziaruldevalcea.ro - Vâlcea
Combinatul petrochimic Oltchim Râmnicu Vâlcea a obţinut, în 2017, un profit net de 45,64 milioane de lei, faţă de 26,05 milioane de lei în anul 2016, potrivit datelor preliminare ale companiei…

Formularul 600, simplificat. Solutia va fi prezentata saptamana viitoare. Declaratiile ministrului Finantelor
www.ziuaconstanta.ro - Constanţa
Formularul 600 si-ar putea gasi o solutie saptamana viitoare. Ministrul Finantelor spune, in plus, ca va fi vorba despre simplificarea mecanismului de declarare a contributiilor. Saptamana ...

Arnold Schwarzenegger DOARME PE STRĂZI! Imagine cu PUTERNIC IMPACT EMOȚIONAL: „Cum s-au schimbat vremurile”
evz.ro - Bucureşti
O fotografie postată de celebrul actor şi fost guvernator al statului California, Arnold Schwarzenegger, a devenit virală pe internet. In imagine, vedeta ap...

Vine defrişarea! ADP Oradea va tăia 200 de arbori maturi crescuţi între mormintele din cimitir
www.ebihoreanul.ro - Bihor
Administraţia Domeniul Public Oradea va tăia anul acesta nu mai puţin de 200 de arbori maturi crescuţi între mormintele din cimitirul municipal. Decizia a fost luată ca urmare a numărului mare de reclamaţii formulate de orădenii revoltaţi că rădăcinile copacilor distrug monumentele funerare. În locul pomilor tăiaţi, ADP va planta 400 de paltini pe marginea aleilor din cimitir, 200 de arbori la Grădina Zoologică şi 100 la adăpostul de câini Grivei.

FOTO. Trei cvartale de parcări, modernizate în municipiul Satu Mare
portalsm.ro - Satu Mare
Trei cvartale de parcări, modernizate în municipiul Satu Mare

Descoperă eficienţa unei plite încorporabile în bucătăriile românilor
evz.ro - Bucureşti
Plite ăncorporabile. Electrocasnicele şi aparaturile care ne uşurează viaţa prin utilitatea lor cunosc un real progres de la o zi la alta, oferind acelaşi ...

Drama traita de Diana Bulimar, gimnasta de doar 1.52m de la Exatlon Romania. A marcat-o pe viata: "Totul s-a ruinat..."
ph-online.ro - Prahova
Fosta gimnasta in varsta de 22 de ani, , membra a echipei "Faimosilor" in emisiunea Exatlon, a avut multe de patimit din cauza gimnasticii, in ciuda f...

VIRAL! Cea mai tare interpretare a unui hit celebru. Video amuzant :)))))
ph-online.ro - Prahova
Cea mai tare interpretare a unui hit celebru. Video amuzant :)))))

A cazut in cap si a decedat. Moartea stupida a unui barbat din cauza telefonului mobil
www.ziuaconstanta.ro - Constanţa
Moarte stupida in Petrosani. Un barbat si-a pierdut viata dupa ce a cazut in cap intr-un parau din centrul localitatii. El si-a scapat telefonul in apa, iar cand s-a aplecat dupa el s-a ...

Scriitorul Viorel Savin, cetăţean de onoare al Judeţului Bacău
www.desteptarea.ro - Bacău
Judeţul Bacău are, de astăzi, un nou cetăţean de onoare. Este vorba despre scriitorul Viorel Savin , cel care a primit această distincţie, într-un cadru festiv, în şedinţa ordinară a Consiliului Judeţean. Preşedintele Sorin Braşoveanu a precizat, în expunerea de motive, că fiecare ţinut are marile sale valori, iar în acest sens, judeţul nostru a …

Discuţii aprinse în Consiliul Judeţean. De la doctrine la bani!
www.desteptarea.ro - Bacău
Întâlnirea de la Centrul de Afaceri a consilierilor judeţeni nu a fost una liniştită, lucru previzbil, de altfel, având în vedere că pe ordinea de zi se aflau proiecte care împărţeau banii pentru anul 2018. Restul au fost despre cotizaţii, modificări ale unor hotărâri privind serviciile sociale, aprobarea indicatorilor pentru noua pistă şi amenajări în …

Lucrul de care Iliescu SE TEME CEL MAI TARE. LECȚIE pentru BARONII din PSD. „Sfântul Graal” al presei şi TALONUL Ninei Iliescu
evz.ro - Bucureşti
După ce EvZ a primit, ataşat unui „drept la replică” scris chiar de Nina Iliescu pe blogul fostului preşedinte, talonul de pensie, jurnalistul......

DESPĂRȚIRE INCREDIBILĂ în showbiz! „Regina fitnessului” a rămas FĂRĂ IUBIT: „A fost o relaţie frumoasă, dar…”
evz.ro - Bucureşti
Cori Grămescu, supranumită şi „Regina fitnessului”, s-a despărţit civilizat de iubitul ei, Călin Hagima. Anunţul a fost făcut în urmă cu puţin timp. ...

DECIZIE-BOMBĂ luată de o vedetă Antena 1. REVINE pe micul ecran cu o NOUĂ EMISIUNE
evz.ro - Bucureşti
După o lungă perioadă de absenţă, o îndrăgită prezentatoare de televiziune s-a decis să bucure din nou telespectatorii cu emisiunile sale. Deşi formatul......

PERCHEZIȚII LA PERSOANE BĂNUITE DE FRAUDE INFORMATICE
ziaruldevalcea.ro - Vâlcea
Poliţiştii Serviciului de Combatere a Criminalităţii Organizate Vâlcea, sub coordonarea D.I.I.C.O.T. – Biroul Teritorial Vâlcea, cu sprijinul Direcţiei Operaţiuni Speciale, au efectuat 9 perchezi…

ASR PRINCIPELE RADU AL ROMÂNIEI – DUBLĂ LANSARE DE CARTE REGALĂ LA CĂLĂRAŞI
www.soridapress.ro - Călăraşi
Curtea Veche Publishing vă invită joi, 22 februarie 2018, începând cu ora 15:40, la o dublă lansare de carte regală: albumul „Povestea Castelului Peleş” de ASR Principele Radu al României,

Procurorul Negulescu, carieră în comiterea de abuzuri. Dezvăluirile făcute de avocatul Gheorghe Piperea
ph-online.ro - Prahova
În urmă cu doi ani, procurorul Negulescu aproape că a băgat în faliment o companie mutinaţională, a declarat avocatul Pipera. Este vorba de celebrul d...

Eurodeputatul Daniel Buda, fost coleg cu Viorica Dăncilă în Comisia pentru Agricultură a PE: În curând românii vor deveni „căpşunari” la ei acasă!
www.ebihoreanul.ro - Bihor
Birocraţia pe care chiar autorităţile de la Bucureşti o amplifică aberant face ca agricultorii români să ajungă la fondurile UE mai greu decât toţi colegii din celelalte state, afirmă eurodeputatul Daniel Buda, membru în Comisia Agricolă a Parlamentului European. Aflat în turneu în şase judeţe din Transilvania pentru a se întâlni cu fermierii înaintea unei dezbateri vitale despre digitalizarea agriculturii europene, liberalul îi cere fostei colege de comisie, premierul Viorica Dăncilă, simplificarea condiţiilor în care românii pot accesa fondurile UE, avertizând că în caz contrar vor deveni si

Virusul care UCIDE tot mai mulţi oameni în România! S-a înregistrat O NOUĂ VICTIMĂ. Medicii sunt în ALERTĂ MAXIMĂ
evz.ro - Bucureşti
Un virus face victimă după victimă în România. Un tânăr de 28 de ani din Iaşi a murit, vineri, anunţă Centrul Naţional de Supraveghere şi Control al Bolilor...

Cronică din instanţă: Ponta şi Negoiţă au „făcut potecă” la Înalta Curte în locul şefilor PSD şi ALDE
evz.ro - Bucureşti
Victor Ponta şi Robert Negoiţă s-au prezentat, ieri, în instanţă, pentru a fi audiaţi în dosarele pe care şeful Senatului, Călin Popescu Tăriceanu, şi cel a...

LOVITURĂ DEFINITIVĂ pentru DRAGNEA
evz.ro - Bucureşti
Judecătorii de la Înalta Curte de Casaţie şi Justiţie au respins definitiv, vineri, contestaţia depusă de Tel Drum, prin care societatea cere ridicarea sech...

Expozitie foto emotionanta la Parcul Botanic din Timisoara
www.tion.ro - Timiş
Un proiect inedit care îndeamnă timişorenii să se oprească o clipă din tumultul vieţii şi să conştientizeze că fac parte dintr-o comunitate care are nevoie de implicarea fiecăruia! Acesta este mesajul transmis de expoziţia de fotografie „Sunt Aici!” care poate fi vizionată în Parcul Botanic de vineri, 16 februarie, până în 20 martie.

FOTO/VIDEO: Test auto pe Autostrada Sebeş-Turda, între nodurile Turda şi Aiud, pe loturile unde CNAIR tergiversează recepţia şi deschiderea
ziarulunirea.ro - Alba
Membrii Asociaţiei Pro Infrastructură au publicat un material video realizat vineri 16 februarie 2018, pentru a demonstra că Autostrada A10 între nodurile Turda şi Aiud este pregătită pentru a primi traficul rutier. Potrivit Asociaţiei, Compania Naţională de Administrare a Infrastructurii Rutiere tergiversează recepţia şi deschiderea a 28,75 km pe loturile 3 (Tirrena Scavi) şi 4 […]

Tinere, obligate sa se prostitueze pe Autostrada Soarelui. Suspectul, retinut de procurorii DIICOT
www.ziuaconstanta.ro - Constanţa
La data de 15.02.2018, procurorii Directiei de Investigare a Infractiunilor de Criminalitate Organizata si Terorism - Biroul Teritorial Calarasi au dispus retinerea pe o perioada de 24 de ore a ...

Un PEDOFIL din Bihor a VIOLAT, repetat, o FETIȚĂ de 12 ani. A fost arestat abia după ce MICUȚA a NĂSCUT
evz.ro - Bucureşti
Deşi procurorul şi avocatul au cerut încă din augut 2017 arestarea preventivă, respectiv arestul la domiciliu, instanţa a considerat că nu sunt probe şi l-a...

Gorghiu (PNL): CSM şi Inspecţia Judiciară să nu cedeze presiunilor din spaţiul politic
evz.ro - Bucureşti
Senatorul PNL, Alina Gorghiu, şi-a exprimat, vineri, speranţa în „scandalul
 www.infobraila.ro - Brăila
www.infobraila.ro - Brăila
Comentarii comentariu

Mara Darabus, poeta care l-ar face si pe Bacovia sa simta fiori pe spate
ziarmm.ro - Maramureş
„Galeria de arta sentimentala” este titlul volumului de debut al tinerei poete Mara Darabus. Baimareanca de origine, Mara studiaza psihologie, la Universitatea Babes-Bolyai, din Cluj-Napoca, o stiinta

FOTO: Percheziţii la persoane bănuite de braconaj cinegetic! Prejudiciul, estimat la 120.000 de euro!
www.zi-de-zi.ro - Mureş
Poliţiştii Serviciului Arme, Explozivi şi Substanţe Periculoase din cadrul Inspectoratului de Poliţi

Maria Darabus, poeta care l-ar face si pe Bacovia sa simta fiori pe spate
ziarmm.ro - Maramureş
„Galeria de arta sentimentala” este titlul volumului de debut al tinerei poete Mara Darabus. Baimareanca de origine, Mara studiaza psihologie, la Universitatea Babes-Bolyai, din Cluj-Napoca, o stiinta

Macaraua abandonata din zona peninsulara a Portului Tomis, demontata (galerie foto)
www.ziuaconstanta.ro - Constanţa
Macaraua, devenita simbol al zonei peninsulare din Portul Tomis, este demontata in aceste momente. Macaraua a fost lasata in paragina pe santierul abandonat la inceputul anilor 2000. De-a lungul ...

Liderul ALDE Alba, Ioan Lazăr, om de afaceri vechi în judeţ, întrebat dacă e afectat de Revoluţia Fiscală: Am cifră de afaceri sub un milion de euro şi plătesc impozit de 1%
ziarulunirea.ro - Alba
Liderul ALDE Alba, Ioan Lazăr, a fost întrebat, vineri, în cadrul unei conferinţe de presă, în condiţiile în care este un om de afaceri vechi din judeţ, dacă este afectat de Revoluţia Fiscală, el precizând că are cifră de afaceri sub un milion de euro şi plăteşte impozit de 1%. Astfel, el a spus că […]

IMAGINI INCREDIBILE! O femeie urcă pe BANDA aparatului de SCANAT din aeroport. Motivul este cel puţin BIZAR - VIDEO
evz.ro - Bucureşti
Pentru a fi sigură că angajaţii de securitate ai aeroportului nu îi fură ceva din bagaje, o femeie din China a luat o decizie extremă. ...

PROCURORUL „PORTOCALĂ”, călătorie INCOGNITO prin Drumul Taberei. NEGULESCU, întâlnire de gradul ZERO
evz.ro - Bucureşti
Deja arhicunoscut, fostul procuror Portocală a fost surprins în ultimele două zile într-o drumeţie prin cartierul Drumul Taberei, care pare că deja i-a......

Marius Nistor explică de ce au ÎNTÂRZIAT salariile la PROFESORI
evz.ro - Bucureşti
Se ştie deja că dascălii vor primi cu întârziere salariile şi în acestă lună. Reprezentanţii Sindicatului dau vina pe ordonanţa de urgenţă adoptată acum cât...

FSLI: „Cutremurător, mii de salariaţi din Educaţie cu probleme de sănătate sau în concediu de creştere a copilului, pierd venituri semnificative”
newsar.ro - Arad
Mii de angajaţi din Educaţie sunt afectaţi de prevederile Codului Fiscal, prin care a fost stabilită noua formulă de calcul a salariului acordat în timpul concediului medical. Astfel, potrivit calculelor făcute de Federaţia Sindicatelor Libere din Învăţământ, angajaţii din educaţie, aflaţi în concediu medical, pierd aproximativ 20 la sută din venit, din cauza noii formule

BARLOGUL LUI PORTOCALA – Procurorul Mircea Negulescu a fost prins de paparazzi. “Portocala” merge zilnic la un bloc in care locuiesc angajati din Ministerul Justitiei
ph-online.ro - Prahova
Exclus din magistratura pentru nenorocirile pe care le-a facut de-a lungul timpului, Mircea Negulescu, zis “Portocala” sau “Zdreanta” (foto)...

PE ONEA IL PASTE PARADEALA - Inspectia Judiciara a inceput ancheta la DNA Ploiesti
ph-online.ro - Prahova
Incepe dezastrul la unitate de elita a sefei DNA Laura Kovesi. Inspectia Judiciara a anuntat vineri, 16 februarie 2018, ca a inceput ancheta efec...

SUA si Turcia au convenit sa isi normalizeze relatiile
ziarmm.ro - Maramureş
Turcia si Statele Unite au decis "sa stabileasca mecanisme" pentru a-si normaliza relatiile, a anuntat vineri ministrul turc de externe Mevlut Cavusoglu, dupa saptamani in care retorica antiamericana

Sanziana Buruiana nu mai arata asa. Si-a tuns parul scurt si a renuntat la blond
ph-online.ro - Prahova
De cand a devenit mama, Sanziana Buruiana s-a schimbat complet. Dupa ce a renuntat la viata de noapte si s-a facut femeie de casa, Sanziana s-a hotara...

”Istoria spitalelor din Bistriţa”, vol. II: ”Istoria locală şi recursul la metodă”
www.timponline.ro - Bistriţa-Năsăud
”Monografia „Istoria spitalelor din Bistriţa”, vol. II, pe care autorii Mircea Gelu Buta şi Adrian Onofreiu au publicat-o la Editura Școala Ardeleană, Cluj-Napoca, la sfârşitul anului 2017, este o documentare riguroasă, corectă şi argumentată ştiinţific a importantului domeniu al sănătăţii publice d

SCANDAL INCREDIBIL la VÂRFUL PSD. Ponta despre Dragnea: „E PROST PE BUNE! Nu i-am făcut nimic!”
evz.ro - Bucureşti
Fostul premier Victor Ponta l-a jignit foarte dur pe liderul PSD Liviu Dragnea la ieşirea de la DNA, unde a fost audiat în dosarul Tel Drum....

Bilanţ la Parchetul Curţii de Apel Oradea: Prioritare au fost cazurile de corupţie, fraudă, evaziune şi contrabandă
www.ebihoreanul.ro - Bihor
Aproape 48.000 de dosare penale au fost anchetate anul trecut de procurorii din subordinea Parchetului de pe lângă Curtea de Apel Oradea, o importanţă majoră fiind acordată soluţionării cu celeritate a cazurilor de corupţie şi a fraudelor, dar şi... evitării erorilor judiciare.

Cine este tânăra care pretinde că a fost hărţuită de procurorul Bucurică
expressdebanat.ro - Caraş-Severin
Un uriaş scandal s-a abătut în ultima perioadă asupra Oraviţei după ce o localnică a apărut la postul de televiziune Antena 3 şi l-a acuzat pe procurorul George Bucurică de hărţuire sexuală.

Crearea unor produse inovative folosind tehnologia 3D
www.infobraila.ro - Brăila
Comentarii comentariu

Minori prinsi dupa ce au spart o biserica, o locuinta si doua magazine, in Timis
www.tion.ro - Timiş
Patru acuzaţii de furt calificat pe numele a doi tineri de 12 şi 16 ani, în Timiş. Ei sunt cercetaţi penal, după ce au fost prinşi că au furat bani, produse alimentare, ţigări şi alcool dintr-o biserică, un imobil şi două magazine.

„Soluţii complete de supraveghere video şi siguranţă activă”, un workshop pentru studenţii de la Facultatea de Inginerie Bacău
www.desteptarea.ro - Bacău
Facultatea de Inginerie din cadrul Universităţii „Vasile Alecsandri” din Bacău, în parteneriat cu UPC Business şi Direct Group, a organizat astăzi, 16 februarie, cu începere de la ora 11.00, un workshop despre prevenirea şi managementul riscurilor cu ajutorul sistemelor de supraveghere video. Evenimentul a avut loc în Sala BI 29 a Facultăţii de Inginerie. Cei …

Schimbare la programul casieriilor Teatrului Naţional Târgu-Mureş
www.zi-de-zi.ro - Mureş
Teatrul Naţional Târgu-Mureş îşi anunţă spectatorii că, începând de la 1 martie 2018, biletele şi ab

Justiţie pe mail. INFORMATIZAREA societăţii va aduce şi un lucru INIMAGINABIL ...
evz.ro - Bucureşti
Unul dintre membrii Consiliului Superior al Magistraturii, judecătorul Andrea Chiş a vorbit la Cluj, la şedinţa de bilanţ al Curţii de Apel Cluj, despre nev...

Guvernului României are în plan să dezvolte o reţea de benzinării. O parte vor fi amplasate în oraşe, iar restul pe şosele
ziarharghita.ro - Harghita
Operatiune de amploare a Guvernului Romaniei! Executivul are in plan sa dezvolte o retea de benzinarii. Construirea a cel putin 1.000 de astfel de statii d

Accident pe DN 1, la iesire din Azuga
ph-online.ro - Prahova
Un accident rutier s-a produs in urma cu putin timp pe DN 1, la iesire din Azuga, spre Predeal. Potrivit ISU Prahova, sunt implicate doua autoturisme,...

Inca o victima din cauza virusului gripal. Numarul deceselor a ajuns la 32
www.ziuaconstanta.ro - Constanţa
Institutul National de Sanatate Publica anunta ca, vineri, a fost confirmat inca un deces cauzat de virusul gripal, fiind vorba despre un barbat de 28 de ani, din judetul Iasi, nevaccinat antigripal, ...

ALERTĂ - Inspecţia Judiciară, control la DNA Ploieşti după înregistările lui Vlad Cosma
ph-online.ro - Prahova
Inspecţia Judiciară anunţă vineri, 16 februarie, că pe data de 12 februarie s-a sesizat din oficiu ca urmare a apariţiei în mass media a unor informaţ...

Klaus Iohannis, atacat DUR de la Bruxelles, după declaraţia de presă de la Cotroceni. A vrut doar sa arate ca s-a intors din vacanta
ph-online.ro - Prahova
Europarlamentarul Norica Nicolai lansează un atac la adresa lui Klaus Iohannis, după declaraţia de presă de la Cotroceni. Aceasta susţine că intervenţ...

Ion Cristoiu intervine în scandalul momentului: 'Șefa DNA a murit! S-a născut un om politic!'
ph-online.ro - Prahova
Jurnalistul Ion Cristoiu intervine în scandalul momentului, comentând într-o postare pe blogul personal conferinţa de presă susţinută de şefa DNA, Lau...

FOTO. Judeţul Satu Mare împlineşte astăzi 50 de ani
portalsm.ro - Satu Mare
Judeţul Satu Mare împlineşte astăzi 50 de ani. Să-i transmitem La Multi Ani!

Deputatul PSD Andrei Nicolae, invitat in emisiunea "Cu ochii pe tine", duminica, la Prahova TV
ph-online.ro - Prahova
Deputatul prahovean Andrei Nicolae (PSD) este invitatul special din aceasta saptamana al emisiunii "Cu ochii pe tine", difuzata duminica, la ora 17, p...

Ioan Lazăr: ALDE susţine fermierii şi agricultura. Apreciez munca angajaţilor de la APIA, care au un volum de muncă foarte mare
ziarulunirea.ro - Alba
Ioan Lazăr a declarat că ALDE va susţine în continuare fermierii, agricultura şi acordarea subvenţiilor, dar în acelaşi timp militează pentru simplificarea procedurilor şi pentru tot ceea ce vine în ajutorul celor din acest domeniu de activitate. În contextul modificărilor aduse legii Salarizării, Ioan Lazăr a spus că a aflat că veniturile angajaţilor de APIA […]

Raeţchi, ATAC la Carmen Dan: ”E INCOMPETENTĂ! Să-şi dea DEMISIA!”
evz.ro - Bucureşti
În condiţiile în care veniturile a nu mai puţin de 8000 poliţişti s-au trezit cu salariile reduse semnificativ, iar Poliţia se confruntă cu o drastică criză de personal specializat, ministrul Internelor, Carmen Dan, ar trebui să îşi înainteze demisia, din raţiuni de incompetenţă, susţine deputatul PNL Ovidiu Raeţchi, potrivit unui comunicat remis redacţiei....

Aproape 30.000 de locuri de muncă neocupate în toată ţara. Vezi câte sunt la Cluj şi ce posturi oferă angajatorii
www.stiridecluj.ro - Cluj
Potrivit datelor Agenţiei Naţionale pentru Ocuparea Forţei de Muncă (ANOFM), la nivel ...

Cine sunt miliardarii din tranzacţii cu BITCOIN şi alte cryptomonede
www.stiridecluj.ro - Cluj
Cine sunt miliardarii din tranzacţii cu BITCOIN şi alte cryptomonede

Un alt român a murit din cauza gripei. Virusul a răpus 32 de persoane
www.stiridecluj.ro - Cluj
Bilanţul deceselor cauzate de gripă în România continuă să cească...

E-Distributie Dobrogea intrerupe furnizarea energiei electrice in judetul Constanta pentru efectuarea unor lucrari. Localitati afectate
www.ziuaconstanta.ro - Constanţa
Pentru lucrarile anuale de reparatii si intretinere instalatii si retele electrice, precum si posturi de transformare, SC E- Distributie Dobrogea SA - Zona MT-JT Constanta, anunta intreruperea ...

19 ani şi o alcoolemie de 0,59 la mie. Cum a fost data de gol o şoferiţă de o banală bordură
www.desteptarea.ro - Bacău
La data de 15 februarie a.c., în jurul orei 19.30, poliţiştii rutieri au fost sesizaţi cu privire la producerea unui eveniment rutier pe strada Milcov din Bacău. Din primele cercetări efectuate la faţa locului a rezultat că o tânără de 19 ani, din comuna Stănişeşti, în timp ce conducea un autoturism pe strada Alecu Russo, …

Autostrada Sebeş – Turda, nodul rutier Sebeş: a primit autorizaţie de construire. 75 de milioane lei şi 18 luni termen de execuţie, pentru italienii de la Pizzarotti
ziarulunirea.ro - Alba
Autostrada Sebeş-Turda, lotul 1, nodul rutier Sebeş, a primit autorizaţie de construire, fapt care permite deblocarea lucrărilor în acest loc. 75 de milioane şi 18 luni termen, conform autorizaţiei. În mod normal, la finalul lui 2019 lucrările ar trebui să fie gata. Ministerul Transporturilor a emis vineri, 16 februarie, Autorizaţia de Construire pentru Nodul Sebeş de pe […]

DEMISIE-ȘOC în REPUBLICA MOLDOVA! Primarul din CHIȘINĂU cere ALEGERI anticipate
evz.ro - Bucureşti
Dorin Chirtoacă a anunţat, vineri, că renunţă la funcţia de primar general al municipiului Chişinău din Republica Moldova. Gestul lui, anunţat în cadrul......

INCIDENT BIZAR în Rusia! Ambasadele străine de la Moscova au primit PLICURI SUSPECTE cu PRAF ALB
evz.ro - Bucureşti
Ambasadele Franţei, Republicii Cehe, Olandei Poloniei din Rusia, dar şi altele, au primit prin poştă mai multe plicuri care conţineau un praf alb. ...

Incurajarea investitiilor si crearea de noi locuri de munca, printre prioritatile Guvernului. Ce spune vicepremierul Paul Stanescu
www.ziuaconstanta.ro - Constanţa
Guvernul Romaniei incurajeaza investitiile in Romania si isi propune ca obiectiv cresterea competitivitatii economice si imbunatatirea conditiilor de viata ale comunitatilor locale si ...

Intervenţie dificilă a pompierilor cărăşeni. Pagubă de 100.000 de lei după ce două case au fost cuprinse de flăcări
expressdebanat.ro - Caraş-Severin
Două gospodării din Caransebeş au fost distruse de flăcări noaptea trecută. Incendiul a fost observat târziu, aşa că pagubele sunt însemnate. Cele două familii au pierdut bunuri în valoare totală de 100.000 de lei. La Caransebeş s-a dat alarma noaptea trecută, după ora 1. Două gospodării învecinate de pe strada Nicolae Titulescu ardeau ca o…

Bărbat cercetat de poliţişti pentru braconaj cinegetic
www.desteptarea.ro - Bacău
La data de 15 februarie a.c., poliţiştii Serviciului Arme, Explozivi, Substanţe Periculoase au depistat un bărbat de 30 de ani, în timp ce trasporta un porc mistreţ fără documente legale. Din verificările poliţiştilor a rezultat că bărbatul ar fi capturat animalul cu ajutorul unui laţ, pe raza comunei Faraoani şi îl transporta la domiciliu pentru …

Concurs pentru elevii din Timis. Cei care recicleaza si fac actiuni ecologice castiga biciclete si laptopuri
www.tion.ro - Timiş
S-a dat startul înscrierilor la concursul ”Școala Zero Waste”. Dacă prin acţiunile lor, elevii din Timiş şi din alte părţi ale ţării dovedesc că încurajează un comportament ecologic şi fac tot felul de „minunăţii” cu materialele reciclabile, atunci au şansa de a câştiga premii consistente – de la laptopuri la biciclete şi tablete.

Patriarhia Română: Interdicţia filmărilor în Biserică NU se referă la BOTEZURI şi CUNUNII
www.stiri-neamt.ro - Neamţ
Patriarhia Română a venit, vineri (16 februarie), cu precizări după ce Sfântul Sinod a stabilit ca: „filmările în lăcaşurile de cult vor fi realizate doar

DIICOT. Grup infractional organizat, retinut pentru trafic international de droguri de mare risc
www.ziuaconstanta.ro - Constanţa
La data de 16.02.2018, procurorii Directiei de Investigare a Infractiunilor de Criminalitate Organizata si Terorism DIICOT Biroul Teritorial Arad au dispus retinerea pentru o perioada de 24 de ore a ...

Tamponare pe fondul consumului de alcool
www.desteptarea.ro - Bacău
La data de 15 ianuarie a.c, în jurul orei 18.00, poliţiştii rutieri au fost sesizaţi cu privire la producerea unui eveniment rutier soldat cu pagube materiale. Din cercetări a rezultat că, un bărbat de 40 de ani, din comuna Letea-Veche, în timp ce conducea un autoturism pe strada Garofiţei din Bacău, nu a acordat prioritate …

Modificări de trafic pe 21 Decembrie 1989
www.stiridecluj.ro - Cluj
Modificări de trafic pe 21 Decembrie 1989

Cristian Niculescu Tagarlas: “Am blocat initiativa Guvernului PSD de acaparare a bazelor sportive din Baia Mare”
ziarmm.ro - Maramureş
In cadrul sedintei extraordinare de vineri, 16 februarie, a Consiliului Local Baia Mare, alesii au votat impotriva cedarii catre stat a mai multor baze sportive din municipiu. Consilierul local libera

Inspecţia Judiciară a CSM s-a SESIZAT din oficiu. Verifică DEZVĂLUIRILE lui Vlad Cosma despre DNA Ploieşti şi procurorul „Portocală”
evz.ro - Bucureşti
Inspecţia Judiciară a Consiliului Superior al Magistraturii s-a sesizat din oficiu în legătură cu afirmaţiile şi înregistrările făcute publice de fostul......

Episcopul Melchisedec Ștefănescu, pomenit la Catedrala Arhiepiscopală din Roman
www.stiri-neamt.ro - Neamţ
În data de 15 februarie a.c. la împlinirea a 195 de ani de la naşterea vrednicului de pomenire Ierarh Melchisedec Ștefănescu, la Catedrala Arhiepiscopală „

Constanta. Zona Faleza Sud, ecologizata de politistii locali si angajatii Polaris
www.ziuaconstanta.ro - Constanţa
Politistii locali din cadrul Directiei Generale Politia Locala impreuna cu reprezentanti ai societatii de salubrizare SC Polaris M. Holding continua actiunea de ecologizare din zona Faleza Sud si ...

Locuri de muncă în străinătate, pentru români: Peste 800 de oferte disponibile, cele mai multe în Spania, Malta şi Germania
ziarulunirea.ro - Alba
În această săptămână, angajatorii din Spaţiul Economic European pun la dispoziţia lucrătorilor români, prin intermediul reţelei Eures, 823 de locuri de muncă, cele mai multe în Spania, Malta şi Germania. Potrivit datelor centralizate de Agenţia Naţională pentru Ocuparea Forţei de Muncă (ANOFM), în Spania sunt disponibile 161 de locuri de muncă pentru agricultori, în Malta […]

Zeci de persoane, majoritatea copii, cu hepatita A la Gheorgheni
ziarharghita.ro - Harghita
Agenţia MEDIAFAX transmite că aproape 30 de pacienţi, majoritatea copii, dintr-o comunitate vulnerabilă din municipiul Gheorgheni, au fost internaţi în spi

Cercetatorul stiintific Sorin-Marcel Colesniuc este noul director al Muzeului de Istorie Nationala si Arheologie Constanta
www.ziuaconstanta.ro - Constanţa
Noul director al Muzeului de Istorie Nationala si Arheologie Constanta MINAC este cercetatorul stiintific dr. Sorin Marcel Colesniuc. Conform datelor afisate pe site-ul CJC, el a obtinut nota finala ...

De unde şi când vor putea arădenii cumpăra MĂRȚIȘOARE şi flori de 8 Martie
newsar.ro - Arad
Citeşte azi ce scriu ziarele de mâine!

Primarul George Scupra, replica edilului Fagadau Suntem onorati ca simte nevoia sa compare investitiile din Constanta cu cele din Ovidiu“
www.ziuaconstanta.ro - Constanţa
Ziele trecute, in contexul unei conferinte de presa, Bogdan Hutuca, presedintele PNL Constanta, a declarat ca municipiul Constanta are un buget de supravietuire si ca investitorii aleg sa-si ...

DRAGOBETE – CAP DE PRIMAVARA
www.infobraila.ro - Brăila
Comentarii comentariu

Acţiuni pentru verificarea sistemelor de securitate
www.zi-de-zi.ro - Mureş
În ultimele două săptămâni, în urma acţiunilor desfăşurate în domeniul verificării sistemelor de sec

Directia Generala de Asistenta Sociala si Protectia Copilului Constanta organizeaza concurs pentru ocuparea urmatoarelor functii publice de executie vacante
www.ziuaconstanta.ro - Constanţa
Directia Generala de Asistenta Sociala si Protectia Copilului Constanta organizeaza concurs, in baza H.G. nr. 611 2008 modificata prin H.G. nr. 761 2017, in perioada 20.03.2018 - 23.03.2018, astfel ...

Fostul ministru al Turismului, Elena Udrea, reactioneaza dupa ce au aparut informatii ca ar fi plecat in Costa Rica. Ce a transmis aceasta
www.ziuaconstanta.ro - Constanţa
Dupa ce in presa au aparut informatii conform carora fostul ministru al Turismului, Elena Udrea ar fi plecat din tara si s-ar afla in Costa Rica, aceasta a postat un mesaj pe contul sau de Facebook ...

Patriarhia precizează: INTERDICŢIA filmărilor în Biserică NU se referă la BOTEZURI şi CUNUNII
evz.ro - Bucureşti
Hotărârea Sfântului Sinod care prevede că filmările în lăcaşurile de cult vor fi realizate doar cu acordul Centrelor eparhiale nu se referă la înregistrăril...

FRICA de RĂZBOI NUCLEAR, la COTE MAXIME în SUA. Strategia „nas însângerat”, REVOCATĂ. Administraţia TRUMP caută SOLUȚII de CRIZĂ
evz.ro - Bucureşti
Senatorii ambelor partide american, dar şi un oficial al administraţiei Trump, au negat speculaţiile cu privire la un atac de tip „nas însângerat” împotriva...

Inspecţia Judiciară a CSM s-a SESIZAT din oficiu. Verifică DEZVĂLUIRILE lui Vlad Cosma despre DNA Ploieşti şi procurorul „Portocală”
evz.ro - Bucureşti
Inspecţia Judiciară a Consiliului Superior al Magistraturii s-a sesizat din oficiu în legătură cu afirmaţiile şi înregistrările făcute publice de fostul......

Povestea unei familii de campioni, la Colegiul Naţional „Ştefan cel Mare“ din Târgu Neamţ
www.stiri-neamt.ro - Neamţ
Colegiul Naţional „Ştefan cel Mare“ din Târgu Neamţ a găzduit a cincea întâlnire în cadrul proiectului „Campionii României în şcoală, liceu şi universitate

Întăriri pentru formaţia lui Bicheşi: italianul de Marco, portarul Ciuperceanu (Gaz Metan Mediaş) şi mijlocaşul Ignat au semnat până în vară cu Unirea Alba Iulia
ziarulunirea.ro - Alba
Unirea Alba Iulia a reuşit să înregimenteze trei jucători noi, care vor fi puşi la dispoziţia antrenorului Adrian Bicheşi în retur. Este vorbaîn primul rând despre italianul Marco De Marco (21 de ani, Crotone), care a semnat până la finele campionatului, mijlocaşul fiind în pregătiri încă de la reluarea antrenamentelor. Acestuia i se mai adaugă […]

Scrisoare deschisă catre Primăria Sibiu: Faceţi o sală polivalentă de minim 4.000 de locuri!
www.oradesibiu.ro - Sibiu
Cele mai mari cluburi sportive din Sibiu, Directia Judeteana pentru Sport si Tineret, cluburi scolare si asociatii de profil au depus astazi, in atentia Primariei Municipiului Sibiu, un memoriu cu…

Ce spune IJP Prahova despre descinderile din Bucuresti, unde politistii au gresit adresa si aproape au spart usa apartamentului
ph-online.ro - Prahova
În urma aparitiei în spaţiul public a unor comentarii legate de o percheziţie domiciliara efectuată ieri de poliţiştii prahoveni în municipiul Bucureş...

"Meciul" continuă: Vicepreşedintele Ioan Mang spune că liberalii încearcă să şantajeze conducerea Consiliului Judeţean
www.ebihoreanul.ro - Bihor
Vicepreşedintele Consiliului Judeţean Bihor, Ioan Mang, a ieşit, vineri, într-o conferinţă de presă în care a răspuns, în bună măsură, acuzaţiilor aduse cu o zi înainte de liderii PNL Bihor, Ilie Bolojan şi Ionel Avrigeanu. Mang a spus că ceea ce fac PNL-iştii este un 'şantaj' şi că, de fapt, consilierii liberali ar fi absentat de la şedinţa de joi deoarece unul dintre aleşi este în vacanţă la schi şi, astfel, puterea l-ar fi putut valida pe PSD-istul Adrian Szatmari.

Traficanţi de DROGURI din TIMIȘ, prinşi de poliţiştii arădeni. Au fost CONFISCATE droguri de SUTE DE MII de lei
newsar.ro - Arad
Citeşte azi ce scriu ziarele de mâine!

Managerul Serviciului de Ambulanţă Alba, despre ambulanţierul care a transportat în spate pacienta din Apuseni: Nu riscă nicio sancţiune. Nu va fi o anchetă, am vrut să aflu ce s-a întâmplat
ziarulunirea.ro - Alba
Managerul Serviciului de Ambulanţă Judeţean (SAJ) Alba, Marius Șuluţiu, a declarat, vineri, despre că ambulanţierul Dumitru Ignat, nu va fi pedepsit pentru că a făcut o faptă bună, iar în acest caz nu se va derula o anchetă, ci a cerut doar o notă explicativă pentru a afla cum s-au petrecut evenimentul despre care a […]

Bilantul activitatilor Politiei Romane din anul 2018. Aproximativ 1,6 milioane de dosare penale au fost intocmite
www.ziuaconstanta.ro - Constanţa
Activitatea Politiei Romane se axeaza permanent pe indeplinirea principalului obiectiv - siguranta comunitatii. Anul trecut, politistii au gestionat 740.000 de interventii la solicitarile prin 112, au ...

Ministrul Apararii Nationale: O noua baza aeriana va fi construita la Mihail Kogalniceanu, in judetul Constanta
www.ziuaconstanta.ro - Constanţa
Ministerul Apararii intentioneaza sa construiasca o noua baza aeriana la Mihail Kogalniceanu, in judetul Constanta, informeaza EuropaFM.ro. De asemenea, actuala baza, operata de Armata SUA, ...

Spitalul Judeţean de Urgenţă Constanţa, supraaglomerat
evz.ro - Bucureşti
Cea mai marte unitate spitalicească din Dobrogea, Spitalul Clinic Judeţean de Urgenţă “Sf. Apostol Andrei”
Constanţa, a avut, anul trecut, 55.560 pacienţi...

Ambulanţierul din Apuseni care a cărat o pacientă în spate, pus să dea notă explicativă
www.stiridecluj.ro - Cluj
Ambulanţierul din Apuseni care a cărat o pacientă în spate, pus să dea notă explicativă

Precizare importanta privind filmarile in lacasurile de cult ale Bisericii Ortodoxe Romane
www.ziuaconstanta.ro - Constanţa
Potrivit reprezentantilor Bisericii Ortodoxe Romane, hotararea din 15 februarie 2018 a Sfantului Sinod care stabileste ca filmarile in lacasurile de cult vor fi realizate doar cu acordul Centrelor ...

Vanzare casa si teren intravilan in Sighetu Marmatiei – Extras publicatie imobiliara, din data de 16. 02. 2018
ziarmm.ro - Maramureş
Noi, Societatea Civila Profesionala de Executori Judecatoresti Morari si Asociatii cu sediul in loc. Baia Mare, str. George Cosbuc, nr. 25A, ap. 10, jud. Maramures, prin executor judecatoresc Iosif-Ni

Neamţ: O măicuţă a terorizat un microbuz. O fetiţă de 12 ani a ajuns la spital cu atac de panică
www.stiri-neamt.ro - Neamţ
O măicuţă a terorizat o copilă de 12 ani, într-un microbuz cu care fata se întorcea de la şcoală. Incidentul s-a petrecut joi, 15 februarie, pe raza comune

Denisa Stoian, felicitată de Irina Deleanu
ph-online.ro - Prahova
Ziua de ieri a fost una perfectă pentru Denisa Stoian, gimnasta Clubului Sportiv Municipal Ploieşti reuşind ca, după obţinerea calificării pentru Jocu...

Dorin Chirtoaca a demisionat din functia de primar general al municipiului Chisinau
www.ziuaconstanta.ro - Constanţa
Dorin Chirtoaca a anuntat vineri - intr-o conferinta de presa - ca isi da demisia din functia de primar general al municipiului Chisinau in semn de protest si a cerut organizarea de alegeri ...

Vanzare casa si teren intravilan in Zalau – Extras publicatie imobiliara, din data de 16. 02. 2018
ziarmm.ro - Maramureş
Noi, Societatea Civila Profesionala de Executori Judecatoresti Morari si Asociatii cu sediul in loc. Baia Mare, str. George Cosbuc, nr. 25A, ap. 10, jud. Maramures, prin executor judecatoresc Iosif-Ni

În ţara lui Babeş-Papanicolau, aproape 2.000 de românce sunt ucise, anual, de cancerul de col uterin – În Teleorman, 83 de noi cazuri au fost diagnosticate în 2017
ziarulteleormanul.ro - Teleorman
Ca ţară, suntem pe primele locuri în cele mai negative topuri, iar bolile n-ar fi putut face excepţie. Aşa că, România este poziţionată, din păcate, pe primul loc în Europa la incidenţa cancerului de col uterin, peste 4.000 de românce fiind diagnosticate anual cu această boală, în timp ce 2.000 sunt răpuse de maladie. Incidenţa şi mortalitatea sunt de patru ori peste media europeană, potrivit reprezentanţilor Institutului Naţional de Sănătate Publică (INSP). În Teleorman, în evidenţele Direcţiei de Sănătate Publică (DSP), la finalul anului 2017 erau înregistrate 147 de paciente diagnosticate c

Valentin Trăistaru, primarul comunei Buzescu: “Sistemul meu de comunicare este unul şi acelaşi cu toţi locuitorii comunei”
ziarulteleormanul.ro - Teleorman
– Domnule primar Valentin Trăistaru, comuna Buzescu este deja cunoscută şi arhicunoscută, chiar şi peste hotare. De ştiut, se ştie de ce. Interesant ar fi de aflat cum reuşiţi dumneavoastră să comunicaţi, practic, cu cele două etnii, romă şi română, din unitatea administrativ-teritorială al cărei edil şef sunteţi? – Da, interesantă întrebare, nimeni, din cei care au trecut pe aici, nu a avut această curiozitate, toţi s-au oprit la aşa-zisele palate şi la cei care le-au construit şi locuiesc în asemenea case. Ce pot eu să vă spun este că nu sunt nici impresionat, şi nici intimidat.

Mai multe zone din Constanta vor ramanesaptamana viitoare fara apa. Masura luata pentru efectuarea unor lucari RAJA
www.ziuaconstanta.ro - Constanţa
Pentru executarea unor lucrari de modernizare a conductelor de apa potabila din subsolurile blocurilor situate in diferite zone ale municipiului Constanta, RAJA va intrerupe furnizarea apei potabile in ...

In fata Garii CFR: Iata ce a fost nevoit sa faca soferul unui autobuz pentru a ocoli o masina parcata dupa ureche“
www.ziuaconstanta.ro - Constanţa
Ce a fost nevoit sa faca soferul unui autobuz pentru a ocoli o masina parcata dupa ureche ...

CNCD s-a autosesizat privind declaraţia premierului Dăncilă despre autişti
www.stiridecluj.ro - Cluj
Consiliul Naţional pentru Combaterea Discriminării s-a autosesizat în ceea ce ...

Biserica interzice filmările în biserici, la nunţi
www.stiridecluj.ro - Cluj
Biserica interzice filmările în biserici, la nunţi

Bihorenii au dominat întrecerile Cupei Vulturul Negru la tenis
www.ebihoreanul.ro - Bihor
Ediţia din acest an a Cupei Vulturul Negru la tenis de câmp, competiţie care s-a desfăşurat la baza sportivă de lângă Arena Antonio Alexe, i-a avut ca protagonişti pe sportivii bihoreni, care şi-au adjudecat patru din cele opt categorii.

REVOLUȚIA CONTINUĂ. Femeile FĂRĂ SUTIEN au revenit MAI DOTATE ca niciodată. Ce pun divele goale la cale – GALERIE FOTO
evz.ro - Bucureşti
După ce anul trecut a fost descoperit un club creat de femeile care nu poartă sutien, anul acesta se pare că divele goale şi-au mărit ”familia”....

DEMISIE la POȘTĂ. De ce nu se poate FACE bine compania POȘTA ROMÂNĂ
evz.ro - Bucureşti
Guvernul României va amâna, probabil, din nou capitalizarea companiei Poşta Română, după ce Elena Petraşcu, director general al Companiei Naţionale Poşta Ro...

FOTO. Descinderi ale poliţiştilor în cuibul infracţional de pe Horea 6
portalsm.ro - Satu Mare
Descinderi ale poliţiştilor în cuibul infracţional de pe Horea 6

CSM Bacău are de astăzi un nou website
www.desteptarea.ro - Bacău
Noul site al Clubului Sportiv Municipal Bacău a fost lansat astăzi. Acesta are un design compatibil şi cu dispozitivele mobile, noi funcţionalităţi şi o nouă adresă – www.csmbacau.ro Prin noul site, susţinătorii CSM Bacău vor putea fi la curent cu următoarele evenimente sportive ce vor avea loc, clasamente, atât de la Handbal cât şi de …

Bărbat din Alba Iulia condamnat şi încarcerat pentru pornografie infantilă, după ce a postat un film indecent pe internet
ziarulunirea.ro - Alba
Muntean Marin Ioan, un bărbat de 52 de ani din Alba Iulia a fost condamnat şi încarcerat în Penitenciarul Aiud, pentru pornografie infantilă, după ce a postat un film indecent pe internet. Decizia definitivă a fost pronunţată la Curtea de Apel Alba Iulia în 13 februarie 2018. Muntean Marin Ioan a primit pedeapsda de 2 […]

Util! Angajatorii sunt obligaţi să elibereze un anumit document la solicitarea angajaţilor
ziarharghita.ro - Harghita
Inspectoratul Teritorial de Muncă - Harghita, informează că potrivit unei hotărâri privind registrul general de evidenţă a salariaţilor, la solicitarea scr

FOTO. Razie de amploare a poliţiştilor pe strada Botizului. Șoferi prinşi băuţi la volan
portalsm.ro - Satu Mare
Razie de amploare a poliţiştilor pe strada Botizului. Șoferi prinşi băuţi la volan

CANCERUL a suferit O MUTAȚIE PERICULOASĂ. Oamenii de ştiinţă AVERTIZEAZĂ! Femeile, mai EXPUSE ca NICIOADATĂ
evz.ro - Bucureşti
Cercetătorii americani susţin că au identificat o mutaţie genetică nouă care poate duce la creşterea riscului de apariţie al cancerului
ovarian. ...

Duel 100% academic. ASU Politehnica Timisoara si U Cluj vor ridica tribunele in picioare
www.tion.ro - Timiş
Două echipe cu un parcurs în ultimii ani destul de asemănător, cu suporteri numeroşi, vor oferi sâmbătă timişorenilor un frumos spectacol amical. Pe Stadionul „Știinţa” se vor întâlni ASU Politehnica Timişoara şi Universitatea Cluj, formaţiile apărute în fotbalul actual în urma unor proiecte de tip „socios”, susţinute de fani şi de mediul universitar.

Dezbatere la Primaria Constanta. Este discutat Regulamentul de acordare a finantarii nerambursabile pentru proiecte de interes general finantate din bugetul municipiului Constanta“
www.ziuaconstanta.ro - Constanţa
Primaria municipiului Constanta organizeaza astazi dezbaterea publica privind Regulamentul de acordare a finantarii nerambursabile pentru proiecte de interes general finantate din bugetul municipiului ...

Recomandări utile pentru copii care utilizează internetul
www.zi-de-zi.ro - Mureş
Peste 150 de elevi au beneficiat deja de informaţiile oferite de poliţiştii mureşeni prevenire în Ca

Dancila: Este nevoie de un proiect de reformare a Politiei, de proceduri clare si eficiente in lupta impotriva infractorilor
ziarmm.ro - Maramureş
Premierul Viorica Dancila a declarat, vineri, ca este nevoie de un proiect de reformare a Politiei Romane, dupa ce, anul trecut, institutia s-a confruntat cu unele cazuri "grave" care au pus in perico

FOTO&VIDEO. Accident mortal în Satu Mare. Poliţiştii au stabilit cum s-a întâmplat totul
portalsm.ro - Satu Mare
Accident mortal în Satu Mare. Poliţiştii au stabilit cum s-a întâmplat totul

Liderul PSD Alba, Ioan Dîrzu: Proiecte de peste 8 milioane de lei pentru judeţul Alba dedicate Centenarului Marii Uniri
ziarulunirea.ro - Alba
În calitate de membru al Comisiei speciale comune a Camerei Deputaţilor şi Senatului pentru celebrarea Centenarului Marii Uniri şi a Războiului pentru întregirea Neamului sunt onorat să anunţ că judeţul Alba va avea 70 de proiecte dedicate Centenarului Marii Uniri şi finanţate cu peste 8 milioane de lei din bugetul de stat. Ministerul Culturii şi […]

Pintea: Sper sa nu mai auzim de bani dati de pacienti personalului medical dupa majorarea salariala de la 1 martie
ziarmm.ro - Maramureş
Ministrul Sanatatii, Sorina Pintea, a afirmat joi seara ca dupa majorarile salariale de la 1 martie spera sa nu mai auda de bani dati de pacienti personalului medical, cresterea salariilor fiind un pa

Retur dificil pentru calificarea în „careul de aşi” la popice
www.zi-de-zi.ro - Mureş
Echipa feminină de popice Electromureş Romgaz Târgu-Mureş va susţine sâmbătă, 17 februarie, de la or

Distrugătorul USS Ross, escală în portul Constanţa
evz.ro - Bucureşti
O navă militară americană, distrugătorul USS Ross, va ancora în portul Constanţa pentru a participa la activităţi
comune cu Forţele Navale Române. ...

Contrabandisti de tigari prinsi de politisti in timpul unei actiuni, la Lugoj
www.tion.ro - Timiş
Acuzaţii de contrabandă pe numele a doi bărbaţi de 43 şi 58 de ani, la Lugoj. Aceştia sunt cercetaţi de poliţişti, după ce au fost prinşi că aveau asupra lor mai multe cartuşe cu ţigări netimbrate. Marfa a fost confiscată.

Atentie la ofertele speciale de pe site-uri de cumparaturi online. Cum au reusit doi barbati sa pacaleasca mai multi cumparatori
www.ziuaconstanta.ro - Constanţa
La data de 15.02.2018 procurorii Directiei de Investigare a Infractiunilor de Criminalitate Organizata si Terorism Biroul Teritorial Valcea au dispus retinerea pentru o perioada de 24 de ore a ...

SCANDAL în parcarea unui COMPLEX COMERCIAL din Arad
newsar.ro - Arad
Citeşte azi ce scriu ziarele de mâine!

Programul filmelor care rulează la Centrul Cultural Dacia din Bistriţa, 16-22 februarie
www.timponline.ro - Bistriţa-Năsăud
(TRAILERE) Iată ce filme puteţi urmări în Sala de cinema ”Adrian Pintea” a Centrului Cultural Dacia de pe Bd. Decebal din Bistriţa în perioada 16-22 februarie: Firul fantomă, Casa spiritelor, Pantera neagră, Tare ca piatra, Cincizeci de umbre descătuşate, Forma apei.
Puteţi rezerva şi cumpăra bil

Aparatul RMN şi Computerul Tomograf ar putea fi funcţionale începând cu luna aprilie
ziarulteleormanul.ro - Teleorman
Spitalul Judeţean de Urgenţă Alexandria va fi dotat, în perioada următoare, cu un Computer Tomograf, un Aparat de Rezonanţă Magnetică şi un sistem informatic PACS, contractele de achiziţionare pentru echipamentele medicale fiind semnate la începutul lunii trecute. Acestea ar urma să fie funcţionale începând cu luna aprilie, potrivit preşedintelui Consiliului Judeţean Teleorman, Dănuţ Cristescu. Prin dotarea Spitalului Judeţean de Urgenţă din Alexandria cu cele trei echipamente de imagistică, se vor asigura condiţii optime actului medical şi se va asigura, totodată, accesul cetăţenilor la servi

CJ Harghita anunţă organizarea unui concurs cu miza de 300 de mii de lei
ziarharghita.ro - Harghita
Consiliul Judeţean Harghita anunţă organizarea concursului de proiecte destinat asociaţiilor pompierilor voluntari sau persoanelor juridice fără scop patri

Sâmbătă, amical interesant sub Drăgana între conjudeţene: Metalurgistul Cugir – Industria Galda | Boancă şi Rodean, sub comanda lui Ciucă şi în retur
ziarulunirea.ro - Alba
Sâmbătă, de la ora 11.00, pe Stadionul „Parc” se dispută unicul amical al iernii între conjudeţenele din eşalonul terţ, Metalurgistul Cugir urmând să întâlnească Industria Galda, într-o partidă ce se anunţă atractivă. Formaţia lui Călin Moldovan este invincibilă în jocurile de pregătire, iar găldenii au pierdut un singur meci, săptămâna trecută, în deplasare, cu „U” […]

Întărirea autorităţii angajaţilor MAI, printre prioriţăţile Guvernului Dăncilă
evz.ro - Bucureşti
Nevoia realizării unui proiect de reformare a Poliţiei Române, după ce, anul trecut, instituţia s-a confruntat cu unele cazuri „grave...

iOS 11.2 aduce incarcarea wireless rapida pentru iPhone X
www.tion.ro - Timiş
ADVERTORIAL. Apple continuă seria de îmbunătăţiri ale sistemului de operare mobil şi, prin lansarea iOS 11.2, aduce o funcţie mult aşteptată de către fanii noului iPhone X. Încărcarea wireless a funcţionat din prima zi, însă aceasta a fost limitată la numai 5W. Acest lucru a pus noul iPhone X fix în coada clasamentului, când vine vorba de viteza de încărcare.

RADET Constanta. Mai multi abonati din Constanta au ramas fara apa calda si caldura. Ce zone sunt afectate
www.ziuaconstanta.ro - Constanţa
E- Distributie Dobrogea a comunicat in data de 16.02.2018 ca inregistreaza o avarie pe reteaua care alimenteaza cu energie electrica punctul termic nr. 9. In consecinta, in lipsa curentului electric ...

CCR: Nu se justifica un regim juridic mai favorabil privind suspendarea in cazul functionarilor publici trimisi in judecata
ziarmm.ro - Maramureş
Nu este justificata crearea unui regim juridic mai favorabil privind suspendarea raportului de serviciu in cazul functionarilor publici trimisi in judecata, potrivit motivarii deciziei prin care Curte

Primăria cumpără Hotelul Central dar cu anumite condiţii
www.desteptarea.ro - Bacău
Consiliul local al municipiului Bacău a aprobat, ieri, exercitarea dreptului de preempţiune pentru achiziţia Hotelului Central, monument istoric, aflat deasupra Teatrului Bacovia. La propunerea primarului Cosmin Necula, s-a decis că exercitarea dreptului de preempţiune să se facă în anumite condiţii: firma lichidatoare care se ocupă de societatea ce deţine hotelul să pună la dispoziţia Consiliului …

UEFA, cea mai DRASTICĂ SANCȚIUNE aplicată vreodată unei echipe!
evz.ro - Bucureşti
Forul european a fost nemilos la adresa unui club găsit vinovat pentru trucarea de jocuri....

AFLĂ SECRETUL celor mai performante sisteme de sonorizare şi adresare publică disponibile în România (P)
evz.ro - Bucureşti
O conferinţă de success, indiferent de numarul de invitaţi sau de mărimea publicului, presupune o organizare în cel mai mic detaliu....

Opţiuni multiple în alegerea unei pompe submersibile eficientă
feeds.monitorulsv.ro - Suceava
Echipamente esentiale in bunul mers al gospodariilor, pompele submersibile se gasesc pe piata intr-o varietate de modele, fiind dedicate unei game largi de lucrari casnice.

Polonic, incendiatorul Pensiunii La Dolce Vita, reţinut pentru viol
feeds.monitorulsv.ro - Suceava
Ultima ora: Un recidivist din Brosteni, Petrica Mandrila, zis Polonic, condamnat in mai multe dosare penale, printre care si cel privind incendierea pensiunii La Dolce Vita din Scheia, in anul 2008 in acest caz sentinta nu este definitiva a ajuns in arestul politiei judetene, deocamdata retinut 24 de ore, pentru viol.

De la fotbal la handbal şi invers. CSM şi Heniu, întâlnire la Polivalentă (FOTO)
www.timponline.ro - Bistriţa-Năsăud
Handbalistele de la CSM Bistriţa, locul 6 în Liga Naţională, au fost vizitate la antrenament de componentele echipei de fotbal Heniu Prundu Bârgăului, locul 7 în campionat. Handbalistele au încercat mingea de fotbal, iar fotbalistele de la Heniu pe cea de handbal.
”Girls Power! Aşa am putea descr

Preşedinţii şi administratorii de blocuri au TUNAT şi FULGERAT la adresa RETIM! Se REFAC CONTRACTELE
newsar.ro - Arad
Citeşte azi ce scriu ziarele de mâine!

Un barbat a incercat sa mituiasca doi politisti care l-au prins conducand fara permis. Ce suma le-a oferit suspectul oamenilor legii
www.ziuaconstanta.ro - Constanţa
La data de 15.02.2018, ofiterii Directiei Generale Anticoruptie D.G.A. Serviciul Judetean Anticoruptie S.J.A. Satu Mare, sub coordonarea procurorului de caz din cadrul Parchetului de pe langa ...

O nouă dublă în deplasare pentru baschetbalistele de la Universitatea CSM
www.ebihoreanul.ro - Bihor
Baschetbalistele de la Universitatea CSM Oradea vor susţine, în acest sfârşit de săptămână, o nouă dublă în deplasare, în cadrul campionatului Ligii I. În faza semifinală, elevele antrenorilor Ioana Anica, Adriana Niculescu şi Daniel Anica vor juca sâmbătă la Bucureşti, cu Sportul Studenţesc, iar duminică, la Constanţa, cu Phoenix.

Ce mesaj a transmis ministrul Carmen Dan la sedinta de bilant a Politiei Romane. La activitate a fost prezent si premierul Viorica Dancila
www.ziuaconstanta.ro - Constanţa
Astazi, 16 februarie, prim-ministrul Romaniei, Vasilica Viorica Dancila si ministrul afacerilor interne, Carmen Daniela Dan, au participat la sedinta de evaluare a activitatii desfasurate in anul 2017 ...

La Timisoara se pregateste o noua editie a Targului de Turism Vacanta
www.tion.ro - Timiş
Timişorenii îşi vor putea rezerva din timp util, la preţuri promoţionale, concediile din vară cu ocazia unei noi ediţii a Târgului de Turism Vacanţa. Acţiunea va avea loc în Capitala Banatului în primul weekend din luna martie.

Google interzice mai multe tipuri de reclame în Chrome. Ce nu vei mai vedea pe site-uri
www.stiridecluj.ro - Cluj
Compania Google anunţă că, începând de azi, browserul Chrome va afi...

Doi copii loviţi de un taxi pe Semaforului. Au ajuns la spital
www.oradesibiu.ro - Sibiu
Doi minori au fost accidentaţi de un autoturism în timp ce traversau regulamentar strada pe trecerea de pietoni. Accidentul a avut loc pe strada Semaforului la intersecţia cu Electricienilor. Cei doi…

Abuz în serviciu, 8 acte materiale. Fostul primar Lala va fi judecat pentru toate ilegalităţile comise
evz.ro - Bucureşti
Ion Lala, fostul primar din Lăpuşnicu Mare, Caraş Severin, este judecat pentru abuz în serviciu, după ce procurorii au stabilit că a atribuit mai multe cont...

SURPRIZĂ la nivel înalt! INUNDAȚII în judeţul PREMIERULUI DĂNCILĂ. Iarna nu-i ca vara
evz.ro - Bucureşti
O parte a judeţului Teleorman care a dat României premierul, Viorica Vasilică Dăncilă, ministrul de Interne, Carmen Dan, preşedintele Camerei Deputaţilor, c...

AVION PRĂBUȘIT în TURCIA. Nu există SUPRAVIEȚUITORI. Incidentul, înconjurat de MISTER
evz.ro - Bucureşti
Doi militari turci şi-au pierdut viaţa vineri în urma prăbuşirii unui avion de antrenament în vestul ţării, a anunţat armata turcă, potrivit France Presse, ...

Despre „Marele Blat Iohannis-Dragnea-Kovesi” şi despre „EXILUL” în Republica Moldova al lui Traian Băsescu
evz.ro - Bucureşti
O analiză la „sânge” face politicianul Gelu Vişan vis-a-vis de tot ceea ce se întâmplă în aceste zile pe scena politică dar mai ales despre şocantele dezvăl...

Parfumuri si obiecte vestimentare confiscate de politistii maramureseni
ziarmm.ro - Maramureş
Activitatile politistilor specializati in investigarea criminalitatii economice pentru prevenirea si combaterea evaziunii fiscale au continuat. Actiunea organizata joi, 15 februarie a avut ca scop ver

Bistriţa-Năsăud, 50 de ani de la reorganizarea administrativă
www.timponline.ro - Bistriţa-Năsăud
”Astăzi se împlinesc 50 de ani de la ultima reorganizare administrativ-teritorială a României, care a dat naştere judeţului Bistriţa-Năsăud, organizat în forma actuală. Această reformă teritorială, modifică precedentul mod de organizare ce avea ca sursă de inspiraţie unităţile administrativ-teritori

De colectie: Imagine din timpul filmarilor la pelicula Pintea
ziarmm.ro - Maramureş
AGERPRES a postat pe pagina de Facebook o imagine din timpul filmarilor la pelicula "Pintea", desfasurate in Baia Mare, in anul 1975. Regia filmului este semnata de Mircea Moldovan. Foto: (c) VIOREL L

Suceveancă cu mandat european de arestare, săltată de la Penitenciarul Botoşani, unde îşi ...
feeds.monitorulsv.ro - Suceava
Ultima ora: O femeie in varsta de 35 de ani din Suceava a fost saltata de politisti in baza unui mandat european de arestare emis de autoritatile italiene. Mandatul a fost pus in executare joi, iar partea iesita din comun a cazului este ca femeia a fost ridicata de la Penitenciarul Botosani, unde se afla in vizita la concubinul ei.

FLAGRANT. Bărbat prins în timp ce încerca să mituiască doi poliţişti
portalsm.ro - Satu Mare
FLAGRANT. Bărbat prins în timp ce încerca să mituiască doi poliţişti

Alegeri: Gheorghe Barbus este noul presedinte al Organizatiei Pensionarilor si Varstei a 3-a a PNL Baia Mare
ziarmm.ro - Maramureş
Conferinta pentru alegeri a Comitetului de Coordonare Local OPV 3 PNL Baia Mare, organizata in 15 februarie, in Baia Mare, l-a ales cu vot majoritar, pe domnul Gheorghe Barbus in functia de presedinte

PANICĂ pe STRĂZILE din Satu Mare. Femeile din oraş, TERORIZATE de un bărbat care se PLIMBĂ cu ORGANUL SEXUAL expus
evz.ro - Bucureşti
Un bărbat a reuşit să creeze panică în Satu Mare! Mamele care îşi duc copiii la şcoală în fiecare dimineaţă trec prin momente groaznice. ...

Venituri cu 20% mai mici pentru dascălii bolnavi de cancer sau cei în concediu de creştere a copilului!
evz.ro - Bucureşti
Mii de angajaţi din educaţie, unii bolnavi de cancer şi aflaţi în concediu medical, alţii în concediu d ecreştere a copilului, sunt afectaţi de noile preved...

Anunt important de la SPIT Constanta. Se deschide un nou ghiseu pentru plata taxelor si impozitelor atat numerar cat si prin card bancar
www.ziuaconstanta.ro - Constanţa
Incepand de luni, 19 februarie 2018, Serviciul Public de Impozite si Taxe Constanta vine in sprijinul cetatenilor prin deschiderea unui nou ghiseu pe str. Stefan Mihaileanu nr. 10, in sediul unde isi ...

Daniel Savu: Am aflat de la televizor ca mi se pregateau dosare pentru ca am sesizat fapte pe care le-am considerat abuzuri
ph-online.ro - Prahova
Invitat in platoul Antenei 3, la Sinteza Zilei, fostul senator Daniel Savu a aflat in direct, cu stupoare, ca a fost la un pas sa fie linsat de tandem...

Mai multe gospodării din Drăgăneşti Vlaşca au fost inundate
ziarulteleormanul.ro - Teleorman
Mai multe gospodării din Drăgăneşti Vlaşca, precum şi baza sportivă a Școlii Gimnaziale din localitate au fost inundate în urma ploilor căzute în ultimele zile. “Râul Câlniştea s-a revărsat şi a inundat 27 de curţi şi grădini, 9 anexe gospodăreşti, baza sportivă a Școlii Gimnaziale Drăgăneşti Vlaşca, aproximativ 400 m de străzi comunale şi în jur de 6 ha de terenuri arabile”, a declarat mr. Gelu Dragomir, purtătorul de cuvânt al ISU Teleorman. Potrivit sursei citate, în cursul zilei de joi, 15 februarie, a fost convocat Comitetul Local pentru Situaţii de Urgenţă, care a trimis în z

Ambasadorul Statului Israel, E.S.Tamar Samash, a fost primit de catre prim-ministrul Viorica Dancila, la Palatul Victoria. Ce subiecte au fost analizate
www.ziuaconstanta.ro - Constanţa
Prim-ministrul Viorica Dancila a primit-o astazi, 16 februarie, pe E.S. Tamar Samash, ambasadorul Statului Israel la Bucuresti. Potrivit Guvernului Romaniei, in cursul discutiilor, a fost reliefata ...

Mircea Badea, demoralizat după eşecul operaţiunii ”Kovesi”: ”Vom vedea ce va urma”
www.stiridecluj.ro - Cluj
Mircea Badea, demoralizat după eşecul operaţiunii ”Kovesi”: ”Vom vedea ce va urma”

Şedinţă de lucru a Consiliul Judeţean cu aprobarea bugetului judeţului pe ordinea de zi
ziarulteleormanul.ro - Teleorman
20 de proiecte de hotărâre au fost supuse dezbaterii în şedinţa ordinară a Consiliului Judeţean de joi, 15 februarie, printre care şi cel privind aprobarea bugetului propriu al judeţului Teleorman pe anul 2018 şi estimările pentru anii 2019-2020. Printre hotărârile adoptate de cei 33 de aleşi judeţeni prezenţi în sala de şedinţe a Palatului Administrativ s-au aflat şi cele cele privind stabilirea preţului mediu al produselor agricole, la care arenda se exprimă în natură, pentru anul 2018, stabilirea preţului mediu pentru masa verde de pe pajişti, pentru anul 2018, dar şi cel privind aprobarea

Înnoire de PUG la Suplac
www.zi-de-zi.ro - Mureş
Conducerea Primăriei comunei Suplac anunţă publicul interesat asupra depunerii la Agenţia pentru Pro

ELENA, predestinată numelui ŞOVA
evz.ro - Bucureşti
Numirea noului secretar general la Ministerului Transporturilor ridică multe semne de întrebare....

DOSARUL lui MAZĂRE LOVEȘTE nume GRELE din ÎNTREAGA LUME. Patru MILIARDARI, OBLIGAȚI să PLĂTEASCĂ 12.000.000 de euro cauţiune
evz.ro - Bucureşti
Miza unuia dintre cazurile în care este implicat Radu Mazăre este din ce în ce mai mare. În dosarul mitei de 175.00 de euro pe care fostul primar......

Primarul din Filipestii de Targ, dat DISPARUT!
ph-online.ro - Prahova
Ingrijorare mare printre locuitorii din Filipestii de Targ. Oamenii se tem ca au ramas fara primar, motiv pentru care au lansat apeluri disperate pe F...

Statii de autobuz ca in Dubai, intr-o localitate de langa Ploiesti
ph-online.ro - Prahova
Par desprinse din filmele SF, mai ales daca le privim in comparatie cu penibilele copertine, multe dintre ele gaurite, sub care se adapostesc ploieste...

Alarmant! Top 10 viruşi care ar putea provoca următoarea epidemie
evz.ro - Bucureşti
Organizaţia Mondială a Sănătăţii a publicat lista anuală de afecţiuni letale care ar putea provoca următoarea epidemie, cerând totodată accelerarea cercetăr...

Nadia Comăneci şi Bart Conner dau startul unei noi ediţii a Festivalului de Sport şi Sănătate din Oklahoma
evz.ro - Bucureşti
Ca în fiecare an, „Festivalul de Sport şi Sănătate Bart&Nadia” va fi gazduit de cei doi foşti mari gimnaşti, în „Cox Arena” din Oklahoma City. La acest even...

Surpriză din partea ANDREEI ESCA. Prezentatoarea de la PROTV vrea să îşi CONSTRUIASCĂ un HOTEL de patru stele
evz.ro - Bucureşti
Prezentatoarea de la stirile ProTV, Andreea Esca, are un nou vis. Aceasta îşi doreşte să construiască alături de soţul ei un hotel de patru stele în centru....

VEȘTI TRISTE despre una din cele mai ÎNDRĂGITE ACTRIȚE din lume!
newsar.ro - Arad
Citeşte azi ce scriu ziarele de mâine!

Presedintele, bronzat si relaxat, a demonstrat ca nu vrea sa fie obiectiv
ph-online.ro - Prahova
Jurnalista Sorina Matei iese la atac după declaraţiile de presă ale lui Tudorel Toader şi Klaus Iohannis. Aceasta îl critică, într-o postare pe Facebo...

Asociaţia Trăiesc în Floreşti cere alipirea comunei de municipiul Cluj-Napoca
www.stiridecluj.ro - Cluj
Asociaţia Trăiesc în Floreşti cere alipirea comunei de municipiul Cluj-Napoca

LIVE VIDEO – Se anunţă preţurile biletelor pentru meciul FC Hermannstadt – FC SB
www.oradesibiu.ro - Sibiu
Vineri de la ora 12.30 are loc o conferinţă de presă la Stadionul „Municipal” Sibiu. Cu aceasta ocazie, Teodor Birt, presedintele FC Hermannstadt, va prezenta toate detaliile referitoare la meciul cu…

Mulţumiri pentru pompierii bihoreni de la compania ce deţine sonda de gaz care a ars 20 de zile
www.ebihoreanul.ro - Bihor
Jeffrey Auld, preşedintele companiei canadiene Serinus, care deţine sonda de gaz din Moftinu Mare, judeţul Mare, unde pe 18 decembrie a izbucnit un incendiu uriaş, stins abia pe 6 ianuarie, le-a transmis o scrisoare de mulţumire pompierilor bihoreni care au participat la ampla operaţiune de stingere. În total, 77 de militari din cadrul ISU Crişana au intervenit la acest incendiu.

S-a dat deşteptarea pentru consilierii judeţeni ai PNL?!
ziarulteleormanul.ro - Teleorman
Întrebat în repetate rânduri ce se întâmplă cu aleşii judeţeni ai PNL şi de ce, cu mici excepţii, sunt atât de tăcuţi în şedinţele de lucru ale forului de decizie de la nivel de judeţ, preşedintele PNL Teleorman, senatorul Eugen Pîrvulescu anunţa, cu aproximativ două săptămâni în urmă, o “schimbare la faţă” a consilierilor liberali din Consiliul Judeţean. Iar acest lucru pare că s-a întâmplat mai repede decât se aştepta însuşi liderul PNL Teleorman, astfel că, în cea mai recentă şedinţă a Consiliului Judeţean de joi, 15 februarie, reprezentanţii dreptei teleormănene au avut intervenţii la majo

Accident intre un TIR si o duba, la Blejoi
ph-online.ro - Prahova
Un accident de circulatie s-a produs astazi, in jurul orei 11, pe DN 1, la Blejoi, in sensul giratoriu din zona benzinariei Lukoil. Potrivit ISU Praho...

Pedeapsă drastică după cazul Metalu Aiud – Energia Săsciori! Arbitrul Horaţiu Balea, „pe bară” şi reţinut de la delegări tot returul!!!
ziarulunirea.ro - Alba
Surse autorizate susţin că brigada de arbitri care a oficiat la meciul „cu cântec” din etapa a 14-a a Ligii a 4-a, Metalu Aiud – Energia Săsciori, omologată de Comisia de Dsiciplină a AJF Alba la „masa verde” pentru că gazdele au efectuat 5 înlocuiri, fară ca respectiva situaţie să fie semnalată în raportul de […]

Acreditarea laboratorului antidoping de la Bucuresti a fost SUSPENDATA de Agentia Mondiala!
www.infobraila.ro - Brăila
Comentarii comentariu

Ponta, lansează ACUZAȚIA care îl ÎNGROAPĂ pe Dragnea. „Marele LUPTĂTOR contra „Statului Paralel” A ÎNCERCAT un TROC cu Iohannis şi Kovesi!”
evz.ro - Bucureşti
Ex-premierul pesedist Victor Ponta susţine, pe Facebook, că Liviu Dragnea a încercat să negocieze cu şefa DNA, Laura Codruţa Kovesi, şi cu preşedintele......

Huawei răspunde SUA: „Sunt ÎMPOTRIVA businessului nostru”
evz.ro - Bucureşti
Vârfurile FBI, CIA, NSA şi şeful intelligence SUA, au lansat în Congres o alarmă instituţiilor şi cetăţenilor americani: nu cumpăraţi smartphonuri produse î...

O firmă dă angajaţilor MII DE DOLARI pentru a DEMISIONA
evz.ro - Bucureşti
Le oferă angajaţilor sume de până la 5.000 de dolari dacă sunt de acord să îşi dea demisia....

Cel mai stupid fel de a muri. S-a întâmplat la Petroşani
evz.ro - Bucureşti
Un hunedorean a avut parte de cea mai stupidă moarte. Decesul a fost constata ieri seara, după intervenţia unui echipaj ISU şi al medicilor. Totul I s-a tra...

Angelei Merkel îi CADE mâna STÂNGĂ. Tot mai jos...
evz.ro - Bucureşti
Aliaţii social-democraţi, cu care Merkel speră să facă un guvern pentru a-şi însuşi al patrulea mandat de canceşlar, se prăbuşesc în sondaje....

Oana Badea: ”Achiziţionarea unui Computer Tomograf pentru Spitalul Municipal Aiud – unul dintre obiectivele prioritare pentru anul acesta”
ziarulunirea.ro - Alba
Primarul municipiului Aiud, Oana Badea, a anunţat vineri, într-o conferinţă de presă, că unul dintre cele mai importante obiective ale administraţiei locale, în acest an, este achiziţionarea unui Computer Tomograf pentru spitalul din oraş. ”Spitalul Municipal Aiud se adresează unui număr de peste 55.000 de persoane, toată zona vine către spitalul nostru. Am sprijinit şi […]

Calificarea, a jucat-o si cu mingea
ph-online.ro - Prahova
Gimnasta Clubului Sportiv Municipal Ploieşti, Denisa Stoian, a reuşit, la Moscova, un rezultat remarcabil, obţinând calificarea pentru Jocurile Olimpi...

Maşină cu lemne fără acte, confiscată de poliţiştii din Piatra-Neamţ. Șoferul, sancţionat cu 6.000 de lei
www.stiri-neamt.ro - Neamţ
La data de 16 februarie a.c., poliţiştii au depistat un bărbat, din Dămuc, în timp ce transporta cherestea fără documente de provenienţă şi transport. Aces

Plăci de bază ca element central al asamblării propriului calculator
www.ebihoreanul.ro - Bihor
Nu toată lumea este pasionată de ultrabook-uri, mai ales dacă cele mai noi jocuri sunt în topul listei de priorităţi Aşa că, inevitabil, te vei număra printre cei care se îndreaptă către construirea (sau asamblarea) propriului calculator. Până să aşezi în coşul de cumpărături cele mai tari procesoare şi plăci video, ar trebui să ţii cont de un lucru simplu: placa de bază îşi poartă numele pe bună dreptate.

Simona Halep suparata dupa marele turneu in Australia
www.infobraila.ro - Brăila
Comentarii comentariu

Consiliul National pentru Combaterea Discriminarii s-a autosesizat dupa declaratiile primului ministru in care a folosit drept comparatie cuvantul autist“
www.ziuaconstanta.ro - Constanţa
Consiliul National pentru Combaterea Discriminarii a decis sa se autosesizeze cu privire la declaratia doamnei Prim-ministru Dancila Viorica Vasilica, din cadrul interviului acordat la televiziunea Antena ...

O firmă dă angajaţilor MII DE DOLARI pentru a DEMISIONA
evz.ro - Bucureşti
Le oferă angajaţilor sume de până la 5.000 de dolari dacă sunt de acord să îşi dea demisia....

Victor Ponta, DEZVĂLUIRE-BOMBĂ: ”Dragnea a încercat un TROC cu Iohannis şi Kovesi, dar a fost PREA LAȘ!” DEDESUBTURILE AFACERII
evz.ro - Bucureşti
Ex-premierul pesedist Victor Ponta susţine, pe Facebook, că Liviu Dragnea a încercat să negocieze cu şefa DNA, Laura Codruţa Kovesi, şi cu preşedintele Klaus Iohannis, dorind parafarea unui ”blat”, însă teleormăneanul nu a avut curajul să tranşeze adoptarea unei linii politice clare în ceea ce priveşte DNA, în CEx-ul PSD....

PONTA aruncă BOMBA în SCANDALUL DNA:”Dragnea a încercat o NEGOCIERE şi şi-a luat ȚEAPĂ”
evz.ro - Bucureşti
Fostul premier, Victor Ponta, a scris pe Facebook despre lipsa de reacţie a liderului PSD cu privire la revocarea şefei DNA. Acesta susţine că Liviu Dragnea...

Neamţ: Minor dispărut, căutat de Poliţie. Dacă aveţi informaţii sunaţi la „112”
www.stiri-neamt.ro - Neamţ
Un minor de 15 ani, din Târgu Neamţ este căutat de poliţişti din cursul zilei de ieri, de când a fost făcută sesizarea de către familia acestuia. Persoanel

Agentia de Plati si Interventie pentru Agricultura (APIA) informeaza ca, pana la data de 15 februarie 2018, a autorizat la plata un numar de 753.357 fermieri unici care au depus Cerere de plata in cadrul Campaniei 2017.
www.infobraila.ro - Brăila
Comentarii comentariu

Viceprimarul oraşului Târgu Bujor, găsit incompatibil de ANI
stiridegalati.ro - Galaţi
Potrivit unui comunicat al ANI, Ciprian Chelăraşu, viceprimarul oraşului Târgu Bujor a fost găsit incompatibil. Începând cu data de 22 iunie 2012, Chelăraşu a deţinut şi a exercitat simultan funcţia de viceprimar şi pe cea de administrator al Societăţii Clearland S.R.L., iar începând cu data de 27 august 2012, a deţinut şi a exercitat simultan funcţia …

Braconaj piscicol
www.infobraila.ro - Brăila
Comentarii comentariu

Decizie BOR: Filmarea şi fotografierea nunţilor şi botezurilor, interzise în biserici
portalsm.ro - Satu Mare
Decizie BOR: Filmarea şi fotografierea nunţilor şi botezurilor, interzise în biserici

Viceprimarul oraşului Tâtgu Bujor, găsit incompatibil de ANI
stiridegalati.ro - Galaţi
Potrivit unui comunicat al ANI, Ciprian Chelăraşu, viceprimarul oraşului Târgu Bujor a fost găsit incompatibil. Începând cu data de 22 iunie 2012, Chelăraşu a deţinut şi a exercitat simultan funcţia de viceprimar şi pe cea de administrator al Societăţii Clearland S.R.L., iar începând cu data de 27 august 2012, a deţinut şi a exercitat simultan funcţia …

LISTA celor pe care BITCOIN i-a făcut MILIARDARI în 2017
evz.ro - Bucureşti
Forbes a publicat listă cu 20 de persoane care s-au îmbogăţit pe urma bitcoin şi a altor criptomonede. Aceştia au o avere cumulată la 550 de miliarde de dol...

De ce se FEREŞTE Putin să CANDIDEZE la alegerile prezidenţiale?
evz.ro - Bucureşti
Vladimir Putin face eforturi pentru a nu părea în ochii ruşilor un candidat la viitoarele alegeri, ci un preşedinte care munceşte pentru popor....

Super hoţi la 12 şi 16 ani. Au spart până şi o biserică
evz.ro - Bucureşti
Doi copii au dat spargeri în serie ca să trăiască pe picior mare. Au furat bani şi bunuri, dar şi alcool şi ţigări. Puştanii nu s-au sfiit să atenteze la cu...

Putin AMENINŢAT de SUA şi Marea Britanie: Va PLĂTI consecinţele
evz.ro - Bucureşti
America şi Anglia denunţă un grav atac al hackerilor ruşi, direct controlaţi de armată, în dauna Ucrainei şi de aici în lumea întreagă. Casa Albă avertizeaz...

Elevi de la Şcoala Postliceală Sanitară „Dimitrie Cantemir” Târgu-Mureş, practică în Italia şi Spania
www.zi-de-zi.ro - Mureş
30 de elevi ai Şcolii Postliceale Sanitare „Dimitrie Cantemir” din Târgu-Mureş participă, în aceste

Peste 3000 de candidaţi dâmboviţeni, la probele evaluare a competenţelor din cadrul examenului naţional de Bacalaureat 2018
www.gazetadambovitei.ro - Dâmboviţa
În perioada 12 – 22 februarie se desfăşoară probele de evaluare a competenţelor din cadrul examenului naţional de Bacalaureat 2018.

Ministrul de Interne, precizări despre salariile poliţiştilor
evz.ro - Bucureşti
Ministrul de Interne, Carmen Dan, a reamintit, vineri dimineaţa, la prezentarea bilanţului Poliţiei Române pe anul 2017, că cei 8000 de poliţişti au rămas f...

Reglare de conturi în ALDE Bihor: Traian Bodea, înlocuit la şefia filialei cu Ciprian Blejan pe pretext că nu şi-a... plătit cotizaţia
www.ebihoreanul.ro - Bihor
Vicepreşedintele Consiliului Judeţean Bihor, Traian Bodea, a căzut în dizgraţia preşedintelui ALDE, Călin Popescu Tăriceanu, care a orchestrat înlăturarea sa de la şefia filialei Bihor, cu o motivaţie ridicolă: Bodea nu şi-a plătit cotizaţia „la Centru”, adunând restanţe de câteva mii de lei, vina reală fiind, însă, de 'deviaţionism'. Locul de preşedinte unic al filialei a fost luat de celălalt co-preşedinte, Ciprian Blejan, fost membru PDL şi ginere al defunctului Octavian Bot, numit luna trecută într-o funcţie la o firmă de stat în Bucureşti.

Functionar public din cadrul Primariei Macin, judetul Tulcea gasit in incompatibilitate de ANI
www.ziuaconstanta.ro - Constanţa
Agentia Nationala de Integritate a constatat starea de incompatibilitate si existenta unei diferente nejustificate intre averea dobandita si veniturile realizate in cazul a sase fosti si actuali ...

Compania celui mai bogat om din lume le oferă angajaţilor 5.000 de dolari pentru a demisiona
www.stiridecluj.ro - Cluj
Compania Amazon, deţinută de cel mai bogat om din lume, Jeff Bezos, le oferă angajaţil...

Ministrul Sănătăţii, anunţ important pentru pacienţi şi medici
evz.ro - Bucureşti
Ministrul Sănătăţii, Sorina Pintea, a declarat joi seara că spitalele sunt obligate să asigure medicaţia necesară pacienţilor, iar în situaţia în care pacie...

SOROS, la un pas de K.O. În mijlocul „ATACURILOR INTERNAȚIONALE”, un singur STAT REUȘEȘTE să SCAPE de INFLUENȚA miliardarului, spune guvernul
evz.ro - Bucureşti
Întâlnirea dintre cele două partide aflate la guvernare în Ungaria are toate şansele să aducă veşti proaste pentru miliardarul George Soros. Fidesz şi......

Imagini INCREDIBILE cu judecătorul Cristi Danileţ! Magistratul, SURPRINS la masa cu ambasadoarea Olandei - Foto în articol
evz.ro - Bucureşti
Celebrul judecător Cristian Danileţ a fost fotografiat în timp ce lua masa de prânz cu ambasadoarea Olandei, Stella Ronner Grubacic,
la restaurantul UpTown ...

Ce a PĂȚIT consilierul CĂLDARE după ce a SEMNAT DECLARAȚIA de UNIRE cu ROMÂNIA
evz.ro - Bucureşti
Andrei Căldare, consilier local din Măgurele, Republica Moldova, ales pe listele Partidului Socialist, a intrat la mare încurcătură după ce a semnat Declara...

NEWS ALERT: Oancea încearcă, din nou, schimbarea viceprimarului Răzvan Mareş
glasul-hd.ro - Hunedoara
Primarul Florin Oancea încearcă, din nou, schimbarea viceprimarului Răzvan Mareş. Ordinea de zi a şe

Femeie din Stejaru, judetul Tulcea violata si jefuita de un tanar. Suspectul a fost depistat si retinut
www.ziuaconstanta.ro - Constanţa
Un tanar de 22 de ani din judetul Prahova, suspectat ca a violat o femeie din localitatea Stejaru, judetul Tulcea a fost depistat rapid de politisti si retinut. Potrivit IPJ Tulcea, la data de 15 ...

FOTO: Împreună pentru siguranţa tinerilor! Activităţi de informare şi prevenire a delincvenţei juvenile şi a consumului de droguri
ziarulunirea.ro - Alba
Poliţiştii din Alba au fost alături de tineri , desfăşurând activităţi de informare şi prevenire a delincvenţei juvenile şi a consumului de droguri în cadrul proiectului ÎMPREUNĂ PENTRU SIGURANŢA TINERILOR, desfăşurat în parteneriat cu Centrul de Prevenire, Evaluare şi Consiliere Antidrog Alba. În perioada 12-16 februarie 2018, poliţiştii Compartimentului de Analiză şi Prevenire a Criminalităţii […]

Campioana Volei Alba Blaj, examen serios în Moldova, cu Știinţa Bacău | După 3-0 cu Dinamo vine derby-ul rundei a 17-a în Divizia A1
ziarulunirea.ro - Alba
Fără îndoială că derby-ul rundei a 17-a (penultima din sezonul regulat) din Divizia A1 se dispută în Moldova, între Știinţa Bacău (35 de puncte) şi campioana Volei Alba Blaj (42 de puncte), ocupantele ultimelor două trepte ale podiumului, partida fiind prevăzută duminică, 18 februarie, de la ora 14.45 (în direct la Digi Sport 3). Va […]

Expozitie Multiplexity 2021, Centru Arta-Tehnologie-Experimentare, la Bastion
www.tion.ro - Timiş
„Multiplexity 2021, Centru Artă-Tehnologie-Experimentare” văzut prin ochii studenţilor de la Facultatea de Arhitectură şi Urbanism.

Deputatul Adrian Todor cere Companiei Naţionale de Investiţii explicaţii privind modernizarea stadionului UTA şi noul bazin de polo
newsar.ro - Arad
Deputatul social-democrat arădean Adrian Todor a solicitat conducerii Companiei Naţionale de Investiţii, prin intermediul unei întrebări adresate în Parlamentul României, să dea explicaţii cu privire la stadiul în care se află noul bazin de polo şi lucrările la stadionul UTA, două proiecte finanţate de CNI în municipiul nostru. Compania Naţională de Investiţii derulează câteva proiecte

Atenţie! Nu vă daţi datele. Atac în numele unei bănci
portalsm.ro - Satu Mare
Atenţie! Nu vă daţi datele. Atac în numele unei bănci

Acţiune a poliţiştilor din Baia de Arieş şi Sălciua. 14 amenzi aplicate, în valoare de 1650 de lei şi 38 de testări alcoolscopice
ziarulunirea.ro - Alba
În data de 15.02.2018, poliţiştii din cadrul Poliţiei oraşului Baia de Arieş şi a Postului de Poliţie Sălciua, au aplicat 14 sancţiuni contravenţionale, în valoare de 1650 lei. În data de 15 februarie a.c., poliţiştii din cadrul Poliţiei oraşului Baia de Arieş şi a Postului de Poliţie Sălciua, au continuat acţiunile având ca scop menţinerea […]

Premierul Viorica Dancila a participat la bilantul Politiei Romane. Le-a cerut politistilor sa intensifice actiunile de combatere a traficului de persoane
www.ziuaconstanta.ro - Constanţa
Premierul Viorica Dancila a cerut politistilor sa intensifice actiunile de combatere a traficului de persoane si sa accentueze componenta de prevenire, informeaza Agerpres.ro. In cadrul ...

Cresterea PIB nu a convins piata valutara
www.infobraila.ro - Brăila
Comentarii comentariu

Acţiune comună Poliţie–RAR, la Abrud: 14 amenzi în valoare de 3.480 de lei, într-o zi. 4 certificate de înmatriculare retrase şi un permis de conducere reţinut
ziarulunirea.ro - Alba
În data de 15.02.2018, poliţiştii din cadrul Postului de Poliţie Ciuruleasa, în colaborare specialişti din cadrul Registrului Auto Român – Alba, au aplicat 14 sancţiuni contravenţionale, în valoare de 3480 lei. În data de 15 februarie a.c., poliţiştii din cadrul Postului de Poliţie Ciuruleasa, în colaborare specialişti din cadrul Registrului Auto Român – Alba au […]

Finanţele iau în calcul „taxa pe credinţă”
evz.ro - Bucureşti
Ministrul Finanţelor vrea să oblige cultele religioase să-şi aloce o parte din venituri pentru finanţarea unor cheltuieli guvernamentale...

O ACTRIȚĂ celebră ATACĂ PSD-ALDE. Vedeta cere EXPLICAȚII celor care conduc ȚARA
evz.ro - Bucureşti
Actriţa Oana Pellea a lansat un mesaj prin care îi atacă pe cei de la guvernare, mai exact coaliţia PSD-ALDE. Aceasta le cere mai multe explicaţii....

Husele – soluţii practice pentru orice utilizator de telefon inteligent
www.stiridecluj.ro - Cluj
Oamenii încep să folosească tot mai mult telefoanele inteligente, cu aproape o...

Studiul de fezabilitate pentru parcarea subterană, aprobat!
www.zi-de-zi.ro - Mureş
Studiul de fezabilitate pentru proiectul care vizează construirea unei parcări subterane în centrul

Tunisian prins de politisti ca a ramas in Romania desi nu mai avea drept de sedere
www.tion.ro - Timiş
Probleme pentru un tânăr de 30 de ani din Tunisia, care a locuit legal la Timişoara până nu de mult. El va fi obligat să părăsească România după ce perioada legală de şedere a expirat şi nu a făcut demersuri pentru a-şi prelungi documentele.

Tigari de contrabanda confiscate de jandarmi de la un barbat, in Piata Traian din Timisoara
www.tion.ro - Timiş
Acuzaţii de punere în vânzare a produselor de contrabandă pe numele unui bărbat, la Timişoara. Totul după ce a fost prins de jandarmi că avea asupra lui mai multe cartuşe cu ţigări de contrabandă în valoare de aproximativ 1.800 de lei.

Ambulanţierul care a cărat în spate o bătrână bolnavă dintr-un cătun din Apuseni trebuie să dea explicaţii pentru încălcarea protocolului. Colegii: ”Haideţi să arătăm că noi îl respectăm”
ziarulunirea.ro - Alba
Nicio faptă bună nu rămâne nepedpsită. O ilustrează perfect cazul ambulanţierului Dumitru Ignat, cel care a cărat o bătrână bolnavă în spate până la maşină, din cauza drumului impracticabil, şi care acum va trebui să dea cu subsemnatul la superiori pentru nerespectarea protocolului. Colegii lui Igant sunt indignaţi de faptul că în loc să fie […]

Legi pentru hoti. Trei decenii de taiere ilegala a padurilor, cu sprijinul autoritatilor
ziarmm.ro - Maramureş
Intr-o scrisoare deschisa adresata Presedintelui Romaniei, Klaus Werner Iohannis, si Prefectului Judetului Maramures, Vasile Moldovan, Asociatia Proprietarilor de Paduri, Pasuni si Terenuri Agricole

Tânărul Andrei-Marian Stoian a mai „prins” două stele
stiridegalati.ro - Galaţi
În 2017, el a descoperit "Schela V1", o stea variabilă, care a şi fost înregistrată pe 3 ianuarie.

Crearea unor produse inovative folosind tehnologia 3D
www.infobraila.ro - Brăila
Comentarii comentariu

Întrebare… Întrebătoare – CE CAUTĂ SINDICATUL LUI COARNĂ ÎN PROCESUL DE LA CĂLĂRAȘI?!…
www.soridapress.ro - Călăraşi
În Jurnalul de luni!

Acţiune a poliţiştilor Secţiei 2 Poliţie Rurală Vinţu de Jos. Au fost aplicate 66 de amenzi, în valoare de 20.010 lei
ziarulunirea.ro - Alba
În data de 15.02.2018, poliţiştii Secţiei 2 Politie Rurală Vinţu de Jos au organizat o acţiune pentru creşterea gradului siguranţei publice si reducerea riscului rutier. Astfel că, în urma acţiunii desfăşurate, poliţiştii au aplicat 66 de sancţiuni contravenţionale, conform O.U.G. 195/2002 rep., în valoare de 20010 lei, astfel: 54 pentru viteză peste limita legală, 6 […]

FSLI: Angajaţii din educaţie, aflaţi în concediu medical, pierd aproximativ 20 % din venit
www.stiri-neamt.ro - Neamţ
Mii de angajaţi din educaţie sunt afectaţi de prevederile Codului Fiscal, prin care a fost stabilită noua formulă de calcul a salariului acordat în timpul

ALO, MILIȚIA, PUNEȚI SEMAFOR SAU STOP VIZIBIL LA VLĂDUȚ! CÂTE ACCIDENTE MAI VREȚI SĂ SE ÎNTÂMPLE?!… VREȚI MORȚI?!…
www.soridapress.ro - Călăraşi
TREBUIE SĂ MOARĂ OAMENI CA SĂ INTRAȚI ÎN NORMALITATE ?!… Este întrebarea pe care ne-au adresat-o foarte mulţi dintre cititorii noştri, şocaţi de avalanşa de accidente care se petrec, de

Tânăr din Unirea, cercetat pentru furt calificat. A intrat într-o locuinţă lăsată deschisă şi a sustras o sumă de bani
ziarulunirea.ro - Alba
La data de 15 februarie a.c., poliţiştii din cadrul Poliţiei oraşului Ocna Mureş au identificat un bărbat de 26 de ani, din loc. Unirea, ca persoană bănuită de comiterea unui furt comis în data de 03.08.2017, din interiorul unei locuinţe din loc. Unirea, jud. Alba. În data de 03.08.2017, M.A., profitând de faptul ca persoana […]

Criminal de război omagiat la Oradea: Adepţii lui Wass Albert sunt invitaţi la film
www.ebihoreanul.ro - Bihor
Anunţ controversat al reprezentanţilor Consiliului Naţional al Maghiarilor din Transilvania şi al Partidului Popular Maghiar din Transilvania, care îi invită orădeni la un film dedicat scriitorului Wass Albert, declarat criminal de război după ce a fost găsit vinovat de masacrarea a peste 100 de români şi evrei în timpul celui de-al Doilea Război Mondial. Evenimentul va avea loc sâmbătă după-amiază, la sediul CNMT din centrul oraşului.

DISPARE ORA DE VARĂ!…
www.soridapress.ro - Călăraşi
Ceea ce ziarul nostru a susţinut, de câţiva ani încoace, a devenit o problemă acceptată şi la nivelul Uniunii Europene! IATĂ CE A DECIS PARLAMENTUL EUROPEAN! Uniunea Europeană a decis,

POEZIE VIRALĂ despre ”SILA” stârnită de ”NESIMȚIREA” premierului Viorica Dăncilă!
evz.ro - Bucureşti
POEZIE VIRALĂ despre ”SILA” stârnită de ”NESIMȚIREA” premierului Viorica Dăncilă! Ce poezie a postat pe Facebook politologul Vladimir Tismaneanu...

ILIUȚĂ VA FI DEMIS?!… ÎȘI VA DA DEMISIA?!…SAU RĂMÂNE, ÎN CONTINUARE?!…
www.soridapress.ro - Călăraşi
UN DOSAR CU MULTE SUSPICIUNI… Despre situaţia preşedintelui Consiliului Judeţean Călăraşi, Vasile Iliuţă, după incidentul cu oprirea în trafic şi plecarea de la locul respectiv, fără aprobarea agenţiilor de poliţie,

A sustras un telefon mobil din incinta căminului cultural din Vinţu de Jos. Bărbat de 64 de ani cercetat pentru furt
ziarulunirea.ro - Alba
La data de 15 februarie a.c., poliţiştii din cadrul Postului de Politie Vinţu de Jos au identificat un bărbat de 64 de ani, din Vinţu de Jos, ca persoană bănuită de comiterea unui furt comis în data de 08.02.2018, din interiorul unui cămin cultural din loc. Vinţu de Jos, jud. Alba. În data de 08.02.2018, […]

Alina Eremia le canta indragostitilor la Timisoara, iar copiii sunt asteptati la teatru de papusi
www.tion.ro - Timiş
Sfârşitul de săptămână e unul plin de evenimente pentru timişoreni, la cel mai mare centru comercial din Timişoara. Se pregăteşte un concert Alina Eremia, un târg de accesorii fashion şi unul de produse naturale, dar şi teatru de păpuşi pentru copii.

VIZITĂ LA PARLAMENT CU SENATORUL RĂDUCU FILIPESCU
www.soridapress.ro - Călăraşi
În ediţia tipărită!

“ÎMPREUNĂ PENTRU DEZVOLTAREA DURABILĂ” – CONSILIERUL DE STAT, LASZLO BORBELY, LA CĂLĂRAŞI
www.soridapress.ro - Călăraşi
În ediţia tipărită!

Trei cetăţeni chinezi, doi administratori şi un manager de la firma Sen Fu SRL Zlatna, condamnaţi la închisoare cu suspendare pentru evaziune fiscală
ziarulunirea.ro - Alba
Trei cetăţeni chinezi, reprezentanţi ai unei societăţi comerciale din Zlatna cu obiect de activitate în domeniul prelucrării lemnului, au fost condamnaţi la Tribunalul Alba la pedepse cu închisoarea cu suspendare pentru infracţiuni economice. Liu Yachen, Liu Yan şi Sun Yang au fost trimişi în judecată în martie 2016, iar prima decizie în dosar a fost […]

Politistii locali din Constanta au depistat in trafic un mopedist fara permis de conducere. Ce masuri au fost luate
www.ziuaconstanta.ro - Constanţa
La data de 16.02 2016, orele 10.30, politistii locali cu atributii in domeniul circulatiei pe drumurile publice au identificat un barbat, in varsta de 44 de ani, care conducea un moped pe bulevardul Tomis ...

“DUNĂREA CĂLĂRAȘI” ARE… IMNUL SĂU!
www.soridapress.ro - Călăraşi
În ediţia tipărită!

SONDAJUL DE LA CĂLĂRAȘI – CONTROVERSE!…
www.soridapress.ro - Călăraşi
DIN NOU, O CERCETARE CORECTĂ!… Aşa cum v-am obişnuit, de fiecare dată, sondajele pe care le realizează CEMOP (Centrul experimental de monitorizare a opiniei publice) sunt realizate atunci când chiar

LA JUDECĂTORIA CĂLĂRAȘI SUNT PROBLEME!…
www.soridapress.ro - Călăraşi
*Numărul judecătorilor – invers proporţional cu numărul proceselor! *Un singur judecător- 40 de dosare într-o singură şedinţă! *Iar lumea se buluceşte la procese, ca într-o societate absolut anormală! N-AM AJUNS

PARTIDUL SECURITĂȚII INVENTAT DE… SECURITATE?!…
www.soridapress.ro - Călăraşi
TOTUL ESTE UN SCENARIU?!… Aceasta ar fi concluzia la care ar trebui să ajungem, în condiţiile în care tot ceea ce s-a întâmplat şi se întâmplă, în ultimii ani, în

CENZURA Facebook: A descoperit opozantul lui Putin dovada COMPLICITĂȚII lui Trump cu Kremlinul?
evz.ro - Bucureşti
Facebook susţine că, atunci când a blocat dezvăluirile lui Alexei Navalnîi despre legăturile Kremlinului cu oligarhii, s-a conformat legilor din Rusia. ...

Jurnalistul Rogozanu o atacă pe KOVESI:”Nu v-aţi făcut treaba”
evz.ro - Bucureşti
Jurnalistul Costi Rogozanu a lansat un atac la adresa şefei DNA, Laura Codruţa Kovesi, prin care o acuză că nu şi-a făcut treaba cum ar fi trebuit....

Premierul Dăncilă felicită activitatea de la Ministerul de Interne
evz.ro - Bucureşti
Premierul Vicorica Dăncilă a declarat, vineri dimineaţă, la evaluarea activităţii desfăşurate de Poliţia Română în anul 2017, că ţara noastră nu s-a confrun...

Google Chrome, cu ad-blocker implicit pentru eliminarea anunturilor enervante si intruzive
www.tion.ro - Timiş
Google a lansat un ad-blocker pentru browserul său web, Chrome, care este conceput pentru a împiedica afişarea anunţurilor „enervante” şi „intruzive”. Reprezentanţii companiei au anunţat că măsura de reducere a anunţurilor full-page şi cu redare automată încă de anul trecut.

OMUL SĂPTĂMÂNII
www.soridapress.ro - Călăraşi
Florin Rădulescu Director – Muzeul Municipal Călăraşi Pentru reuşita proiectului pe care l-a iniţiat, pentru transformarea Muzeului într-un organism viu, în folosul comunităţii, pentru proiectele interactive care atrag atât de

Tânăr din Alba Iulia bănuit de comiterea unui furt dintr-un magazin, prins în flagrant de poliţişti
ziarulunirea.ro - Alba
La data de 15 februarie a.c., ora 17.45, poliţiştii de ordine publică din cadrul Poliţiei Municipiului Alba Iulia au prins în flagrant şi au identificat un bărbat de 25 de ani, din Alba Iulia, ca persoană bănuită de comiterea unui furt dintr-un magazin din Alba Iulia. În 15.02.2017, ora 17.45, B.M. de 25 de ani, […]

Descinderi la suspecti de braconaj cinegetic care ar fi vanat, in mod ilegal, trei exemplare din specia urs brun
www.ziuaconstanta.ro - Constanţa
Politistii din Mures, cu sprijinul Directiei Operatiuni Speciale, au retinut 3 persoane care ar fi comis, in perioada septembrie 2017 - ianuarie 2018, mai multe infractiuni de braconaj cinegetic. ...

Punctul pe… NEPOȚII LUI… COCOȘILĂ!…
www.soridapress.ro - Călăraşi
Nu ştiu în ce măsură mulţi dintre cei care vor citi aceste rânduri îşi mai aduc aminte de personajul Cocoşilă, unul dintre cele mai remarcabile personaje ale romanului “Moromeţii” de

Teatrul Szigligeti anunţă o nouă ediţie a festivalului "Poimâine"
www.ebihoreanul.ro - Bihor
Între 20 - 25 martie 2018, Teatrul Szigligeti organizează a şasea ediţie a Festivalului 'HolnapUtán', adică 'Poimâine'. În cursul celor şase zile ale evenimentului, vor avea loc 14 spectacole prezentate de 12 trupe de teatru din ţară şi din Ungaria.

REACȚIA PREȘEDINTELUI VASILE ILIUȚĂ, LA ANCHETA “RMN-UL POLITIC”!…
www.soridapress.ro - Călăraşi
*La Spitalul Judeţean de Urgenţă din Călăraşi nu există preferinţe politice! *Aici toate partidele importante colaborează pentru binele călărăşenilor!… Foarte multe reacţii după apariţia semnalelor legate de ceea ce se

Poliţiştii au „deranjat” traficul de ţigări de contrabandă, în pieţele Sucevei
feeds.monitorulsv.ro - Suceava
Politistii de la Serviciul de Investigare a Criminalitatii Economice din cadrul Inspectoratului de Politie Judetean Suceava au efectuat in aceasta saptamana controale pe linie de comert ilicit si de contrabanda in pietele Sucevei, principala tinta fiind tigarile aduse din Ucraina si vandute clientilor, e drept cu mai multa perdea decat acum cativa ani.

Un autoturism s-a izbit violent într-un tir. Vehiculul greu a dispărut de la faţa locului
feeds.monitorulsv.ro - Suceava
Trei tineri au ajuns la spital joi dimineata, dupa ce autoturismul in care se aflau s-a izbit violent intr-un tir stationat pe carosabil. In urma impactului, soferul turc al tirului s-a speriat si a fugit de la locul accidentului, fara a da o mana de ajutor celor trei raniti. El a fost depistat de politisti o ora mai tarziu, in zona municipiului Falticeni. Accidentul a avut loc joi dimineata, in jurul orei 05.

„Concubinajul este o improvizaţie”, atrage atenţia părintele Teofil Părăian
feeds.monitorulsv.ro - Suceava
Duhovnicul tinerilor, asa cum a fost numit adesea parintele Teofil Paraian, este renumit pentru sfaturile sale referitoare la viata de familie. Toata lumea stie ca viata de familie trebuie binecuvantata de Dumnezeu, spunea parintele atragand atentia ca, de altfel, concubinajul este o improvizatie. Concubinajul nu este o marturisire de credinta, este o marturisire de necredinta.

Să ne rugăm ca Domnul să cruţe lumea celor păcătoşi pentru cei drepţi
feeds.monitorulsv.ro - Suceava
Fr. Stephen Freeman este preot la Biserica Sf. Ana din Oak Ridge, Tennessee. Este autor a numeroase carti si articole, precum si al unui post de radio ortodox din America. In materialul care urmeaza ofera o analiza a povestii distrugerii Sodomei si Gomorei, o talmacire non-istorica ce ofera o perspectiva a tainei lui Hristos si un pas pe calea mantuirii.

Iahnie de linte verde cu gogoşari
feeds.monitorulsv.ro - Suceava
Lintea verde este considerata mai putin atragatoare ca aspect, dar cunoscatorii stiu ca este deopotriva gustoasa, sanatoasa si satioasa, fiind un aliment ideal in post. Iahnia de linte verde se prepara repede si este mai gustoasa cu mamaliga calda.

O vulpe polară de la o grădină zoologică din Suceava a devenit vedetă în Constanţa
feeds.monitorulsv.ro - Suceava
Doua vulpi polare, duse la finele anului trecut la Constanta, de la o gradina zoologica din Suceava, au devenit vedete in orasul de la malul marii. In ianuarie, constantenii s-au intrecut sa le gaseasca un nume cat mai interesant celor doua frumoase exemplare - un mascul si o femela, care au devenit un cuplu, in ciuda incercarilor de a-i tine departe unul de celalalt.

Actorii Maia Morgenstern şi Marius Bodochi joacă săptămâna viitoare pe scena suceveană
feeds.monitorulsv.ro - Suceava
Mari actori ai scenei romanesti vor juca saptamana viitoare pe scena suceveana. Maia Morgenstern si Marius Bodochi se vor intalni cu publicul sucevean vineri, 23 februarie, de la ora 19:00, la Casa de Cultura a Sindicatelor Suceava. Ei aduc la Suceava spectacolul Elixir de Eric-Emmanuel Schmitt. Decorul spectacolului este realizat de Anca Cernea. Regia spectacolului este semnata de Marcel Top. Costume: Teodora Burz.

Două persoane au fost salvate de pompieri, după ce au alunecat cu maşina într-o râpă
feeds.monitorulsv.ro - Suceava
Doua persoane au fost salvate miercuri seara de pompieri, dupa ce au alunecat cu autoturismul intr-o rapa adanca de circa 6 metri, la marginea drumului. Accidentul s-a petrecut pe un drum comunal din satul Dragosa, al comunei Frumosu, in jurul orei 17.00.

Spitalul de Urgenţă Suceava are, de ieri, secţie de Îngrijiri paliative
feeds.monitorulsv.ro - Suceava
Spitalul de Urgenta Sfantul Ioan cel Nou din Suceava are, de ieri, o noua sectie, cea de Ingrijiri paliative, destinata pacientilor aflati in stadii terminale de boala.

Festivalul - concurs naţional de muzică corală religioasă ortodoxă ”Buna vestire”, ...
feeds.monitorulsv.ro - Suceava
Festivalul - concurs national de muzica corala religioasa ortodoxa Buna vestire, editia XXVIII-a, va avea loc duminica, 25 martie, de la ora 11:00, la Caminul Cultural Botus din comuna Fundu Moldovei.

Casa de Cultură a Studenţilor vrea să afle ce evenimente preferă spectatorii
feeds.monitorulsv.ro - Suceava
Casa de Cultura a Studentilor vrea sa afle care sunt gusturile studentilor Universitatii Stefan cel Mare, precum si cele ale publicului sucevean din afara campusului, in materie de spectacole concerte, teatru, film, actiuni culturale sau sportive etc.

Peste 5.000 de elevi suceveni, la concursul internaţional Mathématiques sans frontières
feeds.monitorulsv.ro - Suceava
Concursul international de matematica in limbi straine, aflat la cea de a XV-a editie in Romania si la a XXIX-a editie in lume, aliniaza la start in acest an peste 5.000 de elevi suceveni, competitia fiind programata pentru 15 si 16 februarie.

CSM Suceava încheie returul cu două meciuri în două zile
feeds.monitorulsv.ro - Suceava
Cu un moral mult mai bun dupa ce sambata au invins liderul Rapid Bucuresti, intr-un meci in fata propriilor suporteri, echipa de volei seniori a Clubului Sportiv Municipal Suceava va incheia in forta returul din seria de est din Divizia A2, cu doua meciuri in tot atatea zile. Astfel, astazi, de la ora 10.

Dorin Andrei Rusu speră la o medalie la Balcaniada de seniori din Turcia
feeds.monitorulsv.ro - Suceava
La sfarsitul acestei saptamani, mai exact sambata, in capitala Turciei, Istanbul, va avea loc Campionatul Balcanic de atletism pentru seniori. Din delegatia Romaniei face parte si atletul sucevean Dorin Andrei Rusu, de la CSM Dorna Vatra Dornei, care va fi insotit la aceasta competitie de antrenorul sau de la club, Cristian Prasneac.

Foresta cere FRF amânarea startului sezonului oficial de primăvară
feeds.monitorulsv.ro - Suceava
Oficialii Forestei au anuntat ca meciul amical cu Aerostar Bacau care ar fi trebuit sa aiba loc astazi pe terenul sintetic de la Liceul cu Program Sportiv a fost anulat din cauza caderilor de zapada, care au facut suprafata de joc impracticabila.

Dănuţ Perjă a fost cooptat în staff-ul grupării de Liga a III-a ACS Șirineasa
feeds.monitorulsv.ro - Suceava
La 11 luni distanta dupa ce a demisionat din functia de conducere pe care o detinea la Foresta, suceveanul Danut Perja a revenit in fotbal. Fostul fundas al Rapidului va activa ca director sportiv la gruparea ACS Sirineasa, liderul la zi al Seriei a IV-a a Ligii a III-a.

Universitatea a pierdut în ultima secundă disputa cu campioana României, Dinamo Bucureşti
feeds.monitorulsv.ro - Suceava
Aseara, in etapa cu numarul 19 din Liga Nationala, echipa de handbal a Universitatii Suceava a fost foare aproape de o remiza si chiar o victorie, in meciul disputat pe teren propriu in compania campioanei Romaniei, Dinamo Bucuresti.

”Trucul” lui Ronaldo
feeds.monitorulsv.ro - Suceava
Iata ca, desi arunci cu sutele de milioane pe transferuri, poti ramane tot la mentalitatea de echipa mica. Cel putin asa a decis pentru PSG antrenorul Unai Emery, atunci cand l-a inlocuit pe Cavani cu un fundas. Chiar daca acel fundas l-a dislocat pe Dani Alves, care a urcat la mijloc, tot mutare defensiva ramane.

Dorin Goian şi Daniel Bălan au pozat în scop caritabil pentru un calendar retro, realizat ...
feeds.monitorulsv.ro - Suceava
Stadionul Iuliu Bodola, din Oradea, va gazdui in ziua de sambata, 26 mai, cu incepere de la ora 17.00, Gala Uniti pentru Mihai Nesu. La actiunea organizata in onoarea fostului international roman, care a ramas paralizat in urma unui accident suferit in timpul unui antrenament si-au anuntat prezenta nume grele din fotbalul romanesc si international.

Au oferit două pilote drept ajutoare pentru a-i fura banii unui bătrân
feeds.monitorulsv.ro - Suceava
Un batran in varsta de 76 de ani din Campulung Moldovenesc a fost pacalit de doi tigani care s-au dat drept cetateni straini veniti in Romania chipurile pentru a oferi ajutoare. S-a intamplat miercuri la amiaza, dar din fericire totul a fost sesizat in timp util si hotii au fost depistati la Poiana Stampei in timp ce plecau spre localitatile de domiciliu, situate in judetul Mures.

Un minor de 16 ani, cercetat pentru furturi şi o tâlhărie, arestat pentru 30 de zile
feeds.monitorulsv.ro - Suceava
Un minor in varsta de doar 16 ani a fost arestat preventiv pentru 30 de zile de judecatorii de la Falticeni dupa ce a coordonat si comis un furt, desi era deja pus sub acuzare si pentru alte fapte de furt, dar si o talharie. Parchetul de pe langa Judecatoria Falticeni, care a formulat propunerea de arestare preventiva, a transmis ca in sarcina inculpatului Constantin Denis B.

Un copil a murit cu arsuri pe mai bine de jumătate din corp, după ce a căzut într-o oală ...
feeds.monitorulsv.ro - Suceava
Un copil care nu implinise inca varsta de 2 ani a murit in conditii groaznice, cu arsuri pe mai bine de jumatate de corp, dupa ce a cazut in oala cu ciorba clocotita pregatita de mama sa pentru hrana familiei. Nenorocirea s-a petrecut miercuri dupa-amiaza, intr-o familie de etnie roma din comuna Patrauti. Baietelul era singurul copil al familiei Ton si se afla in casa, unde se juca cu un verisor in varsta de 3 ani.

Lemn de 20.000 de lei, confiscat valoric de Garda Forestieră, la Moldoviţa
feeds.monitorulsv.ro - Suceava
Inspectorii Garzii Forestiere Suceava au facut miercuri o captura in valoare de 20.000 de lei, in urma unui control efectuat la un operator economic din Moldovita. Cu ocazia verificarilor efectuate in data de 14.02.

Pedepse micşorate în cazul contrabandiştilor de ţigări din gruparea „Ion Petrişor” - ...
feeds.monitorulsv.ro - Suceava
Unul din dosarele in care Paul Iova, zis Ion Petrisor, cunoscut mai mult sub denumirea de regele manelistilor, este judecat a ajuns ieri la final. Toti inculpatii din dosar au primit pedepse mult mai mici decat la instanta de fond, Tribunalul Suceava, existand chiar si o achitare. Daca la prima instanta Paul Iova a primit 7 ani de inchisoare, la Curtea de Apel Suceava pedeapsa a fost redusa la 1.479 de zile.

Trimis la închisoare după ce a comandat şi primit droguri în pachet
feeds.monitorulsv.ro - Suceava
Un tanar in varsta de 29 de ani din Siret a fost trimis la puscarie pentru o perioada de 2 ani si 8 luni. Mugurel Ioan Mihailiuc a fost gasit vinovat de instantele de judecata pentru mai multe infractiuni, respectiv ,,complicitate la infractiunea de introducere in tara de droguri de risc, fara drept, ,,trafic de droguri de risc si ,,prepararea sau detinerea de droguri de risc pentru consum propriu, fara drept.

Trei inculpaţi trimişi în judecată după agresiunea în care fiul fostului primar din Siret ...
feeds.monitorulsv.ro - Suceava
Procurorii Parchetului de pe langa Tribunalul Suceava au anuntat finalizarea cercetarilor intr-un caz de agresiune cu consecinte foarte grave, petrecut in vara anului trecut, in plin centrul Sucevei. Atunci, Alexandru Iulian Tablan, in varsta de 30 de ani, fiul fostului primar din Siret, Vasile Tablan, a incasat o lovitura si s-a lovit puternic cu capul de o suprafata dura de beton.

16 Februarie
feeds.monitorulsv.ro - Suceava
Parcelele de pe mosia Tataras Ainceput sa lucreze comisiunea pentru repartizarea parcelelor in arenda din mosia Tataras, urmand sa rezolve in sedinte consecutive peste 2.000 de cereri. Cu aceasta ocazie se pune capat protectionismului care a dainuit atata vreme in acest oras cu privire la posesiunea mosiei Tataras, donata de fostul domnitor al Moldovei Mihail Gh. Sturza. Suceava, Anul I, nr. 35, Februarie 1939.

Îngrijorare Program drastic de măsuri de prevenire a pestei porcine, care dă târcoale ...
feeds.monitorulsv.ro - Suceava
Directia Sanitar Veterinara si pentru Siguranta Alimentelor DSVSA Suceava a stabilit, impreuna cu reprezentanti ai altor institutii, sub coordonarea Prefecturii Suceava, un program de masuri de prevenire si combatere a pestei porcine africane, un virus extrem de violent, care a facut deja pagube mari in Ucraina si Republica Moldova.

Sindicatele din învăţământ trec în revistă probleme acute din sistem
feeds.monitorulsv.ro - Suceava
Sistemul de invatamant sta pe un butoi de pulbere, angajatii din domeniu amenintand cu greva generala din cauza problemelor care s-au acutizat in ultimii ani si care au condus la nemultumiri majore in randul salariatilor.

Aproape 5.000 de suceveni au apelat la instanţele de judecată pentru a-şi recupera taxa de ...
feeds.monitorulsv.ro - Suceava
Un numar foarte mare de suceveni, comparativ cu anii anteriori, s-a adresat instantelor de judecata in vederea recuperarii taxei de poluare. Potrivit unor date statistice ale Curtii de Apel Suceava, in cursul anului 2017 au optat pentru aceasta varianta 4.881 de persoane, ceea ce a facut ca activitatea Sectiei de Contencios Administrativ si Fiscal sa aiba o crestere cu 135.

Jurizare pentru Prix du Premier Roman, la Universitatea „Ștefan cel Mare”
feeds.monitorulsv.ro - Suceava
Universitatea Stefan cel Mare Suceava USV, in colaborare cu Institutul Francez din Iasi, a organizat, miercuri, 14 februarie, jurizarea romanelor franceze intrate in concurs pentru Prix du premier roman 2018. In aceasta activitate au fost implicate cadre didactice ale Facultatii de Litere si Stiinte ale Comunicarii, precum si doctori formati in domeniul Filologie la universitatea suceveana: prof. dr.

Deputatul PSD Maricela Cobuz dă asigurări că ministrul Sorina Pintea va continua proiectele ...
feeds.monitorulsv.ro - Suceava
Deputatul PSD de Suceava Maricela Cobuz a dat asigurari ca actualul ministru al Sanatatii, Sorina Pintea, va asigura continuitatea proiectelor importante din acest domeniu de activitate. Maricela Cobuz a amintit ca Sorina Pintea a declarat ca a preluat portofoliul Ministerului Sanatatii cu scopul de a continua proiectele pe care fostul ministru Florian Bodog le-a inceput.

Finanţări nerambursabile de 40.000 de euro prin Patronatul Judeţean al Femeilor de Afaceri ...
feeds.monitorulsv.ro - Suceava
Antreprenorii care doresc sa-si infiinteze o noua afacere au posibilitatea sa acceseze finantari nerambursabile in valoare de 40.000 de euro. Finantarile vor fi acordate prin proiectul Entrepreneurship for doers - Dezvoltare sustenabila in regiunea Nord - Est , a carui lansare va avea loc in data de 22 februarie a.c., la ora 14:00, la Muzeul Bucovinei din Suceava.

Deputatul Ioan Balan cere explicaţii de ce construcţia unui spital în România se face la ...
feeds.monitorulsv.ro - Suceava
Deputatul PNL de Suceava Ioan Balan se arata uimit de preturile cu care statul roman va construi 9 spitale. In opinia sa, sumele care vor fi achitate sunt exagerate, mai exact duble fata de o investitie similara dintr-un alt stat al Uniunii Europene. Din acest motiv, Ioan Balan a adresat mai multe intrebari ministrului Sanatatii, Sorina Pintea.

Mobilizare exemplară pentru deszăpezire, după codul galben de ninsori
feeds.monitorulsv.ro - Suceava
Stratul gros de zapada care s-a asternut in noaptea de miercuri spre joi, cand Suceava s-a aflat sub cod galben de ninsori, a dat batai de cap soferilor care au avut de munca sa o scoata de sub troiene, dar nu si pe principalele artere de circulatie, ba chiar si pe principale strazi din cartiere, care au fost curatate la negru, inainte sa inceapa vanzoleala de dimineata.

Centru de excelenţă în instruirea personalului medical, la Spitalul de Urgenţă Suceava
feeds.monitorulsv.ro - Suceava
Spitalul de Urgenta Sfantul Ioan cel Nou din Suceava va avea un centru de excelenta pentru pregatirea personalului medical. Presedintele Consiliului Judetean Suceava, Gheorghe Flutur, a declarat, ieri, in cadrul unei conferinte organizate la spital, ca centrul de instruire va fi realizat in cadrul unui proiect cu o valoare de 2,4 milioane de euro, cu finantare din fonduri europene.

La pas, prin Israelul cu prieteni
feeds.monitorulsv.ro - Suceava
Am vazut-o, la televizor, pe Tali Tamar Samash, ambasadoarea Statului Israel la Bucuresti. N-am mai vazut-o de ani. Nu era pe atunci Excelenta Sa, ci doar o prietena blanda, educata. O femeie minunata de care mi-e dor.

Tragedie in judetul Suceava. Un copil de aproape doi ani a murit dupa ce s-a oparit in oala cu ciorba
www.ziuaconstanta.ro - Constanţa
Un baietel de numai un an si zece luni, din localitatea Patrauti, judetul Suceava a murit in ambulanta, in timp ce era transportat spre Bucuresti. Potrivit obiectivdesuceava, micutul a cazut intr-o ...

Iar am avut dreptate! ALIANȚA CU PDL A AFECTAT, GRAV, PARTIDUL NAȚIONAL LIBERAL!
www.soridapress.ro - Călăraşi
*Ceea ce s-a întâmplat la Călăraşi se întâmplă şi la nivel naţional!… ÎN POLITICĂ, NICIODATĂ 1+ 1 NU FACE DOI! Aceasta este concluzia cunoscătorilor în ale politichiei, în România, iar

Cum va fi vremea la sfârşit de săptămână
www.zi-de-zi.ro - Mureş
Vă prezentăm, în rândurile de mai jos, prognoza meteo anunţată pe pagina web vremea.net pentru zilel

Bărbat din Cugir condamnat la închisoare pentru conducere sub influenţa alcoolului, identificat şi transportat la penitenciar
ziarulunirea.ro - Alba
La data de 15 februarie a.c., poliţiştii Compartimentului Investigaţii Criminale din cadrul Poliţiei oraşului Cugir au identificat şi reţinut pe un bărbat de 33 de ani din Cugir, posesor al unui mandat de executare a pedepsei închisorii, emis de Judecătoria Alba Iulia. M.I. a fost condamnat la executarea unei pedepse privative de libertate de 1 […]

ANUNȚ PUBLIC
www.soridapress.ro - Călăraşi
ROCAST SRL Unul din cei mai importanţi distribuitori din România, angajează pentru judeţul CĂLĂRAŞI – Agent de Vânzări – Organe de asamblare, unelte, scule şi masini unelte. Oferim salariu impozabil

„CÂRTIȚA” de la DNA Cluj, din nou în PRIM-PLAN. Fostul ȘEF de cabinet al lui IOAN RUS, trimis în judecată pentru CORUPȚIE
evz.ro - Bucureşti
Fostul ministru de Interne, Ioan Rus, a urmărit, probabil, cu foarte mare interes acuzaţiile care i se aduc fostului său şef de cabinet. Procurorii DNA......

Facebook îl CENZUREAZĂ pe OPOZANTUL lui Putin şi dă vina pe Kremlin
evz.ro - Bucureşti
Facebook susţine că, atunci când a blocat dezvăluirile lui Alexei Navalnîi despre legăturile Kremlinului cu oligarhii, s-a conformat legilor din Rusia. ...

AZA (GABRIELA AMZARU) – UN NOU SINGLE
www.soridapress.ro - Călăraşi
Tânăra artistă călărăşeancă lansează single-ul “Mai iubeşte-mă o dată”, piesă ce marchează a patra colaborare cu producătorul şi mentorul său, Adrian Sina. “Mai iubeşte-mă o dată” este o piesă de

Un nou top în care Clujul este lider european
www.stiridecluj.ro - Cluj
Un nou top în care Clujul este lider european

„TU EȘTI PRIMĂVARA MEA!”
www.soridapress.ro - Călăraşi
Nu-l aştept pe Moş Crăciun, în Laponia, pentru că abia a trecut, dar mă bucur de minunile albe ale înfriguratei Canade, unde sunt temperaturi foarte scăzute şi unde am descoperit

Liceul de Muzică ”Tudor Jarda” Bistriţa, după 20 de ani. ”Tinerele talente trebuie încurajate”
www.timponline.ro - Bistriţa-Năsăud
Liceul de Muzică ”Tudor Jarda” Bistriţa a celebrat 20 de ani de învăţământ liceal vocaţional de muzică printr-un concert omagial susţinut de elevii liceului la Centrul Cultural Dacia.
”Un concert deosebit de frumos susţinut de către talentaţii elevi ai Liceului de Muzică “Tudor Jarda” din Bistriţ

Un nou top în care Clujul este lider european
www.stiridecluj.ro - Cluj
Un nou top în care Clujul este lider european

Jurnalul de Călăraşi nr. 3065 din 16-18 februarie 2018
www.soridapress.ro - Călăraşi
descarcă Jurnalul de Călăraşi nr. 3065 din 16-18 februarie 2018 format PDF

Câteva trucuri şi funcţii ascunse ale telefonului tău Samsung J5
newsar.ro - Arad
Toate smartphone-urile au multe funcţii ascunse sau, cel puţin, dificil de reperat pentru neiniţiaţi. Deşi unora le place să le descopere singuri, cei mai mulţi sunt nerăbători şi preferă să caute lista acestor opţiuni pe internet! Probabil aşa ai ajuns şi tu la acest articol. Aşadar, iată câteva trucuri şi funcţii ascunse ale noului tău

Delegatia LMP la discutii cu conducerea Directiei Calitatea Vietii Personalului din MApN. Lista problemelor ridicate. Cine a participat
www.ziuaconstanta.ro - Constanţa
In urma cu doua zile o delegatie a Ligii Militarilor Profesionisti, condusa de presedintele Danut Albu, s-a intalnit la sediul Directiei Calitatea Vietii Personalului din Ministerul Apararii ...

Premierul Viorica Dancila isi cere public scuze dupa declaratia facuta intr-o emisiune TV si ar fi jignit persoanele cu autism
www.ziuaconstanta.ro - Constanţa
Premierul Viorica Dancila isi cere scuze public pentru declaratia facuta in cadrul unei emisiuni televizate si precizeaza ca prin comparatia facuta nu a dorit sa aduca jigniri persoanelor cu ...

Cadavrul scos din râul Mureş, la Cisteiu, a fost identificat! S-a deschis un dosar pentru ucidere din culpă
ziarulunirea.ro - Alba
La data de 14.02.2018, orele 17.00, Politia oraşului Ocna Mureş a fost sesizata de către un bărbat despre faptul că, în albia râului Mureş, in zona Cisteiu de Mureş, se afla cadavrul unei persoane. În urma investigaţiilor efectuate, la data de 15.02.2018, poliţiştii au stabilit identitatea persoanei, aceasta fiind M.D., o femeie de 56 de […]

În PREMIERĂ, prim-ministrul DĂNCILĂ îşi cere SCUZE
evz.ro - Bucureşti
Pentru prima dată de când s-a instalat la Palatul Victoria, premierul Viorica Dăncilă îşi cere scuze public pentru o declaraţia făcută în cadrul unei emisiu...

Îşi DĂ DEMISIA Mircea Badea, după 14 ani de Antena 3? Declaraţii ȘOCANTE: „Îmi AJUNGE! SUFICIENT. Vom vedea ce va urma”
evz.ro - Bucureşti
Mircea Badea se află la un punct de cotitură, după 14 ani petrecuţi la pupitrul emisiunii „În Gura Presei”. Prezentatorul se gândeşte să renunţe. ...

Ana Dragu sesizează CNCD, premierul Viorica Dăncilă îşi cere scuze public
www.timponline.ro - Bistriţa-Năsăud
Preşedintele Asociaţiei Autism Europa Bistriţa, Ana Dragu, critică într-o postare pe Facebook afirmaţia premierului Viorica Dăncilă, care i-a catalogat drept "autişti" pe cei care "dezinformează UE, în ciuda faptului că ştiu adevărul". Ana Dragu spune că postarea sa poate fi considerată o sesizare c

Amazon le oferă angajaţilor 5.000 de dolari pentru a demisiona
www.stiridecluj.ro - Cluj
Amazon le oferă angajaţilor 5.000 de dolari pentru a demisiona

O româncă A MURIT brusc, pe stradă, DEPARTE DE CASĂ. Ce i-a adus sfârşitul e şocant
newsar.ro - Arad
Citeşte azi ce scriu ziarele de mâine!

Gospodării inundate la Bărbuleşti
obiectiv.net - Ialomiţa
Pompierii Detaşamentului Urziceni au intervenit în cursul zilei de ieri pentru scoaterea apei din curţile a cinci gospodării din comuna... Vezi tot

La Timisoara este prezentat noul Ford EcoSport, o masina produsa de romani pentru intreaga Europa
www.tion.ro - Timiş
ADVERTORIAL. Cel mai nou model creat de cunoscuta uzină Ford de la Craiova, EcoSport este prezentat de Casa Auto Timişoara la Shopping City în acest sfârşit de săptămână. Noul SUV al americanilor aşteaptă să fie descoperit de fani oferindu-le peste 5.000 de elemente noi.

Gafă URIAȘĂ a premierului Dăncilă: Cei care dezinformează UE sunt autişti
www.stiridecluj.ro - Cluj
Premierul Viorica Dăncilă a făcut o nouă gafă uriaşă după ce a spus că europarlam...

Percheziţii ale poliţiştilor antifraudă: Peste 400 de haine şi încălţăminte contrafăcute, ridicate din casa unui tânăr orădean (FOTO)
www.ebihoreanul.ro - Bihor
Poliţiştii Serviciului de Investigare a Criminalităţii Economice au făcut, joi, percheziţii, în casa unui orădean de 25 de ani, unde au descoperit peste 400 de obiecte de îmbrăcăminte şi încălţăminte cu suspiciuni de contrafacere, fără documente legale de provenienţă. Hainele au fost confiscate, iar tânărul s-a ales cu dosar penal, pentru evaziune fiscală şio contrafacere

VACANȚĂ în CUBA: Năstase, la un pahar de rom cu bustul lui Hemingway
evz.ro - Bucureşti
VACANȚĂ în CUBA: Năstase, la un pahar de rom cu bustul lui Hemingway. Ex-premierul PSD a postat pe blog poze din Havana si se plange de netul cubanez...

Românii au bombardat-o cu MESAJE pe Wozniacki, după ce daneza a făcut-o trişoare pe Niculescu: „Ai un caracter de doi lei! Ruşine!”
evz.ro - Bucureşti
Deneza Caroline Wozniacki, numărul 1 mondial, s-a dat în spectacol, aseară, la Doha, în timpul partidei cu Niculescu. A făcut-o trişoare pe românca, deşi no...

UPDATE: Alerta la pompieri. O locuinta din Negru Voda, judetul Constanta a fost cuprinsa de flacari. O femeie, gasita decedata in casa
www.ziuaconstanta.ro - Constanţa
Pompierii din cadrul Inspectoratului pentru Situatii de Urgenta Dobrogea al Judetului Constanta au fost solicitati in aceasta dimineata sa intervina pentru stingerea unui incendiu ce a cuprins o ...

Centru de atletism şi stadion nou, la Târgu-Mureş
www.zi-de-zi.ro - Mureş
Anunţul a fost făcut vineri, 16 februarie, de Claudiu Maior, consilier personal al primarului munici

Drept la replica din partea Poliţiei Locale Alba Iulia referitor la articolul: ”Maşinile din Alba Iulia, ridicate discreţionar? Un autoturism parcat pe zebră, mare şi scump, rămas neatins. A fost sacrificat SMART-ul din faţa sa”
ziarulunirea.ro - Alba
Autoturismul marca Smart era parcat de peste 24 ore fără numere de înmatriculare, la aproximativ 4 m faţă de trecerea de pietoni, în dreptul marcajului linie continuă, obligând participanţii la trafic pe aceiaşi direcţie de mers să circule pe contrasens, încălcând astfel marcajul conţinuu. Poliţiştii Locali cu atribuţii în domeniul circulaţia pe drumurile publice au […]

Simona Halep joaca astazi in sferturile turneului de la Doha
www.ziuaconstanta.ro - Constanţa
A doua jucatoare de tenis a lumii, Simona Halep, sustine astazi meciul din sferturile turneului de la Doha. Constanteanca o intalneste pe americanca de 18 ani Catherine Cici Bellis, aflata pe locul ...

Cercetat penal pentru conducerea sub influenta bauturilor alcoolice
www.infobraila.ro - Brăila
Comentarii comentariu

PROIECT: Ajutorul social să poată fi cumulat cu veniturile ca zilier. Iniţiatori: Această formă de sprijin social nu este îndestulătoare din perspectiva necesităţilor materiale ale unei familii
ziarulunirea.ro - Alba
Un grup de parlamentari a iniţiat un proiect legislativ care prevede ca venitul minim garantat să poată fi cumulat din munca sezonieră şi ajutorul social, niciuna dintre acestea să nu o excludă pe cealaltă. În prezent, Legea nr. 416/2001 privind venitul minim garantat prevede ca persoanele care beneficiază de ajutor social să nu poată cumula […]

Huawei a devenit anul trecut al doilea brand de telefoane mobile la nivel mondial şi vrea detronarea Samsung până în 2020
ziarulunirea.ro - Alba
Huawei nu a ascuns niciodată îndrăzneţul obiectiv pe care şi l-a propus pe piaţa telefoanelor mobile. Chinezii vor, nici mai mult, nici mai puţin decât locul 1 în clasamentul mondial al vânzărilor până în 2020. Și se pare că sunt pe drumul cel bun. Anul trecut, Huawei a vândut 153 de milioane de telefoane, detronând […]

Alerta la pompieri. O locuinta din Negru Voda, judetul Constanta a fost cuprinsa de flacari. O persoana ar fi decedata in casa
www.ziuaconstanta.ro - Constanţa
Pompierii din cadrul Inspectoratului pentru Situatii de Urgenta Dobrogea al Judetului Constanta au fost solicitati in aceasta dimineata sa intervina pentru stingerea unui incendiu ce a cuprins o ...

Vesti proaste pentru laboratorul antidoping de la Bucuresti. A ramas fara acreditare
www.ziuaconstanta.ro - Constanţa
Agentia Mondiala Antidoping AMA WADA a anuntat, joi, pe site-ul sau oficial, suspendarea pe o perioada de sase luni a acreditarii laboratorului antidoping de la Bucuresti, informeaza Agerpres.ro. ...

Cercetati de politisti pentru tentativa la furt calificat
www.infobraila.ro - Brăila
Comentarii comentariu

Un barbat din comuna Galbenu a fost prins cu 33 kg de peste in portbagaj
www.infobraila.ro - Brăila
Comentarii comentariu

La Curtea de Apel, volum mai ridicat de activitate şi judecători cocoşiţi de dosare. În 2017
www.zi-de-zi.ro - Mureş
Curtea de Apel Tîrgu Mureş a avut în 2017 un volum de muncă mai mare decât în anul precedent, încărc

Orban: Nu poţi să faci un bâlci din această comisie de anchetă privind activităţilor şefului SPP
evz.ro - Bucureşti
Preşedintele PNL, Ludovic Orban, a precizat că în cazul înfiinţării Comisiei parlamentare de anchetă pentru verificarea activităţilor şefului SPP, Lucian Pa...

ROMÂNIA în centrul unui nou SCANDAL. Se PARE că doar ne FĂCEAM că facem ANTIDOPING
evz.ro - Bucureşti
Acreditarea laboratorului antidoping de la Bucureşti a fost suspendată pe o perioadă de şase luni de către Agenţia Mondială Antidoping (AMA/WADA).
...

„Scurtcircuit”, un film bazat pe întâmplări reale, ce prezintă povestea tulburătoare a unei tragedii
evz.ro - Bucureşti
Evenimentul zilei vă invită la avanpremiera filmului Scurtcircuit! Pelicula prezintă povestea tulburătoare a unei tragedii care a mistuit viaţa a şase bebel...

Copil CĂZUT în MUREŞ! Intervenţie a Inspectoratului pentru Situaţii de Urgenţă
newsar.ro - Arad
Citeşte azi ce scriu ziarele de mâine!

Caroline Wozniacki, asaltată de români pe internet, după ce a făcut-o pe Monica Niculescu trişoare
www.stiridecluj.ro - Cluj
Numărul 1 mondial WTA, Caroline Wozniacki, a fost luată cu asalt de internauţi, &ic...

BREAKING NEWS/ ACCIDENT în Arad! Intervin SMURD şi Ambulanţa Arad
newsar.ro - Arad
Citeşte azi ce scriu ziarele de mâine!

DESCOPERIREA de la NASA care schimbă TOTUL. Cercetătorii au estimat GREȘIT ce se va întâmpla cu un VORTEX URIAȘ
evz.ro - Bucureşti
Cercetătorii de la NASA au estimat greşit direcţia în care un Vortex uriaş de pe Neptun se va îndrepta. Ce au observat la ultima analiză ...

Bărbat găsit carbonizat în propria locuinţă, la Cluj-Napoca. Și-a uitat ţigara aprinsă FOTO
www.stiridecluj.ro - Cluj
Un incendiu, soldat cu moartea unui bărbat de 70 de ani, a avut loc la o baracă improviz...

Lansare de carte la Biblioteca Copiilor
www.zi-de-zi.ro - Mureş
Vineri, 16 februarie, începând cu ora 15.30, la Biblioteca Copiilor, va avea loc vernisajul expoziţi

VREMEA se SCHIMBĂ RADICAL în weekend! Anunţul SURPRINZĂTOR al METEOROLOGILOR
evz.ro - Bucureşti
ANM anunţă că în cea mai mare parte a ţării vremea va fi caracterizată de valori în jurul mediilor normale, exceptând regiunile sudice şi sud-vestice....

ÎN PLIN SCANDAL! Victor Ponata va da cu subsemnatul în faţa procurorilor de la DNA
evz.ro - Bucureşti
Fostul premier Victor Ponta a fost chemat, în această dimineaţă, la DNApentru a fi audiat în dosarul lui Liviu Dragnea....

Bărbat găsit carbonizat în propria locuinţă, la Cluj-Napoca. Și-a uitat ţigara aprinsă FOTO
www.stiridecluj.ro - Cluj
Un incendiu, soldat cu moartea unui bărbat de 70 de ani, a avut loc la o baracă improviz...

DUMINICĂ, 18 februarie: Lăsatul Secului de brânză pentru Postul Sfintelor Paşti. Ce nu ai voie să faci în această zi
ziarulunirea.ro - Alba
Duminică, 18 februarie 2018, credincioşii ortodocşi Lăsatul Secului pentru brânză. Este, de altfel, şi ultima duminică dinaintea Postului Paştelui 2018. I se mai spune şi Ziua Impăcării, căci bunii creştini cer iertare. Vecinii, rudele, cunoscuţii se vizitează şi îşi cer iertare unii de la alţii, că să intre curaţi în Post. Urarea care se face […]

Viţel din celebra rasă de carne Wagyu, conceput prin embriotransfer la Semtest BVN Mureş
www.zi-de-zi.ro - Mureş
Embriotransferul reprezintă biotehnologia de vârf în domeniul reproducţiei animalelor şi oferă posib

Mesajul lui Romeo Kulcsar pentru consilierii care i-au refuzat titlul de cetăţean de onoare
portalsm.ro - Satu Mare
Mesajul lui Romeo Kulcsar pentru consilierii care i-au refuzat titlul de cetăţean de onoare

Judetele Constanta si Tulcea sub cod galben de ceata densa. Cand expira avertizarea meteorologilor
www.ziuaconstanta.ro - Constanţa
Administratia Nationala de Meteorologie a emis in aceasta dimineata o avertizare now casting cod galben de ceata valabil in intervalul ora 9 30 pana la ora 12 30. Potrivit ANM, in judetele ...

Trei cetăţeni chinezi, doi administratori şi un manager al firmei Sen Fu SRL Zlatna, condamnaţi la închisoare cu suspendare pentru evaziune fiscală
ziarulunirea.ro - Alba
Trei cetăţeni chinezi, reprezentanţi ai unei societăţi comerciale din Zlatna cu obiect de activitate în domeniul prelucrării lemnului, au fost condamnaţi la Tribunalul Alba la pedepse cu închisoarea cu suspendare pentru infracţiuni economice. Liu Yachen, Liu Yan şi Sun Yang au fost trimişi în judecată în martie 2016, iar prima decizie în dosar a fost […]

ANUNȚUL făcut de meteorologi: Cum va fi VREMEA în WEEKEND
newsar.ro - Arad
Citeşte azi ce scriu ziarele de mâine!

RUSIA, pusă la ZID de SUA. ATACURILE care au PARALIZAT planeta vor primi un RĂSPUNS pe măsură. KREMLINUL, pregătit de CONSECINȚE?
evz.ro - Bucureşti
Casa Albă a ameninţat joi Rusia cu consecinţe internaţionale pentru atacul cibernetic global NotPetya care a fost cel mai distructiv şi costisitor din......

Șofer sub influenta bauturilor alcoolice depistat in trafic in judetul Constanta. Pe numele barbatului a fost intocmit dosar penal
www.ziuaconstanta.ro - Constanţa
Un sofer baut a fost depistat de politistii constanteni pe o strada din Cogealac. Potrivit IPJ Constanta, la data de 15 februarie a.c., politistii din cadrul Sectiei 5 Rurala Cogealac au ...

Părintele Constantin Necula, învăţături despre Iubire şi Unitate
www.zi-de-zi.ro - Mureş
Unul dintre cei mai populari şi apreciaţi teologi români, părintele Constantin Necula, a fost prezen

Liberalii vor capul lui Oprişan! Ei au cerut revocarea acestuia din fruntea Consiliului Judeţean
www.jurnaldevrancea.ro - Vrancea
Ședinţa ordinară a lunii februarie, care a avut loc joi, 15 februarie, a produs o adevărată surpriză. Consilierii PNL au vrut să introducă pe ordinea de zi un proiect prin care Marian Oprişan să fie revocat din funcţia de preşedinte al CJ Vrancea.

Păcătoşi pe Whatsapp: Elevii de la Liceul Emanuel, pedepsiţi pentru înjurături online
www.ebihoreanul.ro - Bihor
Elevii dintr-o clasă de-a VIII-a a Liceului Baptist Emanuel din Oradea nu mai dorm bine nopţile. Nu doar de stresul examenului de final de gimnaziu, ci pentru că dintr-o prostie adolescentină s-au ales cu mediile scăzute la purtare. Tinerii aveau un grup de Whatsapp prin care conversau vrute şi nevrute, dar în care au ajuns şi profesori, ocazie cu care aceştia au văzut cum adolescenţii fac mişto de ei, ba asemănându-i cu diferite 'emoticoane', ba scăpând câte o înjurătură la adresa lor.

Iata de ce intarzie salariile profesorilor
www.ziuaconstanta.ro - Constanţa
Intrucat este pentru a doua luna consecutiv cand salariile profesorilor au intarziat sa fie achitate, conform noilor reglementari, respectiv prin inspectoratele scolare si nu prin consiliile locale, ...

Sute de apeluri intr-o singura zi la 112 pentru a solicita interventia politistilor. Cate amenzi au fost aplicate
www.ziuaconstanta.ro - Constanţa
Ieri, politistii au intervenit la aproape 2.500 de evenimente, au constatat 776 de infractiuni si au aplicat aproape 8.500 de sanctiuni contraventionale, in valoare de peste 2.400.000 de lei. ...

Starea pârtiilor la Arieşeni şi Șureanu în perioada 16 – 22 februarie: Zăpadă multă, vreme rece, iar sezonul continuă în condiţii foarte bune
ziarulunirea.ro - Alba
Starea pârtiilor la Arieşeni şi Șureanu în perioada 16 – 22 februarie. La Șureanu, există multă, foarte multă zăpadă nou-nouţă pe toate cele 9 pârtii ale domeniului schiabil de la Șureanu, iar vremea rece care urmează este un semn şi mai clar că sezonul va continua în cele mai bune condiţii. la Arieşeni, iarna continuă […]

Protest al sindicatelor din CFR la 85 de ani de la Greva Ceferistilor din 1933. Ce nemultumiri au sindicalistii
www.ziuaconstanta.ro - Constanţa
Federatia Sindicatelor Transportatorilor Feroviari din Romania FSTFR impreuna cu Confederatia Sindicala Nationala MERIDIAN si federatiile sindicale feroviare FNFMCV, FNSIF, FNDF, FMLR, ELCATEL, FAF, ...

USR Mureş ia pulsul străzii
www.zi-de-zi.ro - Mureş
Ce este corupţia şi cum se manifestă ea în România? Suferim noi de cultul personalităţii sau suntem

„FABRICA” de MERCENARI a RUSIEI. CUM au ajuns locuitorii unui SAT să fie ARUNCAȚI în RĂZBOIUL din SIRIA
evz.ro - Bucureşti
Ultimul bombardament american din Siria a ucis şi mai mulţi mercenari din Rusia. Cel puţin şapte dintre soldaţii angajaţi de compania privată Wagner......

CAUZA MORȚII lui Carmen Borota, cosmeticiana din Carei. S-a spus că NU suferea de nicio BOALĂ, iar ADEVĂRUL este ALTUL
evz.ro - Bucureşti
Decesul subit al lui Carmen Alina Borota, cosmeticiana din Carei foarte populară în comunitatea unde trăia, a emoţionat pe toată lumea. ...

Pieton lovit pe trecerea de pietoni. E în comă
www.oradesibiu.ro - Sibiu
Accidentul a avut loc vineri dimineaţă în jurul orei 7.00 pe DN7H. Evenimetul rutier s-a petrecut în dreptul Romtrailer şi este vorba de o neacordare prioritate pentru pietoni. Un bărbat în vârstă de…

Sistem de control al modului în care se face curăţenia la SJU Bistriţa (VIDEO)
www.timponline.ro - Bistriţa-Năsăud
”La iniţiativa directorului de îngrijiri, Gabriela Remeş, Spitalul Judeţean de Urgenţă Bistriţa a achiziţionat un sistem de control al modului în care se efectuează curăţenia în unitate”, a anunţat managerul SJU Bistriţa, Gabriel Lazany.
El a precizat că ”sistemul este simplu şi eficient, verific

Un nou deces cauzat de gripă în Bihor: O femeie de 62 de ani, care fusese vaccinată!
www.ebihoreanul.ro - Bihor
Centrul Naţional de Supraveghere şi Control al Bolilor Transmisibile a confirmat un nou deces provocat de gripă în Bihor, fiind vorba despre o femeie de 62 de ani, din Sălacea. Victima se vaccinase antigripal la sfârşitul lunii decembrie.

Număr record de şahişti bistriţeni calificaţi în finala CN
www.timponline.ro - Bistriţa-Năsăud
La Cluj-Napoca a avut loc una dintre seriile semifinale ale Campionatului Naţional individual de şah seniori, ediţia 2018. Celelalte serii semifinale s-au desfăşurat la Bucureşti, Brăila, Iaşi şi Timişoara. Miza competiţiei a fost calificarea în finala naţională care va avea loc în luna mai în staţi

Disputa dintre Inspectoratul Şcolar Judeţean Mureş şi Direcţia Judeţeană de Tineret şi Sport Mureş, la episodul 2
www.zi-de-zi.ro - Mureş
Joi, 15 februarie, pe adresa de e-mail a redacţiei Zi de Zi au sosit două e-mailuri, expediate de co

Mai multe competitii sportive programate in week-end la Constanta. Jandarmii vor asigura masurile de ordine
www.ziuaconstanta.ro - Constanţa
Jandarmii constanteni vor fi prezenti in mijlocul comunitatii in acest sfarsit de saptamana pentru asigurarea ordinii publice la manifestari sportive. Potrivit IJJ Constanta, in acest sfarsit ...

E OFICIAL. Încă un oraş din România va avea metrou
evz.ro - Bucureşti
DOCUMENT OFICIAL. Încă un oraş din România va avea metrou...

Anunţ de la MCDONALDS despre Happy Meal
evz.ro - Bucureşti
McDonalds va elimina definitiv cheeseburgerii din meniurI...

Simone Inzaghi ATACĂ FCSB după VICTORIA de pe Arena Naţională: „NU merita să câştige jocul!”
evz.ro - Bucureşti
Antrenorul formaţiei Lazio Roma, Simone Inzaghi, a declarat după înfrîngerea suferită în faţa celor de la FCSB, cu scorul de 0-1, că
echipa lui Nicolae Dică...

OANA ROMAN a ajuns la PSIHIATRU. VEDETA are GRAVE PROBLEME care îi pun în PERICOL SĂNĂTATEA
evz.ro - Bucureşti
Oana Roman a ajuns pe mâinile unui psihiatru după ce s-a decis să încerce să lupte împotriva depresiei, o boală aproape incurabilă....

Piata auto din Romania a ”explodat” in ianuarie, crestere de 66,4%
ziarmm.ro - Maramureş
Inmatricularile de autoturisme noi in Europa au crescut de doua ori mai rapid in luna ianuarie 2018 decat pe ansamblul anului 2017, cel mai puternic ritm de crestere fiind inregistrat in Romania, a an

Elevii mureşeni se mobilizează împotriva noilor planuri-cadru
www.zi-de-zi.ro - Mureş
Elevii mureşeni, reprezentaţi de Consiliul Judeţean al Elevilor Mureş (CJE), nu sunt şi nici nu pot

Centru mobil de recoltare de sânge la Târnăveni
www.zi-de-zi.ro - Mureş
Centrul mobil de recoltare de sânge aparţinând Centrului Regional de Transfuzie Sanguină (CRTS) a aş

Sute de apeluri intr-o singrua zi la 112 pentru a solicita interventia politistilor. Cate amenzi au fost aplicate
www.ziuaconstanta.ro - Constanţa
Ieri, politistii au intervenit la aproape 2.500 de evenimente, au constatat 776 de infractiuni si au aplicat aproape 8.500 de sanctiuni contraventionale, in valoare de peste 2.400.000 de lei. ...

Bolojan o ţine pe-a lui: "Când au fost la guvernare, PSD şi UDMR au votat toate donaţiile de terenuri"
www.ebihoreanul.ro - Bihor
Proiectele de hotărâri privind donaţiile de terenuri făcute de orădenii care doresc să obţină autorizaţie de construire de la Primărie au declanşat discuţii prelungite, joi, în Consiliul Local. Primarul Ilie Bolojan a declarat că, atâta vreme cât rămâne pe funcţie, se va folosi de această măsură pentru a încuraja urbanizarea zonelor mai retrase şi le-a reamintit consilierilor opoziţiei că reprezentanţii PSD şi UDMR au votat toate donaţii când au fost la putere.

INCREDIBIL. Un ofiţer de POLIȚIE care BĂTEA PROSTITUATE a ajuns ȘEF
evz.ro - Bucureşti
Un ofiţer acuzat că bătea prostituate şi că a accesat ilegal informaţii cu caracter secret a revenit, în forţă, chiar în fotoliul de şef al Poliţiei Române....

Preşedintele Iohannis: Îmi amintesc ce a spus Doina Pană. Am luat aceste chestiuni de bune
www.timponline.ro - Bistriţa-Năsăud
Preşedintele României, Klaus Iohannis, a susţinut o conferinţă de presă la Palatul Cotroceni, în care a fost întrebat, printre altele: ”În decursul acestor ani aţi venit şi cu o Strategie Naţională de Apărare, în care aţi inclus problema defrişărilor. Tot la fel de bună este activitatea DNA în momen

FOTO. Șofer din Sebeş, rămas blocat după ce a luat-o pe scurtătură spre o pensiune din Poarta Raiului, Munţii Șureanu
ziarulunirea.ro - Alba
Aflat la volanul unei maşini puternice, A.A. ( 38 de ani) din Sebeş, a încercat să ajungă pe o scurtătură la o pensiune din Poarta Raiului, judeţul Alba. Decizia s-a dovedit a fi neinspirată deoarece, după câteva sute de metri, vehiculul a rămas imobilizat în stratul de zăpadă, care in acea zonă măsoară circa 80 […]

NUȚU CĂMĂTARU nu lasă nimic să îi oprească DRAGOSTEA. GESTUL lui i-a IMPRESIONAT pe toţi. „BRAZILIANCA”, fără cuvinte.
evz.ro - Bucureşti
Nici măcar închisoarea nu îl poate împiedica pe infamul interlop Nuţu Cămătaru să îi arate soţiei lui cât de mult o iubeşte. Claudia a primit zeci de......

TELENOVELA din clanul Cordunenilor, LĂMURITĂ de fratele cel mare cu declaraţii ACIDE: „Am pus lucrurile la punct”
evz.ro - Bucureşti
Costel Corduneanu, unul dintre cei mai temuţi interlopi din România, face lumină în scandalul amoros care a izbucnit în ultimele zile legate de Ramona....

Wozniacki a întrerupt meciul cu Monica Niculescu, după revenirea româncei - VIDEO
www.stiridecluj.ro - Cluj
Wozniacki a întrerupt meciul cu Monica Niculescu, după revenirea româncei - VIDEO

Brânza cu care ciobanii de pe Valea Şieului vor să cucerească Europa. Se vinde cu 20 de euro/kg
www.timponline.ro - Bistriţa-Năsăud
"Având păşuni ecologice cu o compoziţie floristică net superioară celor din Spania unde se produce o brânză asemănătoare, merită să o producem", spun iniţiatorii unui proiect care ar putea să îi îmbogăţească pe ciobanii de pe Valea Şieului. SC Silvania Internaţional Prod SRL în parteneriat cu Grup L

Fotbal: Victorie de prestigiu pentru FCSB, 1-0 cu Lazio Roma, in Europa League
ziarmm.ro - Maramureş
FCSB a invins puternica formatie italiana Lazio Roma cu scorul de 1-0 (1-0), joi seara, pe Arena Nationala din Bucuresti, in prima mansa a saisprezecimilor de finala ale Europa League la fotbal, infor

Romgaz a afisat un profit net in crestere cu 82,4%, in 2017
ziarmm.ro - Maramureş
Producatorul de gaze naturale Romgaz Medias a afisat un profit net in crestere cu 82,4% anul trecut, 2017 fiind cel mai bun an inregistrat de Romgaz de la listarea la Bursa de Valori Bucuresti si Lond

„Karaoke pentru căţei“ – Eveniment caritabil pentru câinii orfani
feedproxy.google.com - Braşov
Asociaţia Comperio Medela a creat un eveniment special prin care se doreşte schimbarea vieţilor sutelor de câini orfani din Făgăraş şi împrejurimi. Astfel, iubitorii de animale sunt aşteptaţi vineri şi sâmbătă la un eveniment caritabil intitulat „Karaoke pentru căţei“. „Karaoke pentru căţei“ va avea loc în satul Hurez, nr.55 B. Donaţia minimă este de 10

Gafa a premierului Viorica Dancila. Ce termen a folosit pentru a-i taxa pe cei care isi parasc tara in Parlamentul European. Reactii dure dupa discursul premierului
www.ziuaconstanta.ro - Constanţa
Reactie dura a Asociatiei Parintilor Copiilor cu Autism dupa ce premierul Viorica Dancila a folosit termenul de autist pentru a-i taxa pe cei care isi parasc tara in Parlamentul European, ...

ANI: Primarul Homorod, incompatibil!
feedproxy.google.com - Braşov
Agenţia Naţională de Integritate (ANI) a anuţat că primarul comunei Homorod, Marcel Pelei, este incompatibil. ANI susţine că primarul Pelei, în perioada 28 mai 2014 – 27 noiembrie 2015, a deţinut şi a exercitat simultan funcţia de primar şi calitatea de comerciant persoana fizică în cadrul PFA Pelei Marcel, încălcând astfel dispoziţiile art. 87, alin. (1),

Mara Mareş cere măsuri pentru sprijinirea producătorilor autohtoni
feedproxy.google.com - Braşov
„Deoarece noi consumăm mai mult bunuri din import, creşterea economică de 7% s-a dus în buzunarele altora. Guvernul trebuie să sprijine urgent producătorii de bunuri şi servicii autohtoni, pentru ca banii cheltuiţi de români să rămână în România!”, spune deputatul PNL Mara Mareş. Conform datelor INS, în primele 10 luni ale anului 2017 în România s-a

SUA: Parada militara ceruta de Trump ar costa pana la 30 milioane de dolari
ziarmm.ro - Maramureş
Parada militara ceruta de presedintele american Donald Trump ar putea costa pana la 30 de milioane de dolari, a indicat Mick Mulvaney, directorul de buget al Casei Albe, in cadrul unei audieri in Cong

TABLETA DE VINERI – Alexandra Mihaela IONICĂ – Viaţă fără limite, de Nick VUJICIC
www.gazetadambovitei.ro - Dâmboviţa
Vinerea e ziua lor, aici, la Gazeta Dâmboviţei… Sunt elevii mei de azi sau de ieri, sensibili, inteligenţi, preocupaţi de

Începe weekend-ul mega distracţiilor. Super petreceri şi evenimente organizate în Sibiu
www.oradesibiu.ro - Sibiu
Se anunţă un final de săptămână care cu siguranţă că nu are cum să vă ţină în case. Urmează cele mai tari petreceri în cele mai cool cluburi, piese de teatru ce nu trebuie ratate şi conferinţe ce…

Primul blindat romano-german va iesi pe poarta uzinei de la Moreni in anul 2020
ziarmm.ro - Maramureş
Primul blindat romano-german va iesi de pe linia de productie in anul 2020, la fabrica de la Moreni, acesta fiind produs de compania mixta Romanian Military Vehicle Systems (RMVS), in care Romarm - Fi

Patru tricouri ale vedetelor de la AS Roma şi mănuşile lui Benny Adegbuyi, licitate în cadrul campaniei “Împreună pentru Adrian Vinţan”!
ziarulunirea.ro - Alba
Implicarea sportivilor în campania “Împreună pentru Adrian Vinţan” continuă, iniţiativa de suflet a fostului jurnalist albaiulian Horică Udrea făcând posibilă licitarea pentru patru tricouri ale vedetelor echipei italiene AS Roma, dar şi pentru mănuşile pugilistului aiudean Benjamin Adegbuyi. Este vorba despre Bogdan Lobonţ, Alexandar Kolarov, Radja Nainggolan şi Edin Dzeko (implicată fiind Iulia Lobonţ), plus […]

Perchezitii la sediile unor firme si la domiciliile unor persoane banuite de evaziune fiscala. Prejudiciul se ridica la aproximativ 4 milioane de lei
www.ziuaconstanta.ro - Constanţa
Politistii din Olt efectueaza 5 perchezitii in judetele Olt si Dambovita, la sediile unor firme si la domiciliile unor persoane banuite ca ar fi cauzat un prejudiciu de aproape 4.000.000 de lei, prin ...

Modificari in cadrul societatii Geodez Construct. Gheorghe Albu, tatal prefectului judetului Constanta, a iesit din societate
www.ziuaconstanta.ro - Constanţa
In cadrul Adunarii Generale din 24 ianuarie 2018, asociatii societatii Geodez Construct SRL, Liliana Albu, participare 80 si Gheorghe Albu, participare 20 au decis in unanimitate modificarea actului ...

ANI: Primarul Homorod, incompatibil!
feedproxy.google.com - Braşov
Agenţia Naţională de Integritate (ANI) a anuţat că primarul comunei Homorod, Marcel Pelei, este incompatibil. ANI susţine că primarul Pelei, în perioada 28 mai 2014 – 27 noiembrie 2015, a deţinut şi a exercitat simultan funcţia de primar şi calitatea de comerciant persoana fizică în cadrul PFA Pelei Marcel, încălcând astfel dispoziţiile art. 87, alin. (1),

Cursuri GRATUITE de matematică, pentru bac şi facultate
evz.ro - Bucureşti
Universitatea Politehnica diun Timişoara meditează şi în acest an, gratuit, pe toţi elevii, potenţiali studenţi, la matematică, în vederea admiterii la facu...

"Spălătoria" de apă: Compania de Apă Oradea se pregăteşte să pună în funcţiune una dintre cele mai moderne staţii de epurare din Bihor
www.ebihoreanul.ro - Bihor
Compania de Apă Oradea se pregăteşte să pună în funcţiune una dintre cele mai moderne staţii de epurare din Bihor. Construită din fonduri europene printr-o investiţie de 14 milioane lei, cea de-a patra staţie de epurare din administrarea CAO va deservi echivalentul a 12.000 de locuitori din Beiuş şi din localităţile învecinate.

EXCLUSIV. Epilogul conflictului dintre Primăria Târgu-Mureş şi Grupul E.ON
www.zi-de-zi.ro - Mureş
Primarul municipiului Târgu-Mureş, Dorin Florea, a declarat presei, în urmă cu câteva zile, că a pri

Consiliul Local Baia Mare voteaza astazi bugetul pe anul 2018
ziarmm.ro - Maramureş
Consilierii locali baimareni se intalnesc astazi intr-o sedinta extraordinara pentru a vota mai multe proiecte de hotarare, printre care si cel privind bugetul general al municipiului pe anul 2018. Re

Sore vorbeşte despre cum s-a schimbat relaţia cu iubitul ei după ce au devenit părinţi
evz.ro - Bucureşti
După 15 ani, Sore şi-a pus din nou patinele de gheaţă în picioare pentru fi lmările clipului celei mai noi melodii, Dintr-o mie de femei. Piesa este scrisă ...

Elena Cârstea trăieşte în TEROARE în Florida! Ce eveniment a MARCAT-O atât de profund
evz.ro - Bucureşti
Un liceu din Florida, SUA, a fost luat sub asalt de un fost elev, miercuri, omorând cel puţin 17 persoane înainte de a fi reţinut de poliţie...

Fără farmacii favorizate! „Omul e liber să meargă oriunde”
expressdebanat.ro - Caraş-Severin
Lanţurile farmaceutice, tot mai numeroase, ar putea avea înţelegeri tacite cu medicii de familie care să îşi direcţioneze pacienţii spre anumite mărci de farmacii. Aceasta nu pare să fie însă o regulă valabilă şi în Caraş-Severin.

Cele două cauze majore pentru care a scăzut profitul Comelf Bistriţa
www.timponline.ro - Bistriţa-Năsăud
Într-un an în care guvernanţii s-au lăudat că economia a bubuit, profitul Comelf, una dintre cele mai mari fabrici din zona industrială a Bistriţei, a scăzut, se arată în raportul preliminar al companiei, dat publicităţii pentru Bursa de Valori Bucureşti.
Potrivit Comelf, în 2017, cifra de afacer

Ce societate va reabilita drumurile din Cobadin si Viisoara. Care este valoarea contractului (document)
www.ziuaconstanta.ro - Constanţa
Primaria comunei Cobadin a atribuit recent un contract de modernizare trama stradala in comuna Cobadin, localitatile Cobadin si Viisoara. Potrivit licitatiapublica.ro, valoarea estimata a ...

PLĂTIM 13.000 de OAMENI ca să REZOLVE 9 cazuri de DISCRIMINARE anual. „EXPERȚII în EGALITATE de ȘANSE” - RISIPĂ sau strategie ANTIȘOMAJ?
evz.ro - Bucureşti
Companiile şi instituţiile publice cu peste 50 de angajaţi urmează să aibă „experţi în egalitate de şanse”, potrivit unui proiect de lege adoptat de cabinet...

Poliţia Locală va avea secţii în fiecare cartier
feedproxy.google.com - Braşov
Începând din acest an, Poliţia Locală va avea câte un birou în fiecare cartier din oraş. Potrivit directorului Poliţiei Locale Braşov, Nicolae Aldea, în acest moment instituţia este în reorganizare, iar în acest an se vor înfiinţa secţii în fiecare cartier, pentru a asigura ordinea şi liniştea publică. În prezent funcţionează deja două astfe de

Finanţele lansează certificate Tezaur pentru populaţie la preţul de 1 leu, în martie
jurnaluldeilfov.ro - Ilfov
Ministerul Finanţelor Publice (MFP) intenţionează să lanseze, în martie, o emisiune de certificate Tezaur dedicată populaţiei, la preţul de un leu...

Teroare în Păltiniş! Drumul public, transformat în ogradă proprie! „De 2 ani suportăm ameninţări, injurii şi gesturi obscene”
expressdebanat.ro - Caraş-Severin
Au trecut doi ani de când proprietara unei case din comuna Păltiniş tot face reclamaţii peste reclamaţii şi doar cu hârtiile rămâne, fără niciun răspuns şi fără o decizie din partea Primăriei.

Grupul TeraPlast îşi propune pentru acest an o cifră de afaceri de peste 900 milioane de lei
www.timponline.ro - Bistriţa-Năsăud
Grupul TeraPlast, cel mai mare procesator de PVC din România şi unul dintre principalii producători de materiale pentru piaţa construcţiilor şi instalaţiilor, încheie anul 2017 cu o EBITDA de 41 milioane lei. EBITDA (Earnings Before Interest, Taxes, Depreciation and Amortization) înseamnă profitul î

TRAFIC îngreunat din cauza CODULUI GALBEN DE NINSORI
evz.ro - Bucureşti
Trafic se desfăşoară îngreunat pe anumite porţiuni de drum din cauza codului galben de ninsori care încă mai este valaib....

Iulian Staicu participă la Balcaniada de atletism pentru seniori
feedproxy.google.com - Braşov
Atletul Iulian Cristian Staicu, sportiv legitimat la Clubul Sportiv Țara Bârsei 2011 Braşov, face parte din lotul pe care Federaţia Română de Atletism (FRA) l-a trimis la Istanbul, la Campionatele Balcanice de Sală pentru Seniori. „Sperăm ca Iulian să confirme forma bună din acest început de an, să obţină un rezultat bun la Istanbul şi

Constanta. Șase nave sunt avizate pentru sosire in porturile maritime romanesti. Una este pentru descarcare/incarcare
www.ziuaconstanta.ro - Constanţa
Conform listei navelor avizate pentru sosire in data de 16 februarie 2018 in porturile maritime romanesti, publicate de portalul Compania Nationala Administratia Porturilor Maritime Constanta, sunt avizate ...

Iohannis: Nişte penali încearcă cu disperare să discrediteze DNA. Nu văd motive de revocare a şefei DNA!
www.oradesibiu.ro - Sibiu
Șeful statului a avut o primă poziţie legată de ceea ce se întâmplă în ultimele zile în jurul şi despre Direcţia Naţională Anticorupţie. Preşedintele Iohannis spune că totul nu este decât un teatru…

Insectarul cu nă(l)uci 16 februarie 2018
expressdebanat.ro - Caraş-Severin

Scrisoare deschisă adresată serviciilor de urgenţă: Vă mulţumesc pentru că existaţi
www.timponline.ro - Bistriţa-Năsăud
"Vreau să-mi exprim public mulţumirea la adresa unor oameni care îşi fac meseria cu profesionalism şi omenie", a transmis, printr-o scrisoare deschisă Dumitru Cruceru, recunoscător angajaţilor de la Serviciul Judeţean de Ambulanţă şi UPU de la Spitalul Judeţean de Urgenţă.
Iată întâmplarea care l

ROMÂNIA, lovită de un CUTREMUR
evz.ro - Bucureşti
România a fost lovită de un cutremur, ieri noaptea, în jurul ore 00:20. Seismul s-a produs în judeţul Vrancea şi a măsurat 2,4 grade pe scara Richter....

Kinderball şi concurs de vinuri, la Râşnov
feedproxy.google.com - Braşov
În acest weekend, în Râşnov, vor avea loc două evenimente de o deosebită importanţă locală: Kinderball şi Concursul Local de Vinuri „Cu vinul de acasă”, anunţă reprezentanţii primăriei. Kinderball va avea loc vineri, 16 Februarie, de la ora 17:00 la Complexul Panicel. Acest bal reprezintă o tradiţie a saşilor râşnoveni reluată în anul 2014 cu

VREMEA în ROMÂNIA. CODUL GALBEN se menţine până VINERI
evz.ro - Bucureşti
Vremea se va menţine închisă până la finalul săptămânii, iar duminică vor reîncepe ninsorile în toată ţara, în special în zonele de munte....

Maratonul Zăpezii, la Râşnov
feedproxy.google.com - Braşov
Pe 17 februarie va avea loc ediţia a VII-a a primului maraton clasic pe zăpadă din Europa, Maratonul Zăpezii Isostar – Râşnov 2018. Competiţia face parte din ciclul de maratoane istorice „Din dragoste pentru România şi istoria ei”, pe care maratoniştii le aleargă în fiecare an în locuri cu semnificaţie istorică din România, cu scopul

Un TIR încărcat cu tone de pet-uri cu suc, a ieşit în decor, între Vlădeni şi Codlea (Foto)
feedproxy.google.com - Braşov
Un TIR încărcat cu 24 de tone de pet-uri cu suc, a derapat joi dimineaţă pe DN1, între Vlădeni şi Codlea, şi s-a răsturnat în afara părţii carosabile. Autotrenul înmatriculat în Serbia a ieşit în afara părţii carosabile, după ce şoferul în vârstă de 34 de ani a pierdut controlul asupra direcţiei de mers, din

Fărşangul, carnavalul care sperie iarna, la Apaţa
feedproxy.google.com - Braşov
Tradiţionala sărbătoare Fărşang, care vesteşte sfârşitul iernii şi începerea postului Paştelui, sâmbătă, 17 februarie 2018, începând cu ora 13:00, la Apaţa. Fărşangul este un obicei tradiţional al comunităţii maghiare împrumutat de la saşii transilvăneni, originea sa regăsindu-se cu peste două secole în urmă. Este o sărbătoare a măştilor ce înfăţişează o altă realitate în care

Accident rutier: Un autoturism s-a izbit frontal cu un camion militar. Doua victime
www.ziuaconstanta.ro - Constanţa
Accident autoturism camion militar

Decizie crucială: SUA pregătesc soluţia pentru Coreea de Nord, dar şi medicamente anti-radiaţie. Pulsul planetei
evz.ro - Bucureşti
Audierile din cadrul Comisiei pentru Intelligence a Senatului SUA despre ameninţările globale au prilejuit dezbaterea situaţiei din Coreea de Sud. ...

Deratizarea Devei, şmecherii cu mulţi bani publici
glasul-hd.ro - Hunedoara
Pentru două contracte de deratizare, care s-au derulat pe parcursul a câte patru luni fiecare, fosta

Asociaţiile de proprietari din Arad sunt SCANDALIZATE! Ce prevăd CONTRACTELE de salubrizare cu RETIM
newsar.ro - Arad
Citeşte azi ce scriu ziarele de mâine!

Din greşeală în greşeală spre… încurcătura totală. Povestea blocului ANL îngheţat din Deva s-ar putea repeta şi la Hunedoara
glasul-hd.ro - Hunedoara
Agenţia Naţională pentru Locuinţe se pare că insistă pe respectarea unui proiect tehnic chiar dacă e

Debut cu dreptul la Bacalaureat. Majoritatea elevilor sunt „experimentaţi” la română
glasul-hd.ro - Hunedoara
Aproximativ 70 la sută dintre elevii de liceu care au susţinut prima probă orală de limba română din

Cine este Bianca Mîrcă? Un INTERVIU SINCER cu noua achiziţie a Crişului
newsar.ro - Arad
Crişul Chişineu-Criş a reuşit să facă o mulţime de achiziţii pentru sezonul 2017-2018. Printre nou-venitele în oraşul de pe Crişul Alb, se numară şi tânăra Bianca Mîrcă, pata de culoare a echipei. La cei 21 de ani, Bianca are o poveste de viaţă interesantă, o poveste care oricând ar putea fi preluată şi scrisă sub

Evaziunea fiscală (VI)
glasul-hd.ro - Hunedoara
„Nu este destul să fii bun. Trebuie să fii şi bun la ceva.” (T. Muşatescu) Prima metodă de evaziune

Prefectura pune presiune pe distribuitorul de energie electrică
glasul-hd.ro - Hunedoara
Reprezentanţi ai companiilor Enel şi E-Distribuţie Banat s-au aflat ieri la Deva pentru a discuta cu

„Cupa Straja” şi „Parâng Night Challenge”, în acest weekend
glasul-hd.ro - Hunedoara
Iubitorii sportului alb au ocazia să ia parte în acest final de săptămână la două evenimente în staţ

Misterioasa dispariţie a Bibliotecii „Corviniana”
glasul-hd.ro - Hunedoara
În anul 1458, la încoronarea lui Matei Corvin pe tronul Ungariei, unchiul său, Mihai Szilagy, a trim

Degustare de parizer de pui, în magazinele PRO HD
glasul-hd.ro - Hunedoara
Hunedorenii care au trecut ieri pragul magazinelor PRO HD din Deva, Simeria şi Orăştie au putut degu

PSRO + ALDE = LOVE. Consilierii locali la Deva ai partidului lui Geoană şi-au dat mâna cu cei ai partidului lui Tăriceanu
glasul-hd.ro - Hunedoara
Răzvan Mareş şi Mircea Moloţ au bătut palma pentru o colaborare la nivelul Consiliului Local Deva, d

Minerii îşi aleg liderii pentru următorii patru ani. Opt angajaţi ai diviziei miniere din CEH doresc să ocupe cele trei posturi importante din conducerea principalului sindicat
glasul-hd.ro - Hunedoara
Pe 21 februarie sunt programate alegeri pentru posturile de preşedinte, preşedinte executiv şi secre

Crucile din Sântuhalm
glasul-hd.ro - Hunedoara
În curtea bisericii cu hramul „Sfinţii Arhangheli Mihail şi Gavriil” din Sântuhalm (municipiul Deva)

Șapte programe de formare profesională pentru şomerii hunedoreni
glasul-hd.ro - Hunedoara
Șomerii şi persoanele în căutarea unui loc de muncă din judeţul Hunedoara se pot înscrie gratuit la

Tânăr cu spirit civic, felicitat de poliţişti. Bărbatul a găsit un portofel în benzinărie şi l-a predat autorităţilor
glasul-hd.ro - Hunedoara
Un tânăr din Deva a făcut un gest firesc, de normalitate, dar care în zilele noastre este greu de în

Ambele echipe devene joacă duminică în Cupa României la futsal
glasul-hd.ro - Hunedoara
Până să se reia şi campionatul Ligii întâi – pentru că Liga a doua este în plină desfăşurare – după

Derbyuri în primele ligi din Campionatul Realsport de Minifotbal Deva
glasul-hd.ro - Hunedoara
Cu doi lideri oarecum desprinşi de urmăritoarele lor imediate în Ligile A şi B, cu un pluton cât se

De pupat 16.02.2018
glasul-hd.ro - Hunedoara
Vladimir Brilinsky – administratorul Sarmizegetusei Regia, Pentru că a reuşit să demonteze minciunil

Sare-n ochi
glasul-hd.ro - Hunedoara
Kovesi a dus meciul la unşpe metri Până la urmă, a fost nevoie să iasă Laura Codruţa Kovesi să spună

De blamat 16.02.2018
glasul-hd.ro - Hunedoara
Ciprian Răchită – fost director tehnic al Primăriei Deva, Pentru că, în mod nejustificat, nu a pus î

Revista presei locale
www.ziuaconstanta.ro - Constanţa
Revista presei locale

Cutremur subcrustal, in aceasta noapte, in Vrancea. Ce magnitudine au inregistrat seismografele. Unde a fost epicentrul
www.ziuaconstanta.ro - Constanţa
Cutremur Vrancea, Cutremur Romania

A fost modificat sistemul de distinctii militare din Ministerul Apararii Nationale. Despre ce este vorba si cui se adreseaza actul normativ
www.ziuaconstanta.ro - Constanţa
Ordinul nr. 14 2018 pentru modificarea si completarea Ordinului ministrului apararii nationale nr. M.102 2012 privind sistemul de distinctii militare

Centrul Militar Judeţean Covasna, la ceas aniversar
mesageruldecovasna.ro - Covasna
Vrei să fii notificat când apare un articol nou? Abonează-te prin e-mail

Primarul municipiului Sfântu Gheorghe, Antal Árpád András: „Eu îmi doresc ca locuitorilor oraşului să le fie foarte clar care sunt atribuţiile autorităţilor locale”
mesageruldecovasna.ro - Covasna
Vrei să fii notificat când apare un articol nou? Abonează-te prin e-mail



















































































































































































































 www.infobraila.ro - Brăila
www.infobraila.ro - Brăila